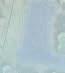

TOUR
367 NEW HOMES













TOUR
367 NEW HOMES















Lennar o ers self-guided tours where you can schedule a time to tour model homes at a time that works for you, whether it’s during your lunch break or after you drop the kids o . Book a self-guided tour online or simply stop by a community and nd your dream home.







Aim your camera app at the QR code & open link. 1 Follow the prompts to receive your veri cation code.
4
When you arrive at your model, open the link to receive your 4-number entry code.

2
5
On the front door’s keypad, push the “Yale” logo to activate, type the entry code into the keypad, and nish by pressing the check mark on the bottom left. Please make sure the door completely closes behind you when you enter and leave the home. Enjoy your tour!














Explore all 35 D.R. Horton Models to

your

NORTH Balsam Pointe, Dayton
Birchwood, Rogers
Cypress Cove, Dayton
Grass Lake Preserve, Rogers
Harpers Landing, Blaine
Harvest View, Rogers
Lexington Waters, Blaine
Northwater, Otsego
Oaks at Bauer Farm, Champlin
Prairie Pointe, Otsego
EAST
Copper Hills, Woodbury
Hinton Woods, Cottage Grove
SOUTH
Amberglen, Shakopee
Ardan Place, Rosemount









Bridle Creek, Jordan
Brookshire, Lakeville
Caramore Crossing, Rosemount
Crystal Park, Lakeville
Springview Meadows, Prior Lake
Whispering Fields, Farmington
WEST
Fields of Waconia, Waconia
Greywood, Delano
Oak Creek, Chaska
Rivertown Heights, Chaska


















































With mortgage rates constantly on the move, protect yourself from interest rate changes during the buildout of your new home. See how you could reserve a rate for up to 360 days1 , based on today’s rates. This extended rate lock option is available for new-build single family homes and condos.

CONNECT WITH US TODAY.
We look forward to sharing how U.S. Bank can help you work toward your goals, whatever they may be.
Cameron Perket
Mortgage Branch Manager Office: 651-552-7694
Cell: 612-396-1291

cameron.perket@usbank.com
NMLS # 1536030
Denise Patten
Mortgage Area Manager Office: 952-876-5045






Cell: 651-338-5422
denise.patten@usbank.com
NMLS # 179996
















For homes that deserve nothing less than extraordinary, choose Pella® products. From stunning modern profiles to traditional details and craftsmanship, Pella brings expansive views and beautiful inspiration to your home. Our windows and doors are exquisitely detailed and made-to-order just for you.

and Remodelers Showcase®:
Benzinger Homes Homes #131, 132, 142
Charles Cudd Co., LLC Home #6, 59, 63, 194
Creative Homes, Inc. Homes #103, 171, 175, 210, 223, 238, 269
Custom One Homes Home #50
DavidWeekley Homes Home #83
Hanson Builders, Inc. Homes #54, 56, 64, 90, 92, 93, 126, 189, 209, 218, 246
Michael Lee Homes Home #237
Pratt Homes Homes #193, 195, 197, 198
Stonegate Builders Homes #30, 57
Pella is proud to partner with the following quality homebuilders and remodelers featured in the 2023 Fall Parade of HomesSM pella.com
It’s easy to see why Pella is the most preferred window brand by homeowners in the Twin Cities.1MARK D. WILLIAMS CUSTOM HOMES | DAVID CHARLEZ DESIGN | TROY THEIS PHOTOGRAPHY
EDITORIAL & PRODUCTION
PUBLISHER JAMES VAGLE
EDITORIAL
EDITOR LAURA BURT
CONTRIBUTING WRITERS KATIE ELFSTROM, TAYLOR HUGO, SARAH HINDERMAN, SOFIA HUMPHRIES, RACHEL JAEGER
ART
ART DIRECTOR MANDY FINDERS
GRAPHIC DESIGNER EMILY DOHENY
HOME ENTRIES
DATABASE MANAGER/PROJECT COORDINATOR CASEY SCOZZARI

ADVERTISING
ADVERTISING SALES KORI MEEWES, BRAD MEEWES, and more by Kori
ADVERTISING & SPONSORSHIP FULFILLMENT LAURIE SPARTZ
HOUSING FIRST MINNESOTA BOARD OF DIRECTORS
BOARD CHAIR JOHN QUINLIVAN, Gordon James
BUILDER VICE PRESIDENT ART PRATT, Pratt Homes
TREASURER TIM FOHR, Lennar
IMMEDIATE PAST PRESIDENT JAMES JULKOWSKI, Julkowski, Inc.
ASSOCIATE VICE PRESIDENT DALE LOEFFLER, Marvin
SECRETARY PETER MARTIN, Pella Windows & Doors
PAST ASSOCIATE VICE PRESIDENT SUNNY BOWMAN, Dakota County Lumber Company
ADVOCACY COMMITTEE TONY WIENER, Cardinal Homebuilders, Inc.
AMBASSADOR COMMITTEE KRISTIN REINITZ, Admit One Home Systems
ARTISAN HOME TOUR COMMITTEE AMY HENDEL, Hendel Homes
LARGE VOLUME BUILDERS COMMITTEE JAMIE THARP, Pulte Homes of Minnesota, LLC
PARADE OF HOMES COMMITTEE SARAH DULONG, Ron Clark Construction
PAST PRESIDENTS' REPRESENTATIVE MEG JAEGER, Mega Remodel
REMODELERS COMMITTEE ANDY MICHELS, Michels Homes
SMALL VOLUME BUILDERS COMMITTEE KIRK VAN SLOOTEN, Denali Custom Homes

MEMBER AT-LARGE JOHN KRAEMER, John Kraemer & Sons, Inc.
MEMBER AT-LARGE KARYN BRADDOCK, Neighborly Property Group, LLC
PARADE OF HOMES SM COMMITTEE
CHAIR SARAH DULONG, Ron Clark Construction
ABDIRAHIM BUSURI, Comcast
DAVID FROSCH, Michael Lee Homes
KATIE GEDDES, M/I Homes
KEITH HORKEY, KEY LAND HOMES
MARIAH KOHLS, Pulte Homes of Minnesota, LLC
KRYSTLE NEHLS, Lennar
PAIGE RADFORD, Robert Thomas Homes, Inc.
BLAKE SWANSON, Swanson Homes
MIKE SWANSON, Brandl Anderson Homes, Inc.
NICHOLAS WALTON, US Bank Home Mortgage
MARK WILLIAMS, Mark D. Williams Custom Homes, Inc.
The 2023 Fall Parade of HomesSM Guidebook is an o cial publication of Housing First Minnesota, and is distributed free of charge at Holiday Stationstores and Kowalski's Markets. Housing First Minnesota makes every e ort to be accurate in the information provided. Neither the advertisers, nor Housing First Minnesota, will be responsible or liable for misinformation, misprints, typographical errors, etc., herein contained. No part of this publication may be reproduced without the written consent of Housing First Minnesota. Parade of HomesSM is a registered trade and service mark of Housing First Minnesota. All builders must be licensed by the State of Minnesota.
© Parade of Homes 2023 • ParadeofHomes.org
2960 Centre Pointe Drive, Roseville, MN 55113 651-697-1954 • HousingFirstMN.org







This fall, we are celebrating a major milestone: 75 years of inspiring homebuyers on the Parade of Homes. What began as a single “Trend Home” in 1948 is now the largest and most successful home tour in the United States. Twin Cities homebuilders were shocked at how popular the event was in the early 1950s as potential homebuyers lined up around the block to check out the latest features and trends in new homes. Much has changed for Minnesotans since the early days of the Parade of Homes, but the home tour continues to be an exceptionally popular event and resource for homebuyers looking to be inspired.
Join us in celebrating the legacy of the Parade of Homes! All throughout the tour, we are celebrating our 75th year through a series of fun events, giveaways, a signature brew, special community partnerships, and content. Follow
us on Instagram @paradeofhomestc to travel back in time and discover pieces of our history. Plus, each Saturday during the tour, we’re bringing the celebration to the Parade Homes find a local th anniversary pop-up celebration on the tour (page 34). Come for the free coffee and community yoga and stay for the kids’ activities, food trucks, music, and more!
Inside the pages of this guidebook, you ll find a historic loo bac on the Parade of Homes and how our home tour helped build the communities we live in today (page 36). Making selections for your new home can feel overwhelming, but for 75 years, the Parade of Homes has been inspiring homebuyers and helping them narrow down their choices. Dive into tips from design experts on everything from countertops (page 20) to wallcoverings (page 26). And be sure to check out our guide to picking the perfect neighborhood for your family (page 16).
Since 1996, the Parade of Homes has played a critical role in supporting the Housing First Minnesota Foundation in its mission to end homelessness in Minnesota. Our fall Dream Homes (page 58) are exceptional residences that collect an entry fee to support the Foundation. When you tour these homes that showcase exquisite craftsmanship and luxurious details, you are helping give families and veterans in need a chance at a new future.
Don’t miss out on any of the excitement as we celebrate 75 years! Subscribe to our monthly e newsletter where you ll find home resources and inspiration to help in your home search. We also invite you to connect with us on social media and share your favorite tour moments by tagging us and using #ParadeofHomesTC #POH75.
Happy Touring!
When you move with the X nity 10G Network, your new home is ready for anything. It’s reliable enough to power a house full of devices. So the whole family can watch, work, stream and play, all at once. Plus, quick and exible installation options make getting set up easier than ever. That’s one less thing to worry about during your move. Get your

home future-ready with the X nity 10G Network.


PHOTOGRAPHY BY ANTHOLOGIE
Moving to a new house — whether it’s just down the block, into a new neighborhood, or within a brand-new development — is a big change. Selecting the right neighborhood is an essential part of the process. Every homebuyer’s neighborhood preferences will look different, but it’s important to identify what factors ma e or brea a good fit for you

A top factor for most buyers is where a neighborhood is located in relation to work, school, or family. How close are you to the nearest major highway? Do you have good access to grocery or retail stores? What school district are you in? Do you want a neighborhood bustling with local coffee shops and restaurants?

“It’s where your life is,” says Jenna Sundstrom with Creative Homes. “So, it’s important to choose a spot you love and that makes you happy.” Each neighborhood has a unique personality — so try to find one that fits your lifestyle

Next, list out what type of environment you want to live in and what amenities are important to you. “Walking and biking trails, community parks, nearby lakes, and athletic courts — like pickleball or tennis — can be ma or benefits for acti e families, shares Sundstrom.
Whether you like to be hands-on or hands-off, research what’s common in the neighborhood in terms of property maintenance. Is there an HOA that manages shoveling, plowing, and lawn care? Are there community options for exterior home maintenance? Are there any aesthetic requirements for homes on the block?
here are plenty of benefits to building new or choosing a new development community. Since everything in your home is new, you can be confident about quality and warranties. ew homes are often outfitted with the latest and greatest finishes and products Plus, new construction homes have stricter standards for energy efficiency




























From serving as a surface for cooking and entertaining to acting as a makeshift desk or makeup vanity, your countertops are some of the most visible, hardest-working surfaces in your home. Here, Twin Cities design experts weigh in with their tips for selecting countertops that fit your style, lifestyle, and budget, and that will perform for years to come.

DO YOUR RESEARCH. Before narrowing in on a countertop vendor or material, do your due diligence. Ask questions like: What is the composition material? What are the slab sizes, and does that impact the size of the countertop? How will the seam look with veining? “Understand where you are ordering your product from, and if that supplier stands behind
its brand if issues occur,” says Joel Dehmer, vice president of sales for Granite-Tops.
Additionally, prepare for your meeting with your countertop vendor by gathering images that speak to your desired design aesthetic and color scheme for the space. “Explore Pinterest, where you can curate a collection of inspiring rooms that truly resonate with you and align with your vision,” says Summer Kath, executive vice president of design for Cambria. “By identifying the recurring elements and themes present in your pins, you can gradually unravel your preferred color palettes and styles.”
MAKE THE INVESTMENT. Making a budget is a crucial step in the process of building a new home, but “countertops are not a place to






skimp,” says Danielle Yegge, co-owner of Style & Structure. “Countertops make up enough of the eye-level visual plane of your home that you’re not going to regret spending more on something you can love for years to come.”
If you want to save money, consider splurging on an eye-catching island and going simpler for the perimeter countertops.


Countertops serve as a prominent centerpiece within your kitchen, so you should thin about how they will fit in your overall design. “Do you want your countertops to be the star of the show in the space?” asks Yegge. “There are many options when it comes to countertops, so a great place to start is considering whether you want the countertop to be a bold focal point or a subtle complement to the rest of the room.”
Kath says to think of your countertops like a work of art. “This standout feature should be something that captivates your heart and sparks a deep sense of admiration,” she says. “Once you’ve discovered this crown jewel, allow it to inspire and guide the overall design of your space. Every other element can then be thoughtfully crafted and harmonized around this cherished centerpiece, resulting in a truly remarkable and cohesive kitchen aesthetic.”
If a monochromatic ambiance is more your style, you can choose countertops with subtle tones that blend with your cabinetry, while still injecting personality through accessories. “By opting for understated countertop options, you provide a versatile canvas for future enhancements,” Kath adds. “Over time, you can effortlessly refresh your space by selectively re-accessorizing with cabinet pulls and light fi tures, ma ing subtle yet impactful changes that e ol e with your evolving style.”
Our team is driven to deliver for our customers and help solve today’s toughest challenges. We offer expert product advice as you shop our extensive selection of doors, windows, cabinets, lumber, roofing, and more for your next project.


VISIT OUR WEBSITE OR ONE OF OUR NEARBY LOCATIONS TODAY.

There are many countertop material options, but some of the most popular today include:
GRANITE: A natural stone harvested from quarries all over the world in a wide variety of colors. A lot of variation means the exact slab that ends up in your home is less predictable.

QUARTZ: Since it’s an engineered product, quartz is available in a huge variety of colors to complement any design style. It’s also non-porous and durable. “Quartz is king currently in terms of popularity,” says Yegge.
QUARTZITE: A naturally occurring metamorphic rock, quartzite is
quarried, sawed, and polished into durable countertop slabs, but color palettes are limited to whites and grays.
PORCELAIN: In the form of giant tiles, porcelain countertops are rising in popularity for their heat, stain, and UV light resistance.
CONCRETE: If you’re looking for “something custom and handmade, you should choose concrete countertops,” says Dian Mullis of Pro Concrete Countertops. “You can choose the exact style, design, and color you want. Plus, there is no waste with concrete, so it’s environmentally friendly.”
EVALUATE YOUR LIFESTYLE. Whether you love to cook and entertain or have young kids or
pets who are hard on surfaces, “it is most important to select a material that will fit your lifestyle, meaning function is top priority,” says Nancy Brown, interior designer for Hanson Builders. “Is the classic beauty of a natural product worth the extra care and maintenance it requires? Or is the ease and durability of a quartz material a better fit for your needs
SEEK THE ASSISTANCE OF EXPERTS. Design professionals have the knowledge to steer you in the direction of ideal-for-you countertops. “Professionals know how different costs stack up so they can help stay within a budget,” says Hollie Chase, marketing manager for Arrow Building Center. “They also have an extensive inventory network between suppliers.”















Get exceptional protection against the elements and lasting prefinished color with LP® SmartSide® ExpertFinish® Trim & Siding.
ADVANCED DURABILITY
• Features engineered wood strand technology and LP’s proprietary SmartGuard® process, which adds strength and provides resistance against termites and fungal decay
• Helps deliver superior protection against hail, wind, and moisture intrusion


• Backed by an industry-leading 5/15/50 year pro-rated limited warranty; see LPCorp.com for details

LASTINGCOLOR


• Arrives factory-finished with acrylic exterior paint


• Available in 16 ExpertFinish® colors and a variety of styles
To learn more, visit LPCorp.com/ExpertFinish


 BY RACHEL JAEGER
BY RACHEL JAEGER
Colors, patterns, textures — wallpaper has it all. The right wallpaper will embody your personal style, enhance a room, and tie your decor together. It can be the perfect addition to the design of your home. There are so many kinds – from vinyl to grasscloth, textured to smooth, and subtle patterns to complete murals. But how do you discover which one is the right fi t for you e e as ed e perts for their ad ice
f something is trending, it s often for a good reason simple first step is simply to do some research and follow builders and designers that your tastes align with to see what wallpapers could be a good fit Looking at houses with styles you like can show you which wallpaper coordinates with the furniture you re likely to choose for your space.































One popular trend is using wallpaper in unconventional places, like on bookcases or cabinets. Rebecca Cashmore of Rebecca Cashmore Interiors has noticed that many homeowners enjoy framing wallpaper as large-scale art. This application allows you to choose more complicated patterns and brighter colors than you would for an entire wall.


Each wallpaper design will impact your room differently. Take a step back and think about your goals for the room you are decorating. Do you want to brighten a room lacking windows? A bold design will liven up the room and help it appear lighter. Do you want to make a small room appear spacious? Softer, smaller patterns will enhance the intimate atmosphere and draw attention away from the walls. Knowing design tricks like these can be extremely impactful in the planning stage.
PIN A DOZEN PICTURES THAT SPEAK TO YOU. THEN, LOOK AT ALL OF THEM AT ONE TIME [AND ASK YOURSELF] WHAT IS THE COMMON DENOMINATOR?
— THERESA LAMB, DWELL AND GATHERTaking a step back also lets you look at the room as a whole. If you are having trouble deciding between two wallpapers, the furniture and ooring in the room may pair better with one wallpaper over the other. Jean Hau aas from Hirshfield s ad ises to “coordinate your wallpaper choice with furniture, accessories, and artwor to create a unified and harmonious design.”









Once you’ve established wallpaper goals, it’s time to pick a color palette and pattern.
“Have fun in areas where you don’t spend a lot of time daily,” says Cashmore. “Then tone it down for daily-use areas such as living rooms and dining rooms.”
This mix of thoughtfully placed patterns juxtaposed with simplicity will complement each other and add personality to your house.
When choosing a pattern, bring home samples and tape them to the walls. Leave them up for a while, and if there’s one that you never get tired of or that truly brings your joy when you pass by — that’s the one. Theresa Lamb from Dwell & Gather Interior Design suggests that one of the most important parts of choosing a wallpaper is finding one that spea s to you and mirrors your personality. Make your space your own.
WALLPAPER DOESN’T JUST NEED TO GO ON YOUR WALLS, A BIG TREND RIGHT NOW IS APPLYING WALLPAPER TO CEILINGS, BEHIND BOOKCASES, AND EVEN FRAMED AS ART!
— REBECCA CASHMORE, REBECCA CASHMORE INTERIORS

Not only is there a wide array of colors to choose from, but also textures that add visual interest.




Sleek, matte wallpaper is better for ornate spaces, such as a dining room or a living room. It draws attention away from the walls and complements elaborate furniture pieces. Smooth wallpaper is also best for dar er rooms, as it re ects light, bouncing it around the room.
Highly textured wallpaper adds depth to a room by creating a three-dimensional look. Similar to bold patterns, it adds personality and air to a room Textured paper is also a good option for often-used rooms, as it covers over bumps or cracks in the walls.

Whichever wallpaper you choose, it is a great way to make an old space new — or to make a new space oneof-a-kind. It’s easy to see why it has come back in style: it can be a simple way to add personality and style to a room. The application technology has improved, Lamb reminds us, and it can be far more durable than paint. Find a design that speaks to you and get started today!

















































It’s not every day you get to celebrate 75 years of home tours! The Parade of Homes invites you to join us for special anniversary events throughout the Twin Cities that celebrate our legacy and our communities. There is something to keep everyone entertained — adults and kids alike!
AUGUST 29 | 7 P.M. • SEPTEMBER 2 | 7 P.M. • CHS FIELD
Join us for America’s favorite pastime as the St. Paul Saints take on the Columbus Clippers. This fun, family-friendly atmosphere offers exciting baseball, classic stadium eats, between-inning entertainment, and even a few giveaways by the Parade of Homes. Purchase tickets at milb.com/st-paul.


SEPTEMBER 7 | 4-10 P.M. • BAUHAUS BREW LABS
Calling all 21+ beer lovers! In honor of 75 years, we’re launching a signature brew in partnership with Bauhaus Brew Labs. Come sip a pint of our collaboration brew, enjoy some food truck bites, and celebrate the incredible legacy of the Parade of Homes. Then, pick up a four-pack at Haskell’s Wine & Spirits or Top Ten Liquors.
Each Saturday during the tour, join us at a different development across the metro for pop-up celebrations. Wake up with coffee carts, community yoga, family activities, and puppy parties!

THANK YOU TO OUR 75TH ANNIVERSARY SPONSORS

2023 marks the 40th anniversary of Kowalski’s Markets! Our story began in 1983 when Jim and Mary Anne Kowalski opened the first Kowalski’s Market (under the banner Kowalski’s Red Owl) on St. Paul’s Grand Avenue. To this day we are just as commi ed to providing you the best of the best in local and sustainably sourced products, delicious quality foods, and creating a fun place to shop that our neighbors and employees are proud to call their own. Celebrate 40 years with us!

























This year marks the 75th anniversary of the Parade of Homes. In honor of the milestone event, look back at the Parade of Homes’ history — and learn how it continues to benefi t homebuilders, homebuyers, and the Twin Cities community today as the largest and longest-running home tour in the country.













 BY TAYLOR HUGO
BY TAYLOR HUGO
Ryan and Chad Hanson credit the Parade of Homes with sparking their initial interest in the construction industry. Attending the tour was an annual event for the brothers who grew up watching their dad craft woodworking projects — like a plywood fire engine bed — in their garage, the unfinished basement acting as a sanding and painting station around which Ryan and Chad rode their Big Wheel bikes.
So, when the Hansons later started their own homebuilding company, Sustainable 9 Design Build, and debuted their first Parade of Homes new build in 2014, it felt like a full-circle moment.



“Participating in the tour holds a special place in our hearts, evoking memories of our childhood as we toured the homes on the Parade of Homes,” says Chad. “Having explored countless homes o er the years, we finally had the chance to showcase our own creation — and we have been doing so with pride ever since.”
For those who grew up around the Twin Cities, Chad and Ryan’s experience is a familiar one. In the past 75 years since the Parade of Homes’ inception, hundreds of thousands of people have enjoyed the tour with their families, oc ing to the now-biannual, four- to fi e wee long e ent to gather inspiration and see firsthand the latest offerings from local builders.
In celebration of the milestone anniversary, look back at the Parade of Homes’ history — and learn how it continues to benefi t homebuilders, homebuyers, and the Twin Cities community today as the largest home tour in the country.



Prior to the Parade of Homes becoming a hallmark event, its predecessor, the Trend Home, marked the first home tour by the Minneapolis Builders Association. In 1948, six member builders — looking to showcase the best of what new construction had to offer — collaborated on a house in the Edina Highlands neighborhood, drawing a crowd that lined up around the block to get a glimpse inside.
Two years later, in 1950, the Minneapolis Builders Association launched a bigger, scattered-site tour featuring multiple homes from multiple builders. Throughout the next decade, the Parade of Homes continued to grow in popularity and size. The tour was a valuable shopping opportunity for G.I. soldiers returning home from war and ready to settle down with families in the suburbs. Curious potential homebuyers continued to show up for the tour in droves, and there was even a Parade of Homes parade, complete with a Queen of Homes royal court.

“The early success of the Parade of Homes helped build communities and shape the cities we call home,” says James Vagle, CEO of Housing First Minnesota, the industry association that presents the Parade of Homes. “The tour's timeless invitation to families and friends to be inspired by homes of all sizes and prices continues today.”
Noticing the success the Minneapolis Builders Association was experiencing across the river, the St. Paul Area Builders Association started its own Parade of Homes, and eventually joined forces with Minneapolis to launch a second yearly tour in the spring. “We found that doing the Parade of Homes at the same time made sense for promoting the event,” says Bob Hanson, who was an executive for the St. Paul Area Builders Association when it merged with the Minneapolis Builders Association in 1992, forming the Builders Association of the Twin Cities (BATC).
The association continued to offer two Parade of Homes tours per year: one in the fall and one in the spring.

















“The fall tour was always the big one with more expensive, custom spec homes builders wanted to present,” says Wendy Danks, the former director of marketing and communications for Housing First Minnesota. “Spring is the height of the new sales market. Families who are looking to change housing want to do it sometime around May or June when their kids get out of school and before they go back to school. So spring was really when big crowds would come out for the tour.”

At one point, there were roughly 1,300 homes presented in the spring tour and 800 in the fall. Then, the Great Recession hit. Single-family home building fell by 75%, and millions of people lost their homes to foreclosure.



The Parade of Homes had to pivot.
















Homeowners have an emotional and personal connection with their house, so the Parade of Homes














started showcasing those real stories. “In those days, our commercials for the Parade of Homes were kind of fun and silly,” says Danks. “When the crash hit, we reevaluated, and that’s when we started interviewing and showing real buyers.”
The association was no stranger to adapting to the needs of the market and homebuyers. As the internet gained momentum as a vehicle for homebuying around the turn of the century, a website for the Parade of Homes was designed to offer a digital tour guide, provide year-round resources and a search feature for builders and remodelers, and allow visitors to map their own personal tour route with an online tour planner.
Danks also recalls an online tool that enabled website viewers to change the wall colors and wood finishes of Parade Homes. “It was a turning point in how people buy houses,” she says. “These virtual tools helped



keep the Parade of Homes brand relevant during some tough times.”




Despite the challenges throughout its history, the Parade of Homes has always persevered. In the past 75 years, the tour has only been halted once: spring 2020, at the start of COVID. Even then, Housing First Minnesota and participating builders got savvy and launched a virtual tour in May of that year, which has since become an option for builders every tour.
Danks credits the Parade of Homes’ longevity and success to the transparency of the builders in the pricing of their tour homes. “When you come to the Parade of Homes, you see what it costs; you see the finishes that you ll get, she says f granite is really important to you and you go into a house that has granite, the price they’re quoting you is the actual price. I think, from a marketing standpoint, that really helped us solidify the brand.”


Today, more than 200,000 people attend the tour to see the 350-plus homes presented during each event, making it the largest Parade of Homes in the country.
There have been small tweaks over the decades: In 1996, the Foundation Dream Home program began, collecting entry fees at a handful of exclusive, high-end homes in an effort for the Builders Outreach Foundation (today called the Housing First Minnesota Foundation) to raise money to build and remodel homes for families in need.






The Remodelers Showcase was launched in 1984, highlighting remodeled housing projects, and then folded into the Parade of Homes event in 2000. “It’s a great opportunity for a person looking to remodel to go out and see what a remodeler can do with a house,” says Hanson.



Then, in 2011, the Green Path Energy Tour became a special section of the Parade of Homes tour to educate homebuyers on energy efficiency in new homes. Finally, the Artisan Home Tour — a ticketed tour of new and remodeled luxury homes — was created as an extension of the brand in 2014.
BATC later became Housing First innesota in 9, re ecting the association’s advocacy work and mission to provide homeownership opportunities to all Minnesotans. The Parade of Homes is one way the association meets that goal. “The bottom line the tour has operated on is that everybody needs to have a roof over their head,” says Danks. e want to help you find what will work best for you and show you the reality of what it costs to have a new house.”





















Through it all, the Parade of Homes’ purpose to showcase the work of local builders and remodelers and connect buyers with housing options hasn’t changed.
Beyond the personal significance, these tours serve as a remarkable platform for builders to establish their presence, exhibit their craftsmanship, and generate valuable leads — not to mention the ability to elevate one’s brand awareness and forge new connections that can propel their business forward,” says Ryan of Sustainable 9 Design Build, whose 2016 Dream Home at 50th and France in Edina drew a record-breaking number of visitors with its lower-level wet bar, luxury primary bath, and iconic fire pole that connects the
second oor to a wal way ad acent to the state-of-the-art kitchen.






For Pratt Homes — which, in 1992, was awarded builder license #000001 in Minnesota after lobbying for statewide home construction standards — the Parade of Homes has become an essential tool for promoting their custom new builds and development communities.






Founded in 1973 by brothers Len and Lowell Pratt, Pratt Homes is also celebrating a milestone anniversary this year — the golden 50th — and nearly as many Parade of Homes houses, as they haven’t missed a single tour since their first entry in the late 1970s.




“After all these years, we’ve learned that customers come expecting to see some new ideas,” says Len, president of Pratt Homes, which



will present four homes on the fall tour this year. “They can come in and see it, touch it, look at it, talk about how we assemble the homes. That really made a difference for us as we grew our business.”


The Parade of Homes has also made a difference for the hundreds of homeowners who’ve found their home — or their builder or remodeler — because of the tour. “When consumers come to the Parade of Homes, there’s somewhere between 20-30% that are actually thinking about buying a new home,” says Danks. “Some of them have plans to build in three, four, or eight years, but the rest of them are looking for remodeling ideas, things to decorate with, and paint colors.”



The importance of cultivating that long-term relationship with tourgoers is why Len insists that Pratt Homes participates in the tour every year. “Some people will come look at our models, even though they’re not at a place in life where they’re ready to buy a home from us,” he says. “But 20 years later, their position in life may have changed, and because they’ve followed us all these years on the Parade of Homes, they’ll choose us to buy from. They trust us.”
From 1948 to 2023, that is what the Parade of Homes has always been about.





































This fall, you’re invited to join us at several community events throughout the Twin Cities metro before and during the tour to celebrate the milestone anniversary. Events will include a brewery bash and community pop-ups on the tour. These events will serve as a testament to the Parade of Homes’ commitment to celebrating homeownership for all Minnesotans. Learn more at ParadeofHomes.org









Get a glimpse into the award-winning homes featured on the 2023 Spring Parade of Homes. Each tour, Housing First Minnesota presents the prestigious Reggie AwardsSM to homes that showcase exceptional design and construction. In the latest tour, 20 homes claimed a coveted Reggie Award, while the Trillium Awards recognized the invaluable contributions of associates and trade partners in bringing these remarkable homes to life a e a pee at these fine homes

1 $300,000 TO $399,999 BUILDS 50+ HOMES/YEAR
CAMBRIDGE
Trillium Partner: Schwieters Companies, Inc.
2 $450,000 TO $499,999 BUILDS 1-49 HOMES/YEAR

ANDOVER
Trillium Partner: Warners’ Stellian Appliance


3 $450,000 TO $499,999 BUILDS 50+ HOMES/YEAR
RAMSEY
Trillium Partner: Schwieters Companies, Inc.
4 $500,000 TO $549,999 BUILDS 50+ HOMES/YEAR
LAKEVILLE
Trillium Partner: Martha O’Hara Interiors
5 $550,000 TO $599,999 BUILDS 1-49 HOMES/YEAR


ORONO
Trillium Partners: Schwieters Companies, Inc; Warners’ Stellian Appliance
6 $550,000 TO $599,999 BUILDS 50+ HOMES/YEAR
CHASKA
Trillium Partner: C&J Stoneworks, Inc.
7 $600,000 TO $699,999 BUILDS 1-49 HOMES/YEAR
STILLWATER
Trillium Partner: C&J Stoneworks, Inc.
8 $600,000 TO $699,999 BUILDS 50+ HOMES/YEAR
BIG LAKE
Trillium Partners: FocalPoint Flooring, Cabinets & Design; Schwieters Companies, Inc; Warners’ Stellian Appliance











9 $700,000 TO $799,999 BUILDS 50+ HOMES/YEAR
KEY LAND HOMES
LAKEVILLE
10 $800,000 TO $899,999 BUILDS 1-49 HOMES/YEAR
EDEN PRAIRIE
Trillium Partner: Ferguson Enterprises
11 $800,000 TO $899,999 BUILDS 50+ HOMES/YEAR
LAKE ELMO
Trillium Partners: Andersen Windows; C&J Stoneworks, Inc; David Charlez Designs


12 $900,000 TO $999,999 BUILDS 1-49 HOMES/YEAR
BLAINE
Trillium Partner: Warners’ Stellian Appliance
13 $900,000 TO $999,999 BUILDS 50+ HOMES/YEAR

MAPLE GROVE
Trillium Partners: C&J Stoneworks, Inc; Home Media Innovations, Inc; Lampert Lumber; Pella Windows & Doors
14 $1 MILLION UP TO $1.2 MILLION BUILDS 1-49 HOMES/YEAR
SOMERSET, WI
Trillium Partners: Arrow Building Center; Ferguson Enterprises
15 $1 MILLION UP TO $1.2 MILLION BUILDS 50+ HOMES/YEAR
PLYMOUTH
Trillium Partners: MCI Paint & Drywall; Pella Windows & Doors; Scandia Custom Cabinets

16 $1.2 MILLION UP TO $1.5 MILLION BUILDS 50+ HOMES/YEAR
MAPLE GROVE
Trillium Partners: Andersen Windows; MCI Paint & Drywall; Scandia Custom Cabinets
17 $1.5 MILLION UP TO $2 MILLION BUILDS 1-49 HOMES/YEAR

LAKE ELMO
Trillium Partners: Andersen Windows; C&J Stoneworks, Inc.; Home Media Innovations, Inc; Lampert Lumber; Schwieters Companies, Inc.
18 $1.5 MILLION UP TO $2 MILLION BUILDS 50+ HOMES/YEAR
MEDINA
Trillium Partners: Ferguson Enterprises; LDM Electric; Pella Windows & Doors; Schwieters Companies, Inc.
19 $2 MILLION AND ABOVE BUILDS 1-49 HOMES/YEAR
PLYMOUTH
Trillium Partners: Andersen Windows; Ferguson Enterprises; Visual Comfort & Co

20 $2 MILLION AND ABOVE BUILDS 50+ HOMES/YEAR
PLYMOUTH
Trillium Partners: Ferguson Enterprises; LDM Electric; Pella Windows & Doors; Schwieters Companies, Inc.






LEADING THE WAY IN ENERGY-EFFICIENT HOMEBUILDING






















In today’s competitive housing market, energy e ciency has emerged as a major consideration for homebuyers seeking a new residence. Recognizing the significance of this trend, builders in Minnesota are adopting innovative approaches to showcase their homes’ energy performance, ensuring transparency and accessibility to potential buyers.
The Home Energy Rating System (HERS) Index Score provides a comprehensive assessment of a home’s energy e ciency. The lower a home’s HERS Score, the better its energy e ciency. In Minnesota, the average HERS number for newly constructed houses stands









impressively low at 50, compared to a typical resale home’s average of 130.
In 2022, of states that had a HERS Score of 50 or lower, Minnesota ranked first for the number of homes energy tested.
When visiting homes in the Parade of Homes, ask to see the home’s Home Performance Report (HPR)


An HPR confirms the home has been inspected and energy tested by a certified Residential Energy Service Network (RESNET) energy rater and shows how energy-e cient it is in an easy-to-understand format. With today’s residential building codes, a newly built home in Minnesota is more efficient than ever. New homes in the Parade of Homes will save you energy dollars over virtually all older homes.

Look for the Green Path logo on home listings. These homes have been energy tested by an independent, third-party rater. For the most updated listings, please visit ParadeofHomes.org.
The following builders have met the qualifications to be a Designated Green Path Builder, including a commitment to energy test a minimum of 75% of their new single-family homes and to attend annual training on green building. These builders are considered industry leaders in energy-e cient residential home construction. We invite you to reach out to them to learn more.
Amba Property Development, LLC
Berger Built Construction Co., Inc.
Brandl Anderson Homes, Inc.
Charles Cudd Co., LLC



Christian Builders & Remodelers




City Homes, LLC
CityLine Homes, Inc.
Country Joe Homes
Cuddigan Custom Builders, LLC
Custom One Homes
D.R. Horton, Inc. - Minnesota
David Weekley Homes
Dingman Custom Homes
Donnay Homes, Inc.
Fieldstone Family Homes, Inc.
Fitzke Custom Homes
Gonyea Custom Homes


Gordon James
Gorham Custom Homes, LLC
Hagstrom Builder, Inc.
Hanson Builders, Inc.
Hendel Homes
While visiting homes on the Fall Parade of Homes, look for homes with the Designated

JP Brooks Builders
Julkowski, Inc.
KEY LAND HOMES
Kootenia Homes

Lang Builders, Inc.
LDK Builders, Inc.
Lennar

Mark D. Williams Custom Homes, Inc.
McDonald Design | Build | Renovate

Michael Lee Homes
NIH Homes, LLC
OneTenTen Homes, LLC
Ovation Homes, LLC
Paltrin, LLC















Parent Builders, Inc.
Pulte Homes of Minnesota, LLC
Radiant Design Build
Robert Thomas Homes, Inc.
Ron Clark Construction
RT Urban Homes, Inc.
S W Wold Construction, Inc.
Stonegate Builders
Style & Structure
Sustainable 9 Design Build
TC Homes, Inc.
TJB Homes, Inc.
Zawadski Homes, Inc.
Ziegler Custom Homes, Inc.




Illuminate the space with soft, warm lighting to create a cozy ambiance. Select lamps and statement light fixtures that accentuate the beauty of your bedroom, like these wall-mounted lights from Design Within Reach.
Bedrooms set the tone as you begin and end each day. Regardless of whether you seek a light and bright haven to unwind after a hectic day or desire a dark and dreamy escape to cozy up inside, creating a luxurious bedroom is an expression of self-love and -care that everyone deserves.

Thoughtfully selecting plush textures, sophisticated accents, and elegant furnishings will transform your bedroom from ordinary to extraordinary. Get inspired to reimagine your bedroom with the home stores at Galleria — because creating the space you’ve always dreamed of is easier than you think!

Find solace in the pages of your favorite books, nestled within the comfort of a charming reading nook. In this example, coziness is key with the plush swivel chair by Crate & Barrel.
Elevate your clothing organization with a chic and functional dresser. This option from Rejuvenation offers optimal storage so every item has a home.

Anchor your space in style with a textured rug underfoot. Weaving together colors, patterns, and accents from the room, a rug is the perfect place to go bold! This selection by Interior Define is the perfect mix of muted neutrals and a subtle pattern.
Experience the embrace of luxury every night wrapped in soft and lavish bed linens. A quality and eye-catching comforter, duvet, or throw blanket is the center of every bedroom design. We love this cloud-like mauve set from Parachute.

Start designing your dream bedroom at Galleria Edina! Explore an array of furniture and home decor stores that offer inspiration, style, and endless possibilities all under one roof. Visit galleriaedina.com to view the full collection of stores.

 PHOTOS BY NORDY PHOTOGRAPHY
PHOTOS BY NORDY PHOTOGRAPHY
The Housing First Minnesota Foundation is the charitable arm of Housing First Minnesota. Our vision is to end homelessness in Minnesota. Our mission is to partner to build safe housing for Minnesotans in need. Everyone deserves a safe space to call home.

In every project we undertake, we do so with wonderful partners by our side he first partner is a service provider, who serves our clients directly through support and wraparound services. The second is a build partner – this is the builder or remodeler who provides access to and donates materials and labor at a significantly reduced cost. These partnerships allow our Foundation to do so much more than if we were taking on these projects alone.


This year, we have two major build projects, both providing transitional housing to those in need. Our first project is a partnership with service provider Avivo and builder Nor-Son Custom Builders. The Avivo project benefits mothers who are going through addiction counseling and treatment. By the end of 2023, we will have completed renovations for the 100-year-old apartment building in Minneapolis. After the renovation is complete, a mother and her children will move in and live there for approximately one year while the mother completes her treatment program. Once these final four units are complete, the entire 10-unit building will have been completely remodeled by the Foundation and our build partners!

Our second project is in partnership with the Minnesota Assistance Council for Veterans (MACV) and build partner Lennar. Our goal is that the words “homeless” and “veteran” are never seen together. In 2023, we will complete our 11th Housing for Heroes home with an accessory dwelling unit (ADU). Each home provides transitional housing to veterans or veteran families experiencing or at risk of homelessness. This year alone, we will be able to house an additional 30 people in our new Housing for Heroes homes.
At the Housing First Minnesota Foundation, we believe every individual has worth and human dignity and deserves the basic provision of shelter as a necessity of life. Every project is a step closer to ending homelessness in Minnesota.

Skip the expense and hassle of closing twice on your new construction with Bell Bank Mortgage’s One-Time Close Program.

Rate is locked in from initial close
Up to 95% financing on conforming loans


Flexible draw process
Interest only payments for a short period*
Available on new construction and total tear-downs
*After the interest only portion, full principal and interest payments required. Subject to credit approval. Program guidelines are subject to change without notice. Not available in all markets. Other restrictions apply.
Crisp air. Harvest hues. And now it’s happening—your fall garden is calling. Answer with mums and ornamental annuals. Respond with interesting perennials. Get inspiration for outside decor ideas, and make plans with the help of the purple thumbs at Bachman’s.










The Dream Homes on the Parade of Homes support the Housing First Minnesota Foundation’s work building safe housing for Minnesotans in need of shelter. Dream Homes are selected for their exquisite craftsmanship, intricate design details, and the ability to inspire every visitor.





Over the years, thousands of people have toured the Dream Homes, each paying an admission fee that

supports the Foundation. Those that have toured the Dream Homes have helped raise over one million dollars for the Foundation! These funds go directly toward building new or renovating existing housing for Minnesotans experiencing or at risk of homelessness.

In total, the Foundation has completed 62 community build projects with many more to come and has built and restored over 99,000 square feet of housing.
Through fundraisers like our Dream Homes, we have been able to raise more funds, take on larger build projects and help more Minnesotans in need.
Homelessness impacts the present as well as the future – that’s why the Foundation exists, to make that future better for the people in the communities we serve. So, thank you for touring the Dream Homes. Your donation is felt throughout the Twin Cities!
Two Twin City Masonry Showrooms: Elk River 763.441.2004 & Mendota Heights 952.356.0800









Additional MN locations in St. Cloud, Rochester, Brainerd/Baxter, & Duluth. https://www.whitecap.com/brock-white




his two story masterpiece offers a spacious and thoughtfully designed oor plan that is sure to impress he main le el features an e traordinary kitchen with not one, but two islands. The stunning cabinets and high end finishes add a touch of elegance to the space
n office and ids playroom are located between the main and second oors his inno ati e design creates a seamless transition and adds an element of ersatility he second oor boasts four bedrooms, including a guest suite, and a Jack-and-Jill bathroom.
Prepare to be ama ed by the custom wine room, plus a lower le el bar area with impressi e high ceilings large concrete dec with a finished hot tub room offers a pri ate oasis to unwind ou ll also find an athletic court, sauna, e ercise room, pool, outdoor itchen, and multiple patios with porcelain pa ers
LOCATION:
4764 - 146TH AVENUE NE HAM LAKE, MN
Nestled in the Wayzata school district’s newest neighborhood of Hollydale, discover this beautifully designed modern rambler from Swanson Homes.



he main oor li ing spaces include a chef style itchen with an open concept that leads into a stunning dining area and great room. The main oor also offers a wal in prep itchen and pantry, a study or extra bedroom, and a three-season porch with a fireplace for e tended en oyment
lu urious primary suite graces the main le el, with a well appointed bathroom complete with a freestanding tub, wal in shower, separate vanities, and a generous walk-in closet. The lower level features a wet bar with island-style seating, an exercise room, billiards area, media lounge, along with three extra bedrooms and two baths.
LOCATION:
16925 - 46TH AVENUE N.
PLYMOUTH, MN
TOUR


Welcome home to TJB Homes custom-designed walkout rambler with some of the best views in Afton Creek Preserve. This bright and airy open-concept plan features a great room with gas fireplace and beamed vault throughout. The gourmet kitchen has custom cabinet features with a large island, spacious perimeter countertops, and a large walk-in pantry. Don t miss the e ible office space
his e uisite new build features open sun filled spaces with walls of Andersen windows and access to four trac porch with fireplace n the lower level there are two more bedrooms, a great family entertainment space, a custom bar, and so many architectural details

The lower level is complete with a golf simulator room and secret room. We will build on your lot in Minnesota or Wisconsin.
LOCATION:
5671 OAKRIDGE TRAIL AFTON, MN

his magnificent residence is nestled within ster Landing, a serene enclave of Woodbury. Spanning an impressi e , s uare feet and meticulously designed, this home boasts an array of high-end features and finishes he grandeur of the home is showcased by Andersen windows that frame breathtaking views of the surrounding natural beauty.
The home offers ample space for a growing family or those who love to entertain. The gourmet kitchen is a delight, the office pro ides a dedicated wor space for the owners, and the 32’-wide four-season porch is the perfect spot to enjoy the changing seasons.
The primary bedroom is truly a retreat, with a lu urious ensuite and a closet that is nothing short of e traordinary he lower le el presents a ersatile space, complete with a bedroom, recreation room, wet bar, e ercise area, and an indoor gym
LOCATION:
9592 IRON HORSE ROAD WOODBURY, MN
Your all-access ticket allows you to tour all Dream Homes once for $25! Single-home tickets are available for $5 each.
Set on a private 3.25-acre property with breathtaking views, this contemporary design combines beauty and functionality with a striking minimalist approach. Exterior architecture greets you with bold tones, smooth panel siding, and stucco accents. The interior aesthetic blends crisp whites and clean lines with warm textural elements for an appealing color palette. his thoughtfully designed oor plan showcases a 9 foot vaulted great room with an open glass catwalk, gourmet kitchen with custom rift-cut white oak cabinetry, and specialty crafted spaces throughout.
Indoor-outdoor entertaining was emphasized in the design, pulling in the airy and earthy elements of nature, while seamlessly integrating the outdoor living spaces and pool area as the central hub of the home. From the private owner’s wing on the main level to the ele ated finishes, this home is a true showcase
LOCATION: 704 NAUVOO LANE EAGAN, MN



nity Mobile – the fastest mobile service with 5G & millions of WiFi hotspots. Xfinity Unlimited Intro service and Xfinity Internet required. Reduced speeds after 20 GB of usage/line. Taxes and fees extra. Data thresholds may vary.

















THE BUILDERS
CHAMBERLAIN FINE CUSTOM HOMES

CHARLES CUDD CO., LLC
CITY HOMES, LLC
CUSTOM ONE HOMES
GONYEA CUSTOM HOMES
GREAT NEIGHBORHOOD HOMES, INC.
HARTMAN HOMES, INC.
JB WOODFITTER HOMES, LLC
JYLAND CONSTRUCTION MANAGEMENT CO.
LANDUCCI HOMES, INC.
LECY BROS. HOMES & REMODELING
MDS REMODELING, LLC
PILLAR HOMES PARTNER, INC.
RIDGE CONSTRUCTION
THE REMODELERS ISPIRI, LLC
LAKE COUNTRY BUILDERS, LTD.
MARK D. WILLIAMS
CUSTOM HOMES, INC.
REVISION, LLC
VUJOVICH DESIGN BUILD, INC.
WB BUILDERS
Builder and remodeler participants accurate as of print date. List is subject to change.
THANK YOU SPONSORS


So, how do you get started planning your tour? You’ve already picked up the Parade of Homes guidebook, so you’re off to a great start. Be sure to follow us on social media and utilize ParadeofHomes.org to stay in the know and tour like a pro.










This guidebook has details on the incredible homes that are open to tour (for free!) all throughout the Twin Cities. Use the directories to find the city, builder, or amenities you’re looking for in your new home. Then, read up on all the good stuff — number of bedrooms, bathrooms, price, and home features — before heading out to tour.

ParadeofHomes.org


Our website makes it easy to plan your tour from any device. Favorite homes to plan your route, or save and share your searches. You’ll also find all sorts of useful articles and data on the Resources tab and even more home inspiration in the photo galleries and on the blog. Plus, purchase your Dream Home tickets in advance! Visit ParadeofHomes.org to start searching.








Ready to be inspired by never-ending home content? Find us on all the major social media platforms — Facebook, Instagram, TikTok, Pinterest — and get ready to scroll through virtual home tours, interviews with the builders, and tips to creating your dream home on the blog. Plus, plenty of #homeinspo photos for every style.






















Whether you’re looking for a spec home that’s ready for you to move in, a brand-new neighborhood, or the perfect oor plan that s awaiting your finishing touches, the Parade of Homes has the home entry for you. All the entries, apart from the fi e Dream Homes, are free to tour and open Thursdays-Sundays from 12-6 p.m.


So, what’s your type?

A Parade Home is the entry type with which you’re likely most familiar. These entries have never been lived in and are either for sale or reproducible on a similar lot. They feature home stats (think: bedrooms, bathrooms, square footage), photos or renderings, a description, directions, and reflect the current market price. Plan your tour of Parade Homes to get inspired and find your next home!
Get a full look at the inventory options available for future builds with the Ready-toBuild entries. These entries showcase a floor plan ready for a homesite — all that’s missing is you! Review the location of the future home, then head to the on- or off-site sales center to learn about the plan available for that site. Be a part of the process from the ground up!



Want to be the first to live in a brand-new neighborhood? Check out the Coming Soon entries. These entries are new neighborhoods without any homes built yet. Visit the on- or off-site sales center to learn more about the area and the amenities and get started reserving your homesite within the neighborhood.







The all-new neighborhood listing is your chance to explore a variety of floor plans all within one up-andcoming community. See model home details, unique amenities, nearby attractions, and more!









September 9 – October 1 Thursday–Sunday | 12–6PM










Farmington ....319, 320, 321, 322, 323, 324, 325, 326, 327 Forest Lake ......................................................................... 162, 163
Golden Valley .................................................................................. 1
Ham Lake ................................................154, 155, 156, 157, 158

Hanover .............................................................121, 122, 123, 124



Hastings ........................................................................................ 269
Hudson......................................................................224, 225, 226
Hugo .........................197, 198, 199, 200, 201, 202, 203,







When you move with the X nity 10G Network, your new home is ready for anything. It’s reliable enough to power a house full of devices. So the whole family can watch, work, stream and play, all at once. Plus, quick and exible installation options make getting set up easier than ever. That’s one less thing to worry about during your move. Get your new home future-ready with the X nity 10G Network.

































PARADE HOME $1,998,800
3 BED | 2.5 BATH
3,607 SQ FT

New neighborhood in Golden Valley on the 6th hole of GVCC. Seven custom luxury villas with an association. Enjoy a carefree lifestyle with main-level living and nished lower level walkout for entertaining!
GOLDEN VALLEY
1220 GREENWAY PASS Greenway Villas
Homes from $1,700,000 RonClark.com









612-799-5057 | 952-947-3000
Highway 55 to N. Rhode Island Avenue; Go east on Golden Valley Road; North on Pennsylvania Avenue; Go to Greenway Pass; To model home
PARADE
4
McDonald presents six wooded cul-de-sac lots in a prime location! Experience main-level living in luxury with this design or choose from a variety of rambler and two-story layouts for your build! ISD 272



EDEN PRAIRIE
11152 JOHNSON RIDGE
The Hills at Johnson Ridge Homes from $950,000 mcdonaldconstruction.com
612-708-2149
PARADE HOME $929,900

2 BED | 2 BATH
2,293 SQ FT
Minnetonka condo/townhome hybrid. Private garage, no common walls or long hallways, and generous-size flex room. Elevator serves just four units. 10-foot ceilings and corner unit with windows on all three sides.

MINNETONKA
5734 SHADY OAK ROAD, 11 OAK CoV Homes from $799,900 OAKCoV.com
612-275-8255
PARADE HOME $897,775

3 BED |
2.5 BATH
3,356
This luxury villa home provides convenient, one-level living. Open-concept floor plan, with gourmet KT, quartz countertops, vaulted GR, and primary BR. LL entertainment space, exercise room, and two BR.
EDEN PRAIRIE
12665 SURREY STREET
Prairie Heights Homes from $897,775 nortonhomes.com
763-559-2991














PARADE HOME $969,800


3 BED | 2.5 BATH
2,893 SQ FT
Beautiful architecturally designed villa-homes in this carefree lifestyle - with association-maintained services and with countless walkable amenities within community. Reserve your homesite today!
CHANHASSEN

9165 MILLS DRIVE
Avienda
Homes from $800,000 charlescudd.com


612-695-3884 | 612-998-4010
South on I-494; West on Highway 212 to Great Plains Boulevard Exit; South on 101; West on Lyman Blvd.; Community on SW corner of Lyman and Powers Boulevard
PARADE HOME $809,990



4 BED | 3 BATH
3,436 SQ FT
Spacious two-story home with family-friendly layout. Main level includes great room, modern kitchen with island and pantry, laundry, and mudroom. Upstairs features owner’s suite and three bedrooms.
CHASKA
2997 IRONWOOD BOULEVARD
Reserve at Autumn Woods
Homes from $576,945 lennar.com

952-373-0485
Keep left on US-212 west; Exit on Powers Boulevard; Turn right; Turn left on Lyman Boulevard; Turn left on Audubon Road; Turn right onto Blu Creek
JEFF HOLMERS | 612.998.4010
JUSTIN HOLMERS | 612.695.3884





Avienda Village is an exciting new upscale mixed-use community in Chanhassen on the corner of Hwy 212 & Powers Blvd. This walkable community features some of the finest in the urban style living, Avienda Village will blend the best of coffee shops, dining, entertainment, and gourmet grocery all within a short walk from your new home. Built by Charles Cudd Co, these luxury carefree Villa homes are architecturally designed and constructed with the finest in craftmanship. Don’t miss this great one-of-a-kind opportunity to build your new dream home. Reserve your homesite today!



HOME PACKAGES STARTING FROM THE $800’s
For more information visit HolmersGroup.com
CharlesCudd.com
PARADE HOME $624,990
4 BED | 2.5 BATH
2,692 SQ FT
This spacious two-story home features an open-concept layout with the kitchen overlooking the dining room and great room. The rstfloor flex room o ers endless possibilities.
CHASKA
3022 IRONWOOD BOULEVARD
Reserve at Autumn Woods Homes from $604,990 lennar.com



952-373-0485
STARTING AT $960,000
PARADE HOME $995,000
3 BED | 4 BATH
3,955 SQ FT
DDK Construction’s newest line of luxury custom homes o ered in both one-story and two-story plans. This development consists of 17 oversized lots boasting scenic wooded blu views.


CHASKA
4302 DEERE TRAIL
The Harvest - Chaska Blu s Homes from $900,000 ddkconstruction.com
612-701-7557 | 952-486-1391
US-212; East on Big Woods Boulevard/County Road 44; North on Savanna Way; Right on Farm Hill Boulevard; Right on Millstone Drive; Right on Deere Trail
PARADE HOME $669,990


4 BED | 3.5 BATH
3,084 SQ FT
Now available in Chaska! New construction homes on beautiful homesites, four or ve bedrooms, study and loft spaces, stunning kitchens, luxury bedroom suites, and upgrades throughout. Tour the model today!


CHASKA
1539 OAK CREEK DRIVE Oak Creek Homes from $580,000 drhorton.com
612-482-4447




PARADE HOME $597,115

3 BED | 2 BATH
1,990 SQ FT
Robert Thomas Homes is proud to showcase single-level living in our Villa Collection Hampton floor plan. Comfort and sophistication shine throughout this design with features like a gourmet kitchen with custom cabinets and large corner pantry, vaulted four-season porch, and 12’ ceiling in the gathering room. Association-provided lawn care and snow removal are included. HOA fees apply.
CHASKA
6429 HARVEST TRAIL

The Harvest - Villa Collection Homes from $489,900 RobertThomasHomes.com 952-522-2023
I-494 to Highway 212; Follow to County Road 44 (Big Woods Boulevard); East to Savanna Way; Left on Vista View Drive; Left on Timber Arch Drive to model
PARADE HOME $999,390
5 BED | 4.5 BATH
4,797 SQ FT
The Broadmoor in The Harvest community located in Chaska is a must-see! With 4,700+ sq. ft. home includes 5 BR, 5 BA, a formal DR with butler’s pantry to gourmet KT and timeless details throughout.
CHASKA
6502 TIMBER ARCH DRIVE
The Harvest - Tradition Collection Homes from $669,900 robertthomashomes.com


952-522-2023
I-494 to US-212; Follow to County Road 44/Big Woods Boulevard; East to Savanna Way; Left on Vista View Drive to model




5
4,950 SQ FT
McDonald presents a modern Scandinavian-inspired home in Chaska’s newest neighborhood, Ensconced Woods. Located close to charming downtown Chaska, the community features 28 private estate-sized lots nestled among mature trees on the blu s. This home captivates with a statement two-story vaulted stair tower. Main level features a gourmet kitchen with center island and rear prep area, GR with wall of windows and cozy FPL flanked by built-ins, study & screen porch with adjoining deck. In the UL 4 BR, 3 BA, laundry and large vaulted bonus room. The LL is complete with 10’ ceilings, 5th BR, BA, exercise room & media/game room w/built-in bar. We build on our lots or yours! ISD 112
CHASKA
737 ENSCONCED WAY
Ensconced Woods
Homes from $900,000 mcdonaldconstruction.com

612-363-1982 | 612-708-2149
US-212 W.; East on County Road 44 to Founders Way; Right on Founders Way; Left on Founders Path; Left into neighborhood cul-de-sac;
PARADE HOME $1,299,000

5 BED | 2.75 BATH
4,165 SQ FT
The timeless modern styling of this home is accentuated with industrial-looking metal brackets, metal accent roofs, and clean-recessed siding panels. This home has an ideal setting close to town with elevated views of a large wetland, trees, the Minnesota River Valley, and historic downtown Chaska. Stunning Marvin windows on every side pair with unique ceiling vaults and a one-of-a kind floor plan. This home features remarkable outdoor living with a four-season porch, lower-level screen porch, outdoor living space, and a built-in re table. Our trademark age-in-place design showcases how to make this your forever home!
CHASKA
733 ENSCONCED WAY
Ensconced Woods Homes from $950,000 ensconcedwoods.com
507-366-1288 | 612-481-0891
5 BED | 3
3,003 SQ FT
Now selling single-family homes! Rivertown Heights o ers new construction, luxury two-story homes in desired Chaska. These homes o er 4-5 BR, UL lofts, un nished LL, and more! See you on the tour!




CHASKA
4644 PERCHERON BOULEVARD
Rivertown Heights
Homes from $580,000 drhorton.com
612-482-4447
US-212; Exit at Big Woods Boulevard; Travel east to Percheron Boulevard; Turn right to model home
16 Vivid Homes
4 BED | 2.5 BATH
3,360 SQ FT
Don’t miss this chance to own a stunning home in Brookeview, Carver’s newest development. 22 beautiful homesites overlook Carver Blu s. Vivid Homes presents the Sandy, a four-bedroom home with bonus room, gourmet kitchen with beverage center and wine cooler, stainless steel appliances, quartz countertops, two replaces, and a nished basement with wet bar. Perfect for entertaining and relaxation, with spacious bedrooms and inviting living areas. Packed with modern features, this home exudes luxury. See it now and experience the best.
2003 MULBERRY LANE
vividhomes.co
952-412-0094 | 612-578-6872
18
Lennar
US-212 west to Jonathan Carver Parkway/County Road 11 S.; Left on Red Oak Ridge; Left to Spring Creek Drive; Right on Green Ash Drive to Mulberry Lane
MN Lic. #BC796889
2,280 SQ FT
Modern two-story home with nished lower level. Vaulted ceilings in great room, dining room, and kitchen with island. Flex room o ers endless possibilities. Upstairs, an owner’s suite and two more BR.
CARVER
1905 ARBOR LANE
Timber Creek Homes from $354,990 Lennar.com




3 BED | 2.5 BATH
1,719 SQ FT
Comfort and convenience merge in this new two-story townhome. Family room, dining room, and kitchen on the main level. Upstairs, three restful bedrooms including a generously sized owner’s suite.
CARVER
1811 ARBOR LANE
Timber Creek Homes from $354,990
Lennar.com 952-373-0485
BY APPOINTMENT ONLY
Scan






PARADE HOME $607,990






Spacious two-story home with open-concept layout. Kitchen overlooks dining room and great room. Flex room on rst floor. On UL luxe owner’s suite, three secondary BRs with walk-in closets and loft.
CARVER
1902 BALSAM DRIVE
Timber Creek Homes from $354,990 Lennar.com 952-373-0485











PARADE HOME $619,990



5 BED |
4 BATH
3,268 SQ FT

Welcome to our newest design, The Arden. This home features over 3,200 sq. ft. of quality construction and inspiring design. This ve-bedroom, four-bath, three-car-garage home welcomes you with a classic front porch, spacious great room with replace, main-level flex room, and luxury vinyl plank flooring in the foyer, kitchen, dinette and great room. The KT boasts granite countertops, stainless steel appliances, walk-in pantry, oversized center island, and a beautiful morning room. Upper level features an owner’s suite with large walk-in closet, three additional bedrooms, and oversized laundry room. Finished LL features a fth BR, 3/4 BA, and large family room.
CARVER
2001 TAMARACK ROAD
The Preserve Homes from $462,990 brandlanderson.com
612-326-3028 | 952-898-0230

5
Welcome to the Wesley! You’ll love the light- lled KT, beautiful FPL, bonus room and exceptional owner’s BA. The idyllic Huntersbrook community includes a clubhouse and pool. HOA fees apply. ISD 112
VICTORIA
5288 ROLLING HILLS PARKWAY
Huntersbrook Homes from $649,900 robertthomashomes.com 952-522-2023
PARADE HOME $1,124,990
5 BED | 5 BATH
4,698 SQ FT
Style and functionality go hand-in-hand in this award-winning Riley plan. Let the natural light shine through the oversized windows on the main level. The great room with floor-to-ceiling stone replace opens to a dinette featuring a stunning built-in bench that sits across from the gourmet kitchen. Upstairs is the dreamy owners’ suite with a boxvault ceiling. A Jack-and-Jill bathroom connects bedrooms 2 and 3. Find an ensuite bath in the 4th bedroom, perfect for a teen or guest. With plenty of fantastic space, including a rec. room with replace, a game room, an exercise room, a 5th bath and bedroom, the walkout lower level is ideal for family living.
VICTORIA
5284 ROLLING HILLS PARKWAY

Huntersbrook Homes from $599,480 stonegatebuilders.com 952-955-9159
5 BED |




5 BATH
5,156 SQ FT
What’s better than an attractive faux wood exterior? The exceptional quality and design of the Benton interior! Floor-to-ceiling windows allow natural light throughout the dinette, great room, gourmet kitchen, formal dining room, sunroom, and o ce/flex room. Beautiful ceiling beams are located upstairs in the owner’s suite, along with a luxury soaking tub and walk-in shower. The laundry room on the upper level makes one chore more convenient. You’ll nd bedrooms 2, 3, and 4 on the upper level, with two adjoined by a Jack-and-Jill bathroom. An indoor athletic court/exercise room, a 5th BR and BA, a full wet bar, and a rec. room are located on the lower level.
VICTORIA
5289 ROLLING HILLS PARKWAY
Huntersbrook Homes from $599,480 stonegatebuilders.com 952-955-9159
I-494 to MN-5 W. to Victoria Drive/ Co. Rd. 11; South to Harvest Trail; Right to Huntersbrook; Left on Creekside Ln.; Right on Rolling Hills Pkwy.; Home on left
3
Introducing the Revere | NINE in Huntersbrook, a multi-level single-family home o ers a spacious foyer with split staircase, FR, 3 BR, and 2 BA. Residents enjoy the clubhouse and pool. HOA fees apply.
VICTORIA
10142 CORRAL WAY
Huntersbrook - Revere Collection






Homes from $499,900
rturbanhomes.com
I-494 to US-212 W.; Take Engler Boulevard Exit; Go west on Engler Boulevard; North on Victoria Drive to Laketown Township; Huntersbrook is on the left
2,305
Showcasing the modern cottage, Revere | TEN A. This home o ers one-level living with an owner’s suite, laundry, and 2 BR on the main level. Finished LL o ers additional BR, BA, and FR. HOA fees apply.

VICTORIA
10152 CORRAL WAY
Huntersbrook - Revere Collection Homes from $499,900





rturbanhomes.com
I-494 to US-212 W.; Take Engler Boulevard Exit; Go west on Engler Boulevard; North on Victoria Drive to Laketown Township; Huntersbrook on left
952-522-6022 #BC002459

952-522-6022

PARADE
This new townhome is a two-story interior unit with a family-friendly design. The first floor features an open-plan layout among the great room, dining room, and kitchen which has a center island.




VICTORIA
9404 BRIDLE WAY
Laketown Homes from $375,990






lennar.com
952-373-0485
This spacious two-story home features an open-concept layout with the kitchen overlooking the dining room and great room. The firstfloor flex room offers endless possibilities.
VICTORIA
5065 KERBER COURT
Brookmoore
Homes from $533,990
lennar.com
952-373-0485
3 BED | 2.5 BATH
3,519 SQ FT
Our newest award-winning community is located minutes from charming Victoria. This architecturally designed open-concept home boasts countless features and carefree living w/HOA-maintained services.
VICTORIA
6215 LAKESIDE DRIVE
Homes from $850,000
charlescudd.com





612-695-3884 | 612-998-4010
South on I-494; Take US-212 west to Engler Boulevard Exit; West on Engler Boulevard to Victoria Drive; North to Marsh Lake Road; Go west until community
STARTING AT $999,000
PARADE HOME $1,269,000
2 BED | 2.5 BATH
2,700 SQ FT
Welcome home to Walnut Grove Villas, a 14-unit, detached villa townhome neighborhood. The villas offer single-level living in an association-maintained environment. Two floor plan options each provide three-stall garages, three BR or two BR-plus-den options, along with highly detailed living spaces. Customization options to add expanded living areas or bedrooms by converting 3rd stall, if desired. Set between two natural wetlands, the homes are situated on a private cul-de-sac and provide sidewalk and trail access to the Minnetonka Regional Trail System. Enjoy all that the Shorewood, Tonka Bay, and Excelsior area has to offer, all within a five-minute drive.
SHOREWOOD
25495 PARK LANE
Walnut Grove Villas
Homes from $999,000
walnutgrovevillas.com
612-802-6948 | 651-274-0025
From intersection of Highway 41 and Highway 7; Go one mile west to Eureka Road; Go north to Park Lane; East on Park Lane to model home

Housing First Minnesota Bennie Award-Winning Community. This beautiful lakeside community is conveniently located a few miles from charming downtown Victoria. Many of the homes will feature main floor living while others offer full walkout lower levels. Nestled in a 2-acre park with gazebo, play area, extensive walking trails and sidewalks, all while enjoying the serenity and views of Marsh Lake. This community will feature carefree living with a homeowner’s association maintaining the lawns and landscaping, as well as snow and trash removal. Don’t miss this one-of-a-kind opportunity to build your new Charles Cudd dream home. Model homes available for viewing. Reserve your homesite today!



JEFF HOLMERS | 612.998.4010

JUSTIN HOLMERS | 612.695.3884
For more information visit HolmersGroup.com CharlesCudd.com


PARADE HOME $899,900


5 BED |
4 BATH
3,586 SQ FT
Oh, my! This open-concept layout is every family’s dream! The Marion’s showstopping replace in the great room is visible from the gourmet kitchen which is equipped with timeless enameled cabinetry. The main level is completed with a practical flex room, mudroom, powder room, and screen porch. The upper-level open loft is a great place for the kids to hang out while you unwind in the nearby owner’s suite featuring a luxury ensuite bath. Three additional bedrooms, a hall bath, and a convenient laundry area are perfect for easy family living. The lower level invites family and friends to stay with a cozy bedroom and 3⁄4 bath, a rec. room, and a game room.
MINNETRISTA
4517 MEADOWVIEW LANE

The Meadows on Halstead’s Bay Homes from $619,880





stonegatebuilders.com 612-260-2608




MN-7 W. to County Road 44; North on County Road 44; West on Lotus Drive into The Meadows on Halstead’s Bay; Right on Sunset Lane; Continue to home on left














PARADE
3 BED |

























2.5 BATH
2,344 SQ FT
Stylish townhome with an open layout, modern kitchen with 9’ quartz island, abundant natural light, a flex room, owner’s suite with en-suite bath, and a lower level recreation room.

MINNETRISTA
6798 WILDFLOWER WAY


Woodland Cove Homes from $370,990 mihomes.com/paradeTC
612-425-3688

















PARADE HOME $789,800



4 BED | 3 BATH
2,908 SQ FT

Lovely entry with a full front porch, upgraded exteriors nestled in one of Minnetrista’s beautiful developments with nature abound. Main floor with den for your convenience, spacious living with FPL, dining, KT with walk-in pantry, 8’ island, wall oven, gas cooktop and custom beverage area. Family entrance from garage with bench, broom cabinet, work station, walk-in closet and a convenient BA. Laminate and LVT flooring, upgraded quartz kitchen and bathroom tops. Upper level with massive primary BR with tray vault, luxurious BA and walk-in closet. Additional three bedrooms with walk-in closets, full bath and laundry. Your home, your way, from our family to yours.
MINNETRISTA
9197 MAAS DRIVE






The Ponds at Hunters Crest
612-703-4528 | 952-469-8800
Highway 7 west from I-494; Take a left/south on Main Street; Go right/ west on Hunter’s Trail; Left onto Maas Drive; Model on left




STARTING AT $795,000
PARADE HOME $812,000
3 BED | 3 BATH
3,150 SQ FT
Woodridge Homes has main-level living with solid-wood cabinets, millwork, doors, and too many features to list. Tall windows overlooking wooded lot with nished LL. Located in Woodland Creek Development.
WACONIA




1855 CAMPFIRE DRIVE E. Woodland Creek



Woodridgehomesllc.com 612-741-5448

West on Highway 5 to Waconia; South on County Road 284; Left on Elm Creek Road; Left on Camp re Drive W.; Right on Woods Point; Right on Camp re Drive E.

PARADE HOME $407,990
3 BED | 2.5 BATH
1,831 SQ FT
Family-friendly, two-story townhome with un nished basement for flexibility. Open-plan layout connects great room, dining room and multi-functional KT. Patio as an added plus for outdoor enjoyment.
WACONIA
411 MURRAY HILL WAY
Waterford
Homes from $349,690
Lennar.com
952-373-0485
PARADE HOME $627,970






4 BED | 2.5 BATH
2,487 SQ FT
Family-friendly, two-story home with endless possibilities. Great room, kitchen with nook, flex room and mudroom on the rst floor. Upstairs has laundry, 3 BR, and owner’s suite with walk-in closets.
WACONIA
609 SIERRA PARKWAY
Waterford
Homes from $344,990
Lennar.com




952-373-0485

From Highway 5, turn onto Highway 284; Take a right onto Sparrow Road; Turn left onto Ravencroft Road

PARADE HOME $709,700
2 BED | 3 BATH
2,975 SQ FT
The one-story Leo features a gourmet kitchen with 10-ft. quartz island, family room with stone replace and box beams, a den with built-in desks, a luxurious owner’s suite and a nished lower level.
WACONIA
1951 OAKPOINTE DRIVE
Orchard Park
Homes from $365,990 mihomes.com/ParadeTC
612-425-3688
Highway 5 west to Orchard Road; Go south at the roundabout; Turn right on Oakpointe Drive to model; In Google Maps enter “M/I Homes Orchard Park”
PARADE HOME $485,990
4 BED | 2.5 BATH
2,103 SQ FT
New floor plans in Waconia! Fields of Waconia o ers beautiful homesites, 3-5 bedrooms, loft spaces, and bedroom suites! This neighborhood is near Lake Waconia and many other outdoor activities.

WACONIA
526 GOLDENROD TRAIL





Fields of Waconia
Homes from $420,000 drhorton.com
612-482-4447
From Highway 5 in Waconia, take Waconia Parkway south to Wildflower Way; Turn right to model home

PARADE HOME $629,700
4 BED | 3.5 BATH
2,691 SQ FT
Orchard Park o ers one- and two-story homes with flexible, open layouts to grow with your family, and your choice of nishes to build your dream home. Visit the Henry model to explore the possibilities!


WACONIA
1959 OAKPOINTE DRIVE
Orchard Park Homes from $365,990 mihomes.com/ParadeTC
612-425-3688
Highway 5; West to Orchard Road; Go south at the roundabout; Turn right on Oakpointe Drive to model; In Google Maps enter “M/I Homes Orchard Park”
PARADE HOME $619,990





5 BED | 3 BATH
3,003 SQ FT
This charming neighborhood has two-story homes with four to ve bedrooms near walking trails and a city park. Quick move-in homes available with pond-view homesites. Visit the Jordan model today!
WACONIA
528 GOLDENROD TRAIL
Fields of Waconia
Homes from $550,000 drhorton.com
612-482-4447

From Highway 5 in Waconia; Take Waconia Parkway South to Wildflower Way; Left on Goldenrod Trail to model home

PARADE HOME $874,700
5 BED | 4.5 BATH
4,698 SQ FT
Set on a large homesite and surrounded by trees, the exquisite Jordan model features ve BRs and a loft, a gourmet kitchen with dual islands, a flex room, dining room, and a fully nished lower level.

DELANO
1297 WOODS CREEK DRIVE S.
Legacy Woods Homes from $449,990 mihomes.com/paradeTC
612-425-3688
US-12 to County Line Rd. SE; South to 90th St. SE/Franklin Township Rd.; East to Woods Creek Dr. S. to model; In Google Maps enter “M/I Homes Legacy Woods”
PARADE HOME $448,990


4 BED |



2.5 BATH
1,989 SQ FT
Greywood in Delano o ers beautiful two-story homes ranging from 1,751-2,617 sq. ft., 3-5 BRs, and is near outdoor activities such as Lake Rebecca Park Reserve and Crow River. Start your new home search!
DELANO
409 GREYWOOD BOULEVARD
Greywood Homes from $400,000 drhorton.com




612-482-4447
From west on US-12; Turn left onto County Road 30 SE/Woodland Road; Turn left onto SE Darren Avenue; Model is on the right o Greywood Boulevard
PARADE HOME $480,000
2 BED | 2 BATH
1,717 SQ FT
One-level villas in this charming community of Willowbrook in Delano. Two fresh, contemporary floor plans have been thoughtfully crafted to meet your everyday needs, or design one to your liking. It features an open-concept main level with plenty of natural light flowing throughout the main area. It o ers two BR plus a den and three BR with both two full BA. The owners’ suite o ers a full BA and walk-in closet. Relax on your screen porch or opt for a second larger porch tucked in the back. Plenty of storage available in the crawl space or two-car GAR. This community is within walking distance of walking paths, ponds, stores, clinics, and banks. It’s a perfect blend!
DELANO
1261 WILLOWBROOK CIRCLE
Willowbrook Homes from $470,000 willowbrookdelano.com
612-568-4663
US-12; North on County Line Road
SE; One block to St. Peter Avenue E.; Go west; Go north on Willowbrook Circle
PARADE
4 BED | 2.5 BATH
2,692 SQ FT
Welcome to Highland Ridge in Delano! We are highlighting our Lewis floor plan, which provides homeowners with an open-concept layout that’s perfect for growing families, hosting, and more.

DELANO
257 - 6TH STREET NW
Highland Ridge Homes from $400,990 lennar.com


952-373-0485
US-12 to Delano; West on Woodland Road/County Road 30; North on Davidson Avenue; East on Franklin Avenue
MN Lic. #BC001413

46 JP Brooks Builders
PARADE HOME $489,900

5 BED | 3 BATH
2,775 SQ FT
The Madison plan features 5 BR, 3 BA, luxury owners’ bath, o ce, deck and nished LL. Desirable Arbor Meadows community with ponds, wetlands, trails, city park and close proximity to Lake Pulaski.


BUFFALO
2605 ARBOR DRIVE
Arbor Meadows
Homes from $331,000 jpbrooks.com/communities
763-645-5980 | 763-247-4420
North on Highway 55; Right on Willems Way; Go to 8th Street NE and 20th Street NE; Left on Dague Avenue NE; Community on left
PARADE HOME $499,900
5 BED | 3.5 BATH
3,488 SQ FT
The Mulberry main floor includes kitchen, dining, great room and flex room. The second floor includes owner’s suite, three BRs, and loft. The lower level is nished with a bedroom, bath and family room.

BUFFALO
2418 GREENBRIAR LANE
Greenbriar Hills
Homes from $389,900
capstonehomes-mn.com






763-843-2626
I-94 to MN-241 (St. Michael Exit); South on MN-241 for 12 miles to Dague Avenue NE; North to 30th Street NE; West to Greenbriar Lane; North to home on left
STARTING AT $349,900
PARADE HOME $369,900


4 BED | 2.5 BATH
2,337 SQ FT
Our Bristol floor plan showcases a light- lled morning room and an extended kitchen island on the main level. The Parkwood community is located within a stunning setting of rolling hills and wetlands.

ROCKFORD
5311 GREENWOOD AVENUE
Parkwood
Homes from $419,990
lennar.com

952-373-0485
2 BED | 1.75 BATH
1,464 SQ FT
Final phase. Seven units left. Open floor plan that includes two bedrooms, two bathrooms with quartz countertops, all appliances, replace, covered deck, large trim and casings, walk-in closet in owner’s bedroom, kitchen with walk-in pantry, and laundry on main level. Un nished lookout lower level with rough-in bath. Fully insulated and sheet-rocked garage, including garage opener.
ROCKFORD
8051 WINFIELD ROAD
Boulder Ridge
Homes from $349,900 novak-fleck.com
763-424-4955 | 612-834-0468



PARADE HOME $1,725,000
3 BED |

3 BATH
3,300 SQ FT
Welcome to Aava Vetta of Long Lake. All villas offer private elevators and are equipped with Sub-Zero and Wolf appliances that come standard. Beautifully appointed row homes with views of Long Lake!

LONG LAKE
1883 SYMES STREET
Aava Vetta
customonehomesmn.com


612-805-6890 | 651-459-1972
US-212 W.; Continue on W. Wayzata Boulevard; Turn right onto Mill Street; Mill Street goes left and becomes Symes Street; Follow to property
PARADE HOME $676,900
3 BED | 3 BATH
1,965 SQ FT
Each beautifully designed twin home offers luxury single-level living with an abundance of natural light, stunning four-season sunroom, an elegant owner’s suite with private BA, and a second BR/BA.

PLYMOUTH
3705 QUEENSLAND LANE N.
Homes from $599,900
holmersgroup.com




612-701-9016 | 612-695-3884
I-494 to Highway 55; West on Highway 55; South on County Road 101; South to the neighborhood on the right-hand side before Medina Road
PARADE HOME $2,100,000
5 BED | 4 BATH
4,408 SQ FT
This modern rambler is nestled beautifully in Wayzata schools’ neighborhood of Hollydale. This home features a chef-style open-concept kitchen that leads to a stunning dining area and great room.

PLYMOUTH
16925 - 46TH AVENUE N.
Hollydale
SwansonHomes.com

763-478-0320
From Highway 55 W. in Plymouth; Right on Peony Lane N.; Right on Old Rockford Road; Left on Holly Lane N.; Right on 46th Avenue N.; Home on
STARTING AT $1,900,000
PARADE HOME $2,095,000
6 BED |
5 BATH
6,400 SQ FT
Exceptionally designed for the best in everyday living and fun entertaining, our new enhanced design The Rockefeller delivers on it all! Starting with an impressive modern exterior and carrying through to rich interior finishes, this incredible home offers a feeling excellence inside and out. An inviting grand staircase greets guests in style while the beautiful kitchen makes anyone feel at home, well served by an intelligent walk-through pantry. Main level is nicely complimented by a radiant sunroom as an ideal extra living space. UL features a luxurious owner’s suite, four bedrooms, and large bonus room. Lower level is owned by the ultimate athletic court, tall ceilings, and bar.
PLYMOUTH
16940 - 46TH AVENUE N.
Hollydale Homes from $1,400,000 NIHhomes.com



952-200-4481 | 651-248-5491
I-494 to Rockford Road; Go west; Turn right on Old Rockford Road to Holly Lane; Turn right (north) to 46th Avenue; Turn right to home on left
PRIVATE NEIGHBORHOOD POOL, CLUBHOUSE,
[NORTHWEST OF I494 & ROCKFORD RD AT HOLLY LANE N & OLD ROCKFORD RD] FORMER HOLLYDALE GOLF COURSE IN PLYMOUTH, MN




229 CUSTOM HOME & VILLA LOTS
LARGE CUSTOM HOME LOTS



VILLAS W/ HOA LAWN CARE & SNOW REMOVAL

LUKE HANSON | 763.360.9942
LUKE@LUKEHANSONHOMES.COM
HANSONBUILDERS.COM


















#BC004568
WAYZATA SCHOOL DISTRICT
LARGE PARK & OPEN SPACE
BEAUTIFUL VIEWS
AARON LOWE | 952.200.4481
AARON@NIHHOMES.COM
NIHHOMES.COM

#BC419931
BLAKE SWANSON | 612.710.8353
BLAKE@SWANSONHOMES.COM
SWANSONHOMES.COM
BETH OBERLANDER | 612.990.6797
BETH.OBERLANDER@ROBERTTHOMASHOMES.COM
ROBERTTHOMASHOMES.COM
#BC644819
#BC627982
ANDY MILLER | 612.203.3329
AMILLER@GONYEACOMPANIES.COM
GONYEAHOMES.COM
#BC002459
PARADE HOME $1,599,000
5 BED |
5 BATH
5,840 SQ FT
Hanson Builders’ latest home design in Hollydale, The Sutton Sport. This home has a lot of functional spaces with an open main-floor layout with black floor-to-ceiling Pella windows, 10’ ceilings with beams and detail throughout. The chef’s kitchen is a dream with a large center island, sink on the exterior wall, high-end range and walkthrough prep pantry. The vaulted hearth room has breathtaking views overlooking the community. The upper level has four bedrooms, a bonus room, and a private owner’s suite with dual closets. The secondary bedrooms all have private baths. The lower level includes a fth bedroom, sport court, wet bar, family room and exercise area.
PLYMOUTH
17005 - 48TH AVENUE N.
Hollydale
Homes from $900,000
hansonbuilders.com


763-360-9942 | 763-286-2509
West on Highway 55; North on Peony Lane N.; East on Old Rockford; North on Holly Lane N.

PARADE HOME $1,249,900


5 BED |
5 BATH
4,387 SQ FT
Say hello to the Harriet in Hollydale! A house perfect for kicking your feet up and enjoying all the Minnesota seasons in the attached sunroom surrounded by floor-to-ceiling windows. Enameled cabinetry and a large island in the gourmet kitchen open to the great room and dinette. A spacious owner’s suite with a box-vaulted ceiling, large walk-in closet, and luxury ensuite bath are on the upper level. One bedroom has a private 3⁄4 bath. Bedrooms two and three are connected by a Jack-and-Jill bath. The walkout lower level checks all the boxes when it comes to entertaining, with a wet bar, replace, game room, an exercise room, large bedroom, and 3⁄4 bath.
PLYMOUTH
4695 COMSTOCK LANE N.
Hollydale
Homes from $1,016,258
stonegatebuilders.com 952-800-9970
West on Highway 55; North on Peony Lane; East on Old Rockford Road; North on Holly Lane; East on 46th Avenue N.; North on Comstock Lane N.; Home on left



































































































































































7,431 SQ FT
Hanson Builders’ latest home design in Hollydale, the Oakmont. This home showcases a beautiful design of selections and functional spaces. The main level is open and spacious with black floor-to-ceiling Pella windows, 10’ ceilings with beams and detail throughout. The chef’s kitchen is a dream with a large center island with a sink, high-end range and a walk-through prep pantry. The vaulted hearth room has heated flooring. The upper level holds four bedrooms, a bonus room, and a private owner’s suite with dual closets. The secondary bedrooms have “princess alcoves” and private baths. The lower level has a golf simulator, sport court, wet-bar and sauna.
PLYMOUTH
4705 COMSTOCK
Hollydale
Homes from $900,000
hansonbuilders.com
763-360-9942 | 763-286-2509
on Holly Lane N.
PARADE
3 BED |
3 BATH
4,274 SQ FT
Step inside the Vermillion and enjoy the luxury and convenience of main-level living. The gourmet kitchen is a chef’s dream and is perfect for entertaining. The area is designed for hosting friends and family with a hidden butler’s pantry that allows the prep mess to be hidden while guests gather around the large island or mingle in the nearby great room or sunroom. Natural stone, high-end nishes, and hand-picked light xtures are featured throughout the main level and in the laundry, pocket o ce, and flex room. There is more space for entertaining in the lower level which includes two bedrooms, a bath, wet bar, rec. room, and walkout to the backyard.
PLYMOUTH
4620 FOUNTAIN LANE
Hollydale
Homes from $1,016,258
stonegatebuilders.com
952-800-9970
◊ Bright, open, & airy fl oor plans with soaring vaults

◊ Over 3,200 Sq. Ft. of luxurious fi nished space

◊ D eep two and three-stall garages
◊ Beautiful new 76-acre site with miles of paved trails
◊ Optional swimming pool & pickleball court access


PARADE HOME $1,199,461

5 BED | 4.5 BATH
4,579 SQ FT




Robert Thomas Homes is proud to present The Wesley. An architect-designed Heritage Collection home that showcases a gourmet kitchen with wine bar, resource area, beautiful custom built-ins throughout, a large bonus room, and wet bar in the lower level. This model is located in the Hollydale community in Plymouth, where you are surrounded by an abundance of amenities such as trails, neighborhood clubhouse, and pool. HOA fees apply. Wayzata ISD 284 Schools.
Want to tour on your own schedule?

Connect with builders to schedule a visit at select homes available by appointment only. Streamline the process of visiting by effortlessly booking an appointment online or sending them a note with your availability to tour their latest developments. Look for the yellow boxes with QR codes to schedule your appointment!

PLYMOUTH
4695 GARLAND LANE N. Hollydale Homes from $769,900 robertthomashomes.com
952-522-2023

Calling all 21+ beer lovers! In honor of 75 years, we’re launching a signature brew in partnership with Bauhaus Brew Labs. Come sip a pint of our collaboration brew, enjoy some food truck bites, and celebrate the incredible legacy of the Parade of Homes. Then, pick up a four-pack at Haskell’s Wine & Spirits or Top Ten Liquors.



BREW LABS








PARADE HOME $1,282,800


3 BED | 3.5 BATH
3,457 SQ FT
Newest luxury community, open-concept floor plan with architectural details throughout, gourmet kitchen, spacious owner’s suite with soaking tub, large shower, and walk-in closet. Finished walkout lower level for entertaining.

PLYMOUTH
16770 - 58TH AVENUE N. The Highlands on Dunkirk Homes from $950,000 charlescudd.com


612-670-3839 | 612-333-8020
I-494 to Highway 55; West 3 miles to Vicksburg Lane; North on Vicksburg; 2 miles to 57th; Go 1/2 mile until Dunkirk; South on Dunkirk (GPS 5815 Dunkirk)
PARADE HOME $1,120,500
6 BED | 5 BATH
4,923 SQ FT
Carlson Ridge model has a thoughtfully designed kitchen, o ce, flex spaces, 5 BRs, and primary suite that is truly a retreat. Finished walkout LL has a built-in beverage wall, media room, and exercise room.




PLYMOUTH
18356 - 56TH COURT N. Carlson Ridge
651-334-6000
Bass Lake Rd.; West to Vicksburg Ln.; South to Co. Rd. 47; West to Troy; South to home OR
I-494 to Hwy. 55; West to Peony Ln.; North to 54th Ave. to home
PARADE HOME $1,695,000
5 BED |
BATH 5,023 SQ FT
Welcome to Woods of Medina, within the Wayzata school district! This modern luxe model with exceptional custom details is available for immediate occupancy. Visit our website for more photos and info.

MEDINA
711 SHAWNEE WOODS ROAD Woods of Medina
hartmanhomesinc.com
715-377-1555 | 612-481-9700
I-494
PARADE HOME $475,335

3 BED | 3 BATH
1,906 SQ FT
Welcome to Meadow View in Medina! Townhomes feature open-concept main level with large kitchen islands, three upper-level bedrooms, three bathrooms, a loft area and include a two-car garage.
MEDINA
1005 JUBERT DRIVE
Meadow View Homes from $432,990 lennar.com 952-373-0485
I-494 to Highway 55; West to Pinto Drive; North to Meander Road; West to Jubert Drive; South to model




PARADE
3 BED |
3 BATH
3,686 SQ FT
Newest luxury community, open-concept floor plan with architectural details throughout, gourmet KT, spacious owner’s suite with soaking tub, large shower and walk-in closet. Reserve your private homesite!

MEDINA
1595 MARSH POINTE COURT


Marsh Pointe Preserve
Homes from $1,250,000 marshpointepreserve.com
952-250-1075 | 952-250-2015
I-494; West on Highway 55; Go approximately 6 miles to Arrowhead Road; North on Arrowhead until Marsh Pointe Court
PARADE
4 BED |

4 BATH
4,765 SQ FT
The Rockwell is Hanson Builders’ latest one-level home design that is going to WOW you! Immediately, you’ll notice the eye-catching front elevation with a four-car garage, black Pella windows, and a cozy front porch. Upon entering, you’ll notice the open and spacious feeling of the 10-foot ceilings on the main floor, oversized center island, and a large prep kitchen that is tucked behind the main kitchen which features an additional dishwasher, sink, and plenty of storage! This home also includes a nished lower level with a wet bar, three large bedrooms with walk-in closets, a large family room with a separate game area.
MEDINA
4308 HILLSIDE DRIVE
Weston Woods of Medina Homes from $900,000 hansonbuilders.com


763-360-9942 | 763-286-2509
PARADE HOME $860,580



Extensive use of glass and soaring vaults creates an abundance of natural light in these luxurious and spacious, award-winning main-floorliving walkout rambler townhomes. Amazing new convenient site.

MEDINA
4586 TOVERO TRAIL
Weston Woods of Medina
westonwoodstownhomes.com
612-490-0558
Highway 55 to Arrowhead Road; North on Arrowhead to Chippewa Road; (Arrowhead Road turns into Chippewa Road); West to Mohawk Road; Go north and follow sign
3,328 SQ FT
This two-story home is designed for comfort. The rst floor boasts a dining room, breakfast nook, kitchen, versatile study and great room. Upstairs, discover a spacious owner’s suite, a loft, and three BRs.
CORCORAN
6510 TAMARACK LANE
Tavera
Homes from $629,990 Lennar.com 952-373-0485
West on Highway 55 to County Road 116/Pinto Drive; North on County Road 116/Pinto Drive; West onto Horseshoe Trail; Left onto Tamarack Lane

GEORGE STICKNEY | 952.250.1075

KEVIN STICKNEY | 952.250.2015
Located in the heart of Medina, Marsh Pointe Preserve is an association maintained, luxury single family home community in the award-winning Wayzata School District. This 36-acre site is an exclusive enclave of 30 spectacular homesites offering privacy and majestic views. The architecturally designed homes will be built by Charles Cudd Co, through a seamless collaboration of our in-house design team, interior designers, and constructed with the finest craftsmanship. Don’t miss this one-of-a-kind opportunity to build your new dream home. Contact us to reserve your homesite today!
HOME PACKAGES STARTING AT $1.25M


For more information visit marshpointepreserve.com
CharlesCudd.com
PARADE HOME $649,410



4 BED |





3 BATH
2,271 SQ FT
Discover contemporary living in this new two-story home. The main floor seamlessly connects a great room, nook, and kitchen with a corner pantry. Upstairs, nd an owner’s suite, three BRs, and a laundry.


CORCORAN
19938 - 65TH AVENUE
Tavera Homes from $629,990 lennar.com


952-373-0485
PARADE HOME $455,035
3 BED | 2.5 BATH
1,777 SQ FT

Welcome to elegance in this two-story townhome with a versatile lower level. The rst floor o ers an open design connecting a family room, dining room and kitchen. Upstairs, nd three spacious BRs.
CORCORAN
20059 - 62ND PLACE
Tavera Homes from $629,990 lennar.com 952-373-0485






PARADE HOME $625,990

4 BED | 2.5 BATH
2,756 SQ FT
Wayzata schools! Just opened, Walcott Glen o ers an approachable price point in one of the Twin Cities most desirable areas. Tour our Park Place model to see where convenience perfectly meets style.





CORCORAN
19174 - 62ND AVENUE
Walcott Glen Homes from $540,990 pulte.com
952-260-7939
PARADE HOME $739,700

3 BED | 3 BATH
3,099 SQ FT
This one-story, association-maintained villa features 3 BR plus a den, a designer kitchen with large island and walk-in pantry, gas replace, sun- lled morning room, and a nished lower level for entertaining.
CORCORAN
20174 - 79TH AVENUE
Rush Creek Reserve
Homes from $369,990 mihomes.com/ParadeTC
612-425-3688
3,313 SQ FT
Robert Thomas Homes is proud to showcase single-level living in our Hamilton model. Comfort and sophistication shine through this design with features like a gourmet kitchen with custom cabinets, vaulted four-season porch, and a 12’ co ered ceiling in the gathering room. Association-provided lawn care and snow removal included. HOA fees apply. Limited Homesites Available!
CORCORAN 7401 ELM LANE
Cook Lake Highlands - Villa Collection Homes from $549,900 robertthomashomes.com

952-522-2023
PARADE HOME $674,700
5 BED | 3.5 BATH
3,039 SQ FT
With ve BRs plus a loft, the Sophia is a must-see! This home features a designer kitchen with a walk-in pantry, family room with modern gas replace, second-floor laundry, and a nished lower level.
CORCORAN
20180 - 79TH AVENUE
Rush Creek Reserve
Homes from $369,990 mihomes.com/ParadeTC
612-425-3688








STARTING AT $1,100,000 PARADE HOME $1,350,000
4 BED |
3.5 BATH
3,913 SQ FT
Extraordinary custom-built rambler with lower level walkout located in The Ridge at Elm Creek neighborhood. This floor plan o ers spacious living that makes sense. Highlights include open concept LR, DR, and KT area, distressed wood beamed ceiling accents, vaulted sunroom/ study, fabulous three-season porch with replace, deck, main-floor owner’s suite with adjoining laundry o closet, fabulous walk-through pantry with sink, LL family room with replace and wet bar, 2 LL BRs, exercise room (could be 4th bedroom), craft room, and 2 zoned heating and air. This home is completed with beautiful nishes as Creek Hill Homes is known for. Great walking trails and shared pool and park.
MAPLE GROVE
6329 BLACKOAKS LANE N.
The Ridge at Elm Creek
612-751-0976







PARADE HOME $595,000
2 BED |

2 BATH
1,788 SQ FT
Welcome to Fox Briar Ridge East, a new community addition by Donnay Homes featuring 17 twinhomes. Enjoy maintenance-free association living with quality craftsmanship throughout, including one-level-living slab and basement plans. This unit is a slab-on-grade plan located at the end of the development, providing abundant natural light through its south-facing windows. The open floor plan features a spacious kitchen, dining area and great room with 10’ ceilings, a replace, entertainment cabinets, and a four-season sunroom. Great close-in Maple Grove location o ers convenient commutes to shopping, restaurants, and recreation with easy I-494/I-94 access.
MAPLE GROVE
7015 WESTON LANE N.
Fox Briar Ridge East Homes from $585,000 donnayhomes.com
952-297-6636 | 612-919-4085
4 BED |
BATH
3,044 SQ FT
Welcome to Fox Briar Ridge East, a new community addition by Donnay Homes featuring 17 twinhomes. Enjoy maintenance-free association living with quality craftsmanship throughout, including one-level-living slab and basement plans. This unit is a walkout basement plan located at the end of the development, providing abundant natural light through its south-facing windows. The open floor plan features a spacious kitchen, dining area, and great room with 10’ ceilings, replace, entertainment cabinets, three-season sunroom and deck. The lower level has two additional bedrooms, a bathroom, wet bar and large family room area. Great close-in Maple Grove location.
MAPLE GROVE
7010 WESTON LANE N.
Fox Briar Ridge East Homes from $585,000 donnayhomes.com
952-297-6636 | 612-919-4085
STARTING AT $769,900
PARADE HOME $1,025,000
5 BED | 4.5 BATH
4,861 SQ FT
Creative Homes is showcasing a high-fashion, luxurious home with a prep kitchen, three-season porch, movie theater, and wine room. This home is a must-see!


MAPLE GROVE
18035 - 101ST PLACE
Evanswood Homes from $653,900 creativehomes.com
612-502-5106










5 BED | 4.5 BATH
3,807 SQ FT
Welcome to the Robert Thomas Homes’ Woodbridge model. This Heritage Collection home showcases a light- lled gourmet kitchen, beautiful gas replace flanked by built-ins and wood beams, and a large upper-level bonus room. The exceptional owner’s bath has a freestanding tub, separate vanities, oversized shower, and large walkin closet. Evanswood is a peaceful community in Maple Grove with open spaces and walking trails.


PARADE HOME $1,299,900

5 BED | 4 BATH
4,996 SQ FT
There’s more to the Pepin than its enticing exterior! Check out the two-story great room with a wood-beam ceiling and soaring stone replace. Elevated tile, millwork, and lighting, as well as a gourmet kitchen, butler’s pantry, formal dining, and a full bedroom and bath, are located throughout the main level. The stunning upper level can be reached using the oak and wrought-iron railing on the winding staircase. A private owner’s suite, a loft, three additional bedrooms, two baths, and a laundry room are all located on the upper level. The wet bar, fth bedroom, hall bath, and walkout to the backyard make the lower level great for hosting.
MAPLE GROVE
10100 PEONY LANE N.
Evanswood Homes from $694,359 stonegatebuilders.com 763-250-5177

3
MAPLE GROVE
10119 SHADYVIEW LANE N.
Evanswood
Homes from $649,900
robertthomashomes.com


952-522-2023
1,800 SQ FT
Introducing a contemporary two-story townhome. Stylish open-concept layout on the rst floor. Upstairs, nd a loft, two secondary bedrooms, and a luxe owner’s suite with a retreat.

MAPLE GROVE
10502 WESTON WAY N.
Weston Commons Homes from $344,990 lennar.com
952-373-0485

PARADE HOME $405,990
3 BED | 2.5 BATH
1,719 SQ FT
Two-story townhome design o ers comfort and convenience.


Double-height foyer, great room, dining room, and modern kitchen. Serene outdoor patio. Upstairs has three BRs including spacious owner’s suite.
MAPLE GROVE
10529 WESTON WAY N.
Weston Commons
Homes from $344,990 lennar.com
952-373-0485
ONLY
PARADE HOME $386,990




3 BED | 2.5 BATH
1,791 SQ FT
Experience contemporary luxury in this two-story townhome. Stylish open-concept layout, shared living space, and a luxe owner’s suite with a retreat. Upgrade your lifestyle!
DAYTON
10886 TERRITORIAL TRAIL
Territorial Commons Homes from $333,990 lennar.com





952-373-0485
From I-94 W.; Exit onto Dayton Parkway; Turn right on Dayton Parkway; Right onto County Road 81; Left on Territorial Road; Right onto Territorial Trail
STARTING AT $567,990
PARADE HOME $699,999
4 BED | 3.5 BATH
3,323 SQ FT
Our two-story Ontario home design has high-end nishes and features throughout. 4 BR, 3.5 BA, study, DR, and FR centered around a stunning gourmet KT. Upstairs also o ers a large owner’s retreat.
DAYTON
11612 BRAYBURN TRAIL




Brayburn Trails
Homes from $419,990
DavidWeekleyHomes.com
763-251-0337 | 651-425-0175

Highway 610 to Maple Grove Parkway N.; East on County Road 81 to Fernbrook Lane N.; North on Fernbrook to 117th Ave.; West on 177th Ave. to Brayburn Trails
PARADE HOME $729,900
3 BED |
3 BATH
3,001 SQ FT
Home featureslarge, open-concept KT, DR, GR with wood beams, and two BRs on main level with walk-in shower in owner’s suite. LL o ers a bar for entertaining, rec. room, additional BR, and exercise room.

DAYTON
15540 - 111TH AVENUE N.
Sundance Greens 4th Addition Homes from $675,000 regencyhomesincorporated.com/ model-homes
612-741-1668 | 763-438-1030
111th
Lane;
85 Simmer Brothers Homes, Inc.
86 Lennar

4 BED |
3 BATH
3,522 SQ FT
3 BED |
2.5 BATH
1,906 SQ FT
This three-bedroom, two-story townhome is an end unit featuring a family-friendly design. The rst floor showcases a fabulous great room and dining area. The second floor features a spacious loft.
15531 - 111TH AVENUE N.
Sundance Greens
simmerbrothers.com
763-753-3760
87 Lennar
I-94; North on Maple Grove Parkway; East on County Road 81; North on Fernbrook Lane; West on Rush Creek Parkway; Right on Sundance Ridge; Right on Quantico; Right on 111th Avenue
#BC002571
MN Lic.
DAYTON
14511 - 112TH AVENUE N.
Sundance Greens Homes from $357,990
lennar.com
952-373-0485
88
BY APPOINTMENT ONLY Scan to Schedule Your Tour Time





DAYTON
10942 GLACIER LANE N.
Sundance Greens Homes from $357,990





lennar.com
MN Lic. #BC001413
DAYTON
10945 GLACIER LANE N.
Sundance Greens Homes from $357,990 lennar.com
952-373-0485
Lennar MN




2
This contemporary single-story home has an open layout, connecting the great room, dining room, and kitchen. Rest and rejuvenate in three bedrooms, including the owner’s suite. Experience comfort and style!
PARADE HOME $725,990

4 BED | 4 BATH
3,328 SQ FT
The two-story Washburn home features a formal dining room, casual breakfast nook, inviting great room, and versatile study. The upper level has a loft, three secondary bedrooms, and an owner’s suite.
DAYTON
11027 KINGSVIEW LANE
Sundance Greens
Homes from $357,990 lennar.com



952-373-0485
PARADE HOME $674,700



4 BED | 3.5 BATH
3,623 SQ FT
Opening in October! The Victoria model’s open layout includes a flex room, a family room with tile replace, vaulted morning room, and a stunning kitchen with pecan-stained cabinetry, a large island to enjoy casual meals, quartz countertops and a walk-in pantry. Walk upstairs to the sun- lled loft, a tech nook, spacious secondary bedrooms and a convenient laundry room. The owner’s suite features a quartz vanity, tiled shower and a walk-in closet. Downstairs the walkout lower level o ers a large recreation room, additional bedroom and bath perfect for guests or quiet workspace. Visit the M/I Homes’ model at 14736 River Hills Parkway, Dayton, to learn more!
DAYTON
14423 KINGSVIEW LANE N.
Riverwalk
Homes from $499,990 mihomes.com/ParadeTC
612-425-3688
NOT AVAILABLE FOR SHOWING
$794,000
PARADE HOME $979,000
4 BED | 4.5 BATH
4,532 SQ FT
In this highly sought-after Sundance Greens community the Hillcrest Sport is a Hanson Builders’ favorite. This amazing home includes Pella berglass windows, custom cabinetry throughout, heated floors, oversized three-car garage, nished lower level with a sport center, family room, replace, and wet bar. The home also includes a maintenance-free deck and site- nished enamel woodwork.
DAYTON
11067 KINGSVIEW LANE N.
Sundance Greens
Homes from $626,000 hansonbuilders.com 320-333-1879 | 763-286-2509



I-94; North on Maple Grove Parkway; East on County Road 81; North on Fernbrook Lane N.; West on Rush Creek Parkway; Right on Sundance Ridge; Right on Kingsview Lane
STARTING AT $623,000
PARADE HOME $746,000
4 BED | 3 BATH
2,981 SQ FT
Welcome to the Remington, Hanson Builders’ newest one-level model. The main floor features an open concept between the great room, dining area, and kitchen. You’ll love the huge island and walk-in pantry, and enjoy the wide open views of the backyard through the large Pella windows. The lower level features two spacious bedrooms with large walk-in closets and a large open family room and game area.
DAYTON
14506 KINGSVIEW LANE
Riverwalk
Homes from $593,000 hansonbuilders.com
612-232-4990 | 763-286-2509
US-169; Take Dayton River Road west; West onto Pioneer Parkway; North onto Kingsview Lane

PARADE HOME $949,000
4 BED |




4.5 BATH
4,580 SQ FT
In this highly sought-after community, the Hillcrest Sport plan is a Hanson Builders’ favorite and includes black Pella berglass windows, custom cabinetry throughout, heated floors, oversized three-car garage, nished lower level with sport center, family room with a replace and wet-bar. This home also features site- nished enamel woodwork throughout. The community features a clubhouse, playground and private community pool.
3 BED | 2.5 BATH
2,930 SQ FT
The Marley’s open layout includes a gourmet kitchen, vaulted morning room, modern family room with a gas replace, and white oak accents, bonus room with wood ceiling and a loft. It’s a must-see!



DAYTON
14510 KINGSVIEW LANE
Riverwalk
Homes from $593,000 hansonbuilders.com
612-232-4990 | 763-286-2509
DAYTON
14736 RIVER HILLS PARKWAY
Riverwalk
Homes from $499,990 mihomes.com/paradeTC

612-425-3688
PARADE HOME $649,900
4 BED | 3 BATH

3,155 SQ FT
This stunning rambler has 4 BRs, 3 BAs, enameled custom cabinetry, Andersen windows, and many upgraded nishes. Stainless steel appliances, a huge walk-in pantry, and a large granite island and countertops make this the perfect home for entertaining! The main level also has a study, a great room with replace, a custom media center, laundry room with granite countertops, and there’s even a large mudroom with custom lockers for everyone! The owner’s suite has a sitting area, walk-in shower with two showerheads, a standalone soaking tub, and two granite vanities. The n. LL features a sports bar. A generous landscape allowance is included. There are many lots to choose from.
DAYTON
14915 - 142ND AVENUE N.
Diamond View Estates
simmerbrothers.com
763-753-5590
PARADE HOME $614,990


4 BED | 3.5 BATH
2,786 SQ FT
The McKinley floor plan o ers residents a home that has a spacious main level with a dining room, kitchen, living room, and o ce. Additionally, the upper level has three secondary bedrooms.
DAYTON
13794 - 142ND AVENUE N. Edgewater Homes from $416,990 lennar.com 952-373-0485


5
This new, two-story home features the Donovan floor plan and o ers a lower level that’s full of possibilities. The main level is designed for contemporary living with a seamless flow.

DAYTON
14131 BERKSHIRE LANE N.
Edgewater Homes from $416,990
lennar.com

952-373-0485
3,003 SQ FT
Located near Elm Creek Park Reserve, Cypress Cove features two-story homes with four or ve bedrooms and o er upgraded options in the kitchens, and includes walking trails and a neighborhood park!

DAYTON
14443 DALLAS LANE

Cypress Cove Homes from $560,000 drhorton.com
612-482-4447
PARADE
4 BED | 2.5 BATH
1,989 SQ FT
Homes include 3-4 BRs at Cypress Cove. Community includes walking trails, homesites with trees and pond views, a city park with disc golf, picnic areas, and more! Tour our decorated Pine model today!

DAYTON
14463 DALLAS LANE
Cypress Cove
Homes from $430,000 drhorton.com
612-482-4447
US-169 N.; Go west on Dayton Road to Pioneer Parkway; Turn left and go to Dallas Lane; Left to model home
PARADE
3 BED | 2.5 BATH
1,687 SQ FT

Now selling townhomes at Balsam Pointe in Dayton! We are o ering 2and 3-level townhomes with two-car garage, quartz counters, optional electric replace, 3 or 4 BRs and study options available! Learn more!





DAYTON
11218 BALSAM POINTE TRAIL





Balsam Pointe
Homes from $330,000 drhorton.com
612-482-4447
US-169; Go northeast on Dayton River Road; Left on S. Diamond Lake Road; Go to Balsam Lane; Turn right to Balsam Pointe to the model home

PARADE HOME $619,990

5 BED |
2.5 BATH
2,599 SQ FT
Homes at Oaks at Bauer Farm o er concrete driveways, upgraded options, plus beautiful homesites! This community also includes walking trails, community park, pool, and pickleball! Tour the model today!


CHAMPLIN
12906 BURR OAK LANE N. Oaks at Bauer Farm
Homes from $570,000 drhorton.com
612-482-4447
US-169; Go west on W. Hayden Lake Road; Continue to French Lake Road; Turn right onto Burr Oak Lane to model home
$435,000
PARADE HOME $465,000
2 BED | 2 BATH
1,653 SQ FT
One-level detached villas with homeowner’s association, open floor plan, two bedrooms, two bathrooms, four-season porch, replace, kitchen with walk-pantry, center island with quartz countertops, vaulted ceilings, 3’ wide doors, all appliances, owner’s bedroom with walk-in closet, oversized garage, concrete driveway, and completely sodded and landscaped.
STARTING AT $385,900
Come home to our newest community, Trott Brook Crossing! This community features our Creative Homes’ quality, customer experience and personalization at an a ordable price point. The Hudson model is an awesome main-level living home with three bedrooms, three BA, and a three-car garage. The kitchen is the heart of this home with beautiful quartz countertops, Samsung appliances, and a fun mosaic backsplash. Also, notable is the cozy replace and the large glass windows bringing in tons of natural light to the open layout. The primary suite located o the great room includes dual sinks and a spacious walk-in closet with convenient access to the laundry room.
RAMSEY
17046 URANIMITE STREET NW
Trott Brook Crossing Homes from $359,900 creativehomes.com

612-502-5106
US-10 W: Exit Ramsey Blvd. NW; Left onto Alpine Drive; Right onto Variolite Street NW; Right onto 170th Avenue NW; Left onto Uranimite Street; Model on left
ANOKA
457 GARFIELD STREET
Pinewski 4th Addition
Homes from $435,000 novak-fleck.com
763-424-4955 | 612-867-9451
From
in
4th Avenue N. to Pleasant Street W.; Highway 47 north to Gar eld Street; Home on right
PARADE HOME $536,990
4 BED | 2.5 BATH
2,692 SQ FT
This home features our spacious two-story Lewis floor plan with its open-concept layout, the kitchen overlooking the dining room, a great room, and a rst-floor flex room o ering endless possibilities.
RAMSEY 15283 MARMOSET STREET NW

Northfork Meadows Homes from $441,990 lennar.com 952-373-0485



Highway 10; Take the Armstrong Exit; Go east to Alpine Drive; Turn left; Model is on the left o Marmoset Street
MN Lic. #BC001413




PARADE HOME $322,990
3 BED | 2.5 BATH
1,800 SQ FT
This new two-story townhome features a contemporary design. The rst floor o ers a stylish open layout among the GR, DR and KT. Upstairs, a loft adds shared living space with two secondary bedrooms.

RAMSEY
8013 - 149TH LANE NW


Lynwood Homes from $303,990 lennar.com

952-373-0485


 BY APPOINTMENT ONLY
BY APPOINTMENT ONLY
PARADE HOME $342,990



3 BED | 2.5 BATH
1,906 SQ FT
A brand-new community of two-story townhomes in Ramsey. Lynwood features the popular Je erson floor plan with three bedrooms, twoand-a-half bathrooms, and a two-car garage.





RAMSEY
8014 - 149TH LANE NW Lynwood Homes from $303,990 lennar.com 952-373-0485
108 Lennar
5 BED |
3 BATH
2,579 SQ FT
Welcome to Capstone’s Primrose III floor plan. The Primrose III is a modi ed split-level home boasting a beautiful vaulted ceiling and a spacious open-concept main-floor layout. The king-size owner’s suite includes a little extra privacy, a private bathroom with an optional soaker tub, and a large walk-in closet. Two other bedrooms and a full bathroom complete the main level. The nished lower level o ers additional living space, two bedrooms, and a full bathroom. Riverstone South boasts a variety of home plans from single-family homes from the upper $300Ks to detached townhomes from the mid $300Ks.
RAMSEY
14624 SNOWY OWL STREET NW
Riverstone South Homes from $350,000 capstonehomes-mn.com


612-261-1576
PARADE HOME $449,990

2 BED | 2 BATH
1,801 SQ FT
Birchwood in Rogers o ers low-maintenance villa-style homes with lawn care and snow removal. Amenities include tness center, bocce ball and a garden center. Visit the decorated Dover model today!



ROGERS
19405 GRASS LAKE TRAIL
Birchwood Homes from $430,000 drhorton.com


612-482-4447
MN-101; East on S. Diamond Lake Road; North on Brockton Road N.; Property on the east side of Brockton
PARADE HOME $479,990

3 BED |




2 BATH
1,983 SQ FT
This new single-story home showcases a contemporary design with basement options available at select homesites. The main level features an open-plan layout among the great room, dining room, and KT.

ROGERS
11500 BROOKVIEW DRIVE
Laurel Creek
Homes from $408,990 lennar.com
952-373-0485
Take I-494 to new Dayton Parkway; Go south; Cross over Brockton Lane; Enter the Laurel Creek Community
PARADE HOME $346,550
4 BED | 2.5 BATH
1,658 SQ FT
New twinhomes are now available in Rogers! Two floor plans with four bedrooms, 1,658-1,989 sq. ft., located on beautiful home sites, many with wetland and pond views. Quick move-in homes available.
ROGERS
19462 - 136TH AVENUE N. Grass Lake Preserve Homes from $340,000 drhorton.com
612-482-4447
I-94; Merge on to Dayton Parkway; Turn left on County Road 81; Right on Brockton Lane; Right on 136th Avenue to the model
PARADE HOME $444,700
3 BED | 2.5 BATH
2,336 SQ FT
The Prescott model has a prime location within walking distance of shopping and dining, just minutes from I-94. You’ll love the open layout, modern replace, light- lled flex room, and nished lower level.

ROGERS
13685 MARSH VIEW TRAIL Marsh View Homes from $349,990 mihomes.com/paradeTC
612-425-3688
MN-101
PARADE HOME $399,700
The light- lled Avery has a spacious kitchen open to the FR, DR. Upstairs features a private owner’s suite, two BRs and convenient laundry. The LL includes a rec. room and access to the two-car garage.


ROGERS
13613 PINE DRIVE
Towns at Fox Creek Homes from $324,990 mihomes.com/paradeTC
612-425-3688
I-94 to MN-101; South on Main Street; Right on Industrial Boulevard; Left on Hynes Road to model; In Google maps enter “M/I Homes Towns at Fox Creek”
PARADE HOME $599,700
4 BED | 3.5 BATH
2,705 SQ FT
This modern two-story home boasts an open layout, gorgeous kitchen with richly stained cabinetry and white quartz countertops, a flexible loft space, second floor laundry, and a fully nished lower level.
ROGERS 24251 EDGEWATER LANE Edgewater Landing Homes from $389,990 mihomes.com/paradeTC
612-425-3688




LLC
STARTING AT $349,990
PARADE HOME $409,990
3 BED | 2.5 BATH
2,020 SQ FT
Now open! You’ll love our Duncan home design for its stylish-practicality and thoughtful design. The expansive living spaces throughout will make you forget that this isn’t a single-family home.
ROGERS 22149 HARVEST AVENUE
Aster Mill Homes from $344,990 pulte.com 952-260-2041








From I-94 take Exit 207A for MN101 towards Rogers; Go south on MN-101 to Industrial Boulevard; Right on Main Street; Right onto 129th Avenue N.

115 Lennar




116
Lennar
|
ROGERS
BY APPOINTMENT ONLY Scan to Schedule Your Tour Time





This stunning two-story home includes a main-level flex room, four upper-level bedrooms, and an upper-level laundry. The rst floor features an open floor plan and is family friendly.





ROGERS
12517 RACHAEL DRIVE
Skye Meadows
Homes from $364,990 lennar.com 952-373-0485

I-94; MN-101; South on Main Street to Territorial Road; Right on Rachael Drive OR

PARADE HOME $429,990

3 BED | 2.5 BATH
1,719 SQ FT
This two-story townhome o ers four spacious bedrooms, an openplan layout, seamlessly connecting the great room, kitchen, and dining room, leading to a private patio. Welcome to contemporary living!
ROGERS
23087 HAZEL LANE
Skye Meadows Homes from $333,990









lennar.com
952-373-0485
ONLY
PARADE HOME $464,990
3 BED | 2 BATH
1,582 SQ FT
This two-story home includes a lower level, a family-centered rst floor, dining room, and a kitchen with a center island. While upstairs there is an owner’s suite and two more bedrooms. Live in luxury!
ROGERS
23129 HAZEL LANE
Skye Meadows Homes from $333,990 lennar.com
952-373-0485

PARADE
5 BED | 3 BATH
3,160 SQ FT
Buy your new dream home in this growing family-friendly city of Rogers. Harvest View o ers two-story homes with 3 to 5 BRs, loft spaces, UL laundry and beautiful bedroom suites. See you on the tour!
ROGERS
23101 ASHBURY DRIVE
Harvest View Homes from $430,000 drhorton.com

612-482-4447





Take I-94 to Rogers; Travel south on Main Street to Territorial Road; Turn right onto Rachael Drive; Left on Ashbury to model home
STARTING AT $441,000
PARADE HOME $599,900
5 BED | 4 BATH
3,140 SQ FT
The Brookview two-story home in River’s Edge of Hanover (open enrollment to STMA schools) features gourmet kitchen, shiplap electric replace, luxury bath, deck, o ce, nished lower level with wet bar, three-stall garage with workshop.

HANOVER
11367 - 5TH STREET NE
River’s Edge Homes from $341,000 jpbrooks.com/communities
763-247-4925
STARTING AT $434,000
PARADE HOME $609,900
3 BED | 3 BATH
3,169 SQ FT
The Somerset Rambler in River’s Edge of Hanover (open enrollment to STMA schools) features gourmet kitchen, shiplap gas replace, luxury bath, deck, four-season porch, o ce, nished lower level, and threestall garage with workshop.




HANOVER
11399 - 5TH STREET NE
River’s Edge Homes from $341,000 jpbrooks.com/communities
763-247-4925
124
PARADE HOME $598,920


4 BED | 3 BATH
2,746 SQ FT
This beautiful rambler home features two bedrooms on the main floor, allowing for flexibility in use. The private en-suite includes dual sinks and a large walk-in closet. The open floor plan creates a spacious and connected living area with an upgraded kitchen featuring quartz countertops and oversized island along with a main floor laundry. The nished lower level brings additional living space with two additional bedrooms, a full bathroom, and a walkout design that o ers views of the pond. Your home, your way, from our family to yours.
HANOVER
9745 JORDAN AVENUE NE
Crow River Heights West
763-442-2028 | 952-469-8800
County Road 19 to Hanover; West on Beebe Lake Road; South on Kadler Avenue NE; West on Jordan Avenue NE to home
STARTING AT $388,000
PARADE HOME $539,900
2 BED | 2 BATH

1,948 SQ FT
The Waterford SOG home in River’s Edge of Hanover (open enrollment to STMA schools). Gourmet kitchen, stone gas replace, vaulted ceilings, luxury bath, patio and o ce. Heated, insulated three-stall garage with workshop.
HANOVER 11417 - 5TH STREET NE
River’s Edge Homes from $341,000 jpbrooks.com/communities
763-247-4925
STARTING AT $700,000
PARADE HOME $949,900
6 BED | 5.5 BATH
5,322 SQ FT
Capstone’s newest plan The Everest will amaze you! While touring the home you will be drawn to the exceptional views of Uhl Lake. We thought of everything. You will be impressed! The cozy replace and extra-large windows in the great room provide beautiful views. The gourmet kitchen, center island and spacious dining room, this area will be the focal point for you family. The bonus of this home is the complete guest suite on the main floor with a kitchenette, bed, bath, and a private sitting room. The second floor has everything you would expect and a loft. The lower level showcases a family room with wet bar, additional bedroom, bath and tness room.
ST. MICHAEL
8861 LEGACY BAY DRIVE NE

Legacy Bay Farms
Homes from $390,000
capstonehomes-mn.com 763-439-0868



I-94; Take Exit 205 for County Road 36/MN-241 (west); Follow MN-241 through St. Michael; Take Jamison Avenue (south) to Legacy Bay Drive (west); Home on left







STARTING AT $705,000 PARADE HOME $799,000
4 BED | 5 BATH
4,028 SQ FT
The Westley Sport is a top-selling sport center home. The large great room showcases a wall of Pella windows with custom built-ins around the replace. The kitchen features double ovens, a large center island, lots of storage and a kitchen sink o ering great views over the backyard and sun room. The home features a nished lower level with a large family room, game area, wet-bar, and Sport Center. The upper level includes four bedrooms, three bathrooms and a large laundry room with a lots of storage space.
ST. MICHAEL
10991 - 23RD STREET N.
Lakeshore Preserve Homes from $559,000 hansonbuilders.com
763-350-1148 | 763-286-2509
Labeaux Avenue NE to 23rd Street NE; East on 23rd Street NE; Quick right onto Keystone Avenue NE; Model is on the right
PARADE HOME $1,025,000
4 BED | 3.5 BATH
3,486 SQ FT
Dingman Custom Homes welcomes you to Lakeshore Preserve and our custom-built four-bedroom, two-story home on Gonz Lake. This home has all the features you would expect from an award-winning builder.




ST. MICHAEL
2254 LAKESHORE POINT CIRCLE NE
Lakeshore Preserve 2nd Addition
612-325-1687 | 763-438-8931
I-94 west; Take MN-241 W. to County Road 19 (Main Street); Go south 2 miles to 23rd Street NE (west); Turn right: Left on Lakeshore Point Circle NE
PARADE HOME $894,700




5 BED | 3.5 BATH 4,134 SQ FT
Combining luxury, style, and active living, the Archer features a grand two-story foyer with an open staircase, gourmet kitchen with wood beams, owner’s suite with a sitting room, and a sport court.

ST. MICHAEL
2890 KENSINGTON AVENUE NE

Lakeshore Park
Homes from $449,990 mihomes.com/paradeTC
612-425-3688
Highway 241; South on Main Street/ Labeaux Ave. NE; Right on 30th Street NE; Left on Kepler Ave. NE to model; In Google Maps enter “M/I Homes Lakeshore Park”
PARADE HOME $409,700

3 BED | 2.5 BATH
1,942 SQ FT





The loft-like Afton features a light- lled family room with modern replace, sleek kitchen with quartz countertops, luxurious owner’s suite, and walkout lower level with a recreation room.


ST. MICHAEL
2952 KEPLER AVENUE NE
The Towns at Lakeshore Park Homes from $324,990 mihomes.com/ParadeTC


612-425-3688





PARADE HOME $539,700


3 BED |



2 BATH
1,899 SQ FT
The one-story Cedarwood II is a light, airy home with an open layout, designer kitchen with large island, a cozy replace, and a sitting room that walks out to the patio. Plus, lawn care is included!

ST. MICHAEL
2934 KAMA AVENUE NE
Vista Pointe Homes from $360,990 mihomes.com/ParadeTC
612-425-3688
Get a full look at the inventory options available for future builds with the Ready-to-Build entries. These entries showcase a floor plan ready for a homesite — all that’s missing is you! Review the location of the future home, then head to the on- or off-site sales center to learn about the plan available for that site. Be a part of the process from the ground up!
STARTING AT $460,500
PARADE HOME $546,345


3 BED | 2 BATH
1,878 SQ FT
Fantastic development with an up-north feel, pond, mature trees, and beautiful large lots! Walk to stores and the park. Gorgeous luxury detached homes featuring an open great room, three bedrooms, two full bathrooms, replace, quartz countertops, stainless steel built-in appliances, and custom cabinets. High ceilings, oversized center island, walk-in pantry, and luxury owners’ bedroom with ceramic tiled walk-in shower, double vanity, and walk-in closet. Lots of storage, large sunroom overlooking an oversized lot, concrete patio, and a deep three-car garage that is insulated. LP Siding. Homes with walkout basements are also available. Association-maintained.
ST. MICHAEL
251 - 2ND STREET SE
Creekside West
benzingerhomes.com
763-424-8593
Take I-94 to Highway 241; West to Lincoln Drive NE; South to 2nd Street SE; Model on right
STARTING AT $470,500
PARADE HOME $524,675
3 BED | 3 BATH
2,400 SQ FT
This spectacular home has a single-level, open floor plan with a great room in an association-maintained neighborhood. The amazing oversized gourmet kitchen features custom cabinets, a large center island, quartz counters, and stainless steel appliances. A large owner’s suite with luxurious bath includes a ceramic-tiled shower and quartz countertops. An additional bedroom, powder room, mudroom, and deck completes the main level. The open staircase leads to a nished lower level with one large bedroom, bathroom, and a huge family room with a gas replace and wet bar. Beautiful lots overlook wetlands. Walk to St. Michael’s new Town Center Park.
ST. MICHAEL
4661 LANDMARK DRIVE NE
Town Center North of St. Michael
benzingerhomes.com
763-424-8593
Take I-94 to Highway 241; Go west to Edgewood Drive NE; Go north to Landmark Drive; Follow Landmark Drive to model




















4 BED |


2,729 SQ FT
Robert Thomas Homes invites you to the growing Anton Village community to tour our new Classic Collection model home, the Aria. Quality craftsmanship and modern design features are found throughout this home. An open light- lled floor plan with a large gathering room and gas replace flows to the open dining area and to the kitchen. The upper level o ers three bedrooms, two bathrooms, and laundry. The nished lower level o ers an additional family room, bedroom, and bathroom. St. Michael ISD 885
9765 - 46TH STREET NE
Anton Village - Robert Thomas Homes Homes from $429,900 robertthomashomes.com 952-522-2023
3



1,773

The Heritage Collection at Fieldstone Passage in St. Michael. This collection is showcasing the Foster floor plan that features large main-floor space and the dinette o to the side of the kitchen.

ST.
9549 - 51ST STREET NE
Fieldstone Passage Homes from $380,990 lennar.com



952-373-0485

PARADE HOME $550,000
4 BED | 2.5 BATH
2,692 SQ FT

The Discovery Collection at Fieldstone Passage in St. Michael. Showcasing the Lewis floor plan which features an upper-level loft, walk-in closets in all four bedrooms, and a stunning kitchen.

ST. MICHAEL 9563 - 51ST STREET NE Fieldstone Passage Homes from $380,990 lennar.com 952-373-0485


PARADE HOME $616,900

4 BED | 3 BATH
2,682 SQ FT
The Taylor floor plan is a beautiful two-story home. a family-friendly haven that features an open design with 2,660 square feet of living space. This community o ers beautiful views.




OTSEGO
5278 RAMIER AVENUE NE Highlands of River Pointe Homes from $457,990 lennar.com 952-373-0485




I-94 to Highway 101; North to County Road 36 (53rd Street); Right to Randolph Avenue NE; South turn left on Ramier; Model is on your right
MN
137 Lennar
4 BED | 3 BATH
2,468 SQ FT
Meadows of River Pointe by Lennar Homes is located in Otsego, Minnesota! This community features homes that overlook wooded areas, ponds, and wetlands with amazing views.

OTSEGO
17754 - 54TH STREET NE
Meadows of River Pointe Homes from $457,990 lennar.com


952-373-0485
139 M/I
Homes
OTSEGO
7290 PARQUET AVENUE NE
Boulder Pass Homes from $362,990 mihomes.com/ParadeTC
612-425-3688
PARADE HOME $699,900
6 BED | 5 BATH
5,044 SQ FT
Harvest Run East is nestled in the heart of Otsego and o ers a variety of single-family floor plans along with our fabulous villa collection of one-level-living homes. Come visit us today!
OTSEGO
6076 QUIN AVENUE NE
Harvest Run Homes from $400,000 capstonehomes-mn.com



763-300-0730
140
Turn right on County Highway 36/45th Street NE; Left on Queens Avenue NE; Right on 61st Street NE (next to the Otsego water tower); Follow
to sales center
BATH 3,547 SQ FT
3.5
PARADE HOME $333,990


3 BED | 2.5 BATH
1,800 SQ FT
Welcome to Parrish Meadows in Otsego! This new, two-story townhome is an end unit that features a contemporary design. The rst floor o ers a stylish open-concept layout among the GR, DR, and KT.




OTSEGO
8701 PARK AVENUE NE
Homes from $331,990
lennar.com 952-373-0485





STARTING AT $554,500
PARADE HOME $708,145
4 BED | 3 BATH
3,093 SQ FT
Just completed! New development w/large private lots, mature trees and a convenient location! Close to stores, schools and parks. All homes include Diamond Kote LP siding. Great room features a replace and built-in entertainment cabinets. The kitchen includes quartz countertops, stainless steel appliances, upgraded custom cabinets, an oversized center island and walk-in pantry. The owner’s BR features a vaulted ceiling, huge walk-in closet, and private bath with ceramic-tiled shower and double vanity. The nished LL has a family room with a gas FPL and wet bar, two BR, a BA, and lots of storage. Sunroom, Trex deck with stairs to grade. Three-stall garage. This is a must-see!
OTSEGO
7516 OCEAN AVENUE NE
Ashwood, 3rd Addition
benzingerhomes.com



763-424-8593

Take Highway 101 to County Road 38; Go west to Odean Avenue; Go north to 75th Street NE; Turn left on 75th Street NE; Go west to Ocean Avenue NE
$356,990
3 BED | 2.5 BATH
1,906 SQ FT
Welcome to Parrish Meadows in Otsego! This Je erson two-story townhome is an end unit featuring a family-friendly design. The rst floor showcases a great room, a dining room, and a kitchen.


OTSEGO
8702 PARK AVENUE NE
Parrish Meadows

Homes from $331,990
lennar.com
952-373-0485
Highway 101; West on River Road NE, which turns into Parrish Avenue NE; Left on 87th Street NE; Right on Parkview Avenue NE; Left on Park Avenue NE
PARADE HOME $479,990


4 BED | 3.5 BATH
2,242 SQ FT
Northwater o ers our Express Premier raised-ranch single-family homes ranging from 1,988 – 2,513 sq. ft. with 4-5 bedrooms. Homes include nished LL and 3-car garages. Tour the new model today!

OTSEGO
12018 - 71ST STREET NE
Northwater Homes from $450,000 drhorton.com


612-482-4447
Take I-94 west to Exit 137; Take Maciver Avenue NE to 70th Street NE in Otsego; Continue straight at the roundabout to 71st Street; Turn right to model
145 Lennar
PARADE HOME $488,990

4 BED | 2.5 BATH
2,563 SQ FT

Now selling two-story single-family homes with 3-5 BR. Homes feature quartz kitchen countertops, stainless appliances, walk-in pantry, loft spaces, and luxury bedroom suites. Tour the furnished model.

OTSEGO
8018 MARQUETTE AVENUE NE Prairie Pointe Homes from $420,000 drhorton.com
612-482-4447


146 Lennar


I-94; Exit on 60th St. NE; Turn left on Maciver Ave. NE; North to 80th St.; Turn right to Marlowe Ave.; Travel north; Road turns to 83rd St. to models
PARADE HOME $423,770

3 BED | 2 BATH
2,111 SQ FT
This new three-story home is in the Hunter Hills community in Otsego, MN! The home o ers an open-concept kitchen, dining room, and living area. The upper level includes two spacious bedrooms in addition to the owner’s suite.



OTSEGO 11508 - 80TH STREET NE Hunter Hills Homes from $389,990 lennar.com 952-373-0485
PARADE HOME $474,990

4 BED | 3 BATH
2,271 SQ FT
The Vanderbilt two-story home features a contemporary design with a great room that flows seamlessly into a nook, kitchen with a corner pantry, and versatile flex space.
OTSEGO

11404 - 83RD STREET NE



Hunter Hills Homes from $367,990 lennar.com
952-373-0485
147
PARADE HOME $415,000
4 BED | 2.5 BATH
2,049 SQ FT
This new two-story home is a family-friendly haven. The first floor features a great room that flows seamlessly into the dining room and the gourmet kitchen in a modern open-plan layout.

OTSEGO
8016 LANGLEY AVENUE
Hunter Hills Homes from $367,990 lennar.com
952-373-0485
149 Price Custom Homes
From I-94 take exit for County Road 19; Right at Labeaux Avenue NE; Take the 2nd exit at traffic circle; Continue to 80th Street NE; Turn right
PARADE HOME $749,900
4 BED | 3 BATH
3,532 SQ FT
Welcome to Pine Crest Estates West, our newest community with private wooded acreage home sites. This development abuts Sherburne National Wildlife Refuge. Our featured Parade of Homes model is a fully finished executive walkout rambler with premium finishes throughout. Vaulted ceilings, chef’s kitchen, built-in fireplace, LVP flooring, and much more. Open main-floor concept with two bedrooms, mudroom, and laundry room. Lower level offers additional two bedrooms, a full bathroom, a wet bar, and flex space. This is a mustsee home and development!
BIG LAKE
17663 - 262ND AVENUE NW
Pine Crest Estates West
sotahomes.com/pine-crest-estates-west 612-502-9955
Highway 169; Go west on County Road 4; Go approximately 6 miles; Turn left on 177th Street; Then right on 262nd Avenue; Model on the left
STARTING AT $460,000
PARADE HOME $749,900
4 BED | 3 BATH
3,465 SQ FT
The Stonewood plan: 4 BR, 3 BA, luxury primary BA, deck, finished LL, and 4-plus-car garage. Desirable shores of Eagle Lake Community with 1,800+ ft. of lakeshore with two docks, trails, beach and pavilion.




BIG LAKE
23824 - 185TH STREET NW
The Shores of Eagle Lake Homes from $411,000



jpbrooks.com/communities




763-645-5980
US Highway 10 west; County Road 15; Exit in Big Lake Township; Follow County Road 15/237th Avenue NW; Go to 185th Street NW in Orrock Township
4
2,349 SQ FT
Beautiful modern-designed, new construction home built by Price Homes nestled on a 4+ acre lot. Fantastic layout and features. 10’ main-floor ceiling, LVP flooring, large windows providing great natural light with gorgeous wide open country views. The kitchen boasts granite countertops, custom cabinets and large island. Three bedrooms and two bathrooms on one level. Private owner’s suite with vaulted ceiling, owner’s bath, dual-vanity sinks, linen and a huge walk-in closet. Fully finished lower level with large family room, additional bedroom, and full bathroom. Oversized four-car garage, LP siding. This home and property are a must-see!
PRINCETON 12724 - 293RD AVENUE NW
Lindquist Acres North
sotahomes.com/new-construction 612-502-9955
Highway 169 N. to County Road 9 Exit; Left onto 293rd Avenue (approx. 0.5 miles); Model on the right
$760,000 PARADE HOME $925,000
4 BED |
4 BATH
3,750 SQ FT
Welcome to the brand-new Woodhaven in Nowthen, where you can enjoy large acreage sites, private/wooded views and convenient location that allows outbuildings! We welcome you to take a look at our newest rambler layout that features two bedrooms plus an o ce on the main floor, all on 4.5 acres. Main floor boasts an open floor plan that is perfect for entertaining! Lower level is nished, complete with two additional bedrooms, an exercise room and family/rec. room with a walk-up bar. Stop by and see why NIH Homes is “Often imitated but never duplicated.”
NOWTHEN
20182 CLEARY ROAD NW
Woodhaven Homes from $700,000 NIHhomes.com
612-282-7094
153
PARADE HOME $799,900

4 BED |
2.75 BATH
3,902 SQ FT
Our most popular rambler, the Cascade, includes many upscale amenities on a gorgeous 1.7-acre lot. This lot features a pond out back and a 43-acre park with walking trails across the street. Eye-catching views from the large great room windows and the enlarged front porch. This plan boasts a unique rear stairwell with wood railing and spindles, granite countertops, a walk-in pantry, and mudroom with a drop station. The owner’s suite has a private bath with a walk-in-shower and dual sinks.
PARADE HOME $553,520
4 BED |



3 BATH
2,271 SQ FT
This new two-story home features a contemporary design. The rst floor showcases a great room flowing seamlessly into a nook and kitchen with a corner pantry while flex space o ers versatility.



ANDOVER
722 - 151ST LANE NW
Fields of Winslow Cove
Homes from $504,990
lennar.com
952-373-0485
Highway 65 North; Left (west) on Andover Boulevard; Right (north) on Prairie Road; Take the round-
STARTING AT $980,000 PARADE HOME $1,298,900
3 BED |
3 BATH
3,962 SQ FT
ANDOVER
1260 - 167TH AVENUE NE
Country Oaks North
Homes from $650,000 pricecustomhomesmn.com



612-384-8093 | 763-670-3678
Take Hanson Boulevard NW; Go east to 167th Avenue NE; Home on right
HAM LAKE
202 - 176TH AVENUE
Deer Island Homes from $980,000
tjbhomes.com
763-780-2944 | 763-286-6868
Highway 65 to Crosstown; West 3/4 mile to 175th Avenue (58); North 6 blocks to 176th Avenue; Left to model
WOW! Every aspect of this rambler is lled with excitement, like the gorgeous 6.2-acre site with trees and scenic wetlands, 3.5-season porch, deck, high ceilings, and vaults with beams. The chef’s kitchen has a butler’s pantry with cabinets. The lower level has a bar, built-ins, exercise room, and two more bedrooms. The owner’s suite is t for royalty. The four-car garage is fully insulated. Anoka Hennepin School District/Andover HS. We have four wooded lots from 2 to 5 acres on which to build your custom, energy-e cient TJB home. TJB Homes will take your old home in trade on the model or custom-built home. TJB Homes will build on your lot in MN or Western WI. MN Lic. #BC001845


4 BED | 2.75 BATH
3,003 SQ FT
A unique walkout rambler in a stunning dark-color palette on a beautiful acreage lot backing¬†up to mature trees for natural privacy. Custom features include granite throughout, box-vaulted ceilings, stainless appliances, custom backsplash, 74” electric replace, a fully nished basement, and much more. Bring the toys because this home includes a four-car, sheet-rocked garage. More lots in the coveted Andover school district are available for this plan and others.
PARADE HOME $999,999
5 BED | 3.5 BATH
3,621 SQ FT
New Ham Lake development Evergreen Estates acreage lots. This charming rambler has an owners’ suite with a private bath that o ers a huge walk-in tiled shower, soaking tub, double sinks and a walk-in closet. Also, two more bedrooms and full bath on the main floor. The kitchen has granite countertops, a massive island that overlooks the living room, vaulted ceilings, a stone replace, and built-in cabinets. The lower level is built to perfection with a full wet bar that opens to the large family room with a replace. With two more bedrooms, a full bath, a flex room, and plenty of storage space. The oversized four-car garage is a plus!
HAM LAKE
870 - 174TH AVENUE NE
Crosstown Rolling Acres
Homes from $599,900
pricecustomhomesmn.com
763-670-3678
Highway 65 to Crosstown Boulevard NE; West to Polk Street NE; South to 174th Avenue NE; West to model on left
HAM LAKE
2250 - 154TH AVENUE NE
Evergreen Estates
Homes from $945,900 langbuilders.com
763-780-9090
Highway 65; East on 153rd Avenue NE; North on Quamba Street; West on 154th Lane NE; Model on left
PARADE HOME $1,038,800


4 BED |



Our newest Bristol rambler-style home o ers exceptional family living in style. It is located on a 1.46-acre walkout lot with its own pond. The main level has lots of natural light, 3.5-season porch with a replace, grilling deck, gourmet kitchen, large center island, dinette, second bedroom and 3/4 bathroom, mudroom, and large great room with replace and built-ins. The owner’s suite has a large, customized closet that connects to the laundry room. The walkout lower level has a wet bar with separate pub table area, two more bedrooms, 3/4 bath, large family room with replace and lots of storage. Build with Gorham Custom Homes on your lot or ours.
HAM LAKE
2426 - 154TH AVENUE NE
Evergreen Estates
Homes from $750,000
gorhamcompanies.com
763-755-1717 | 612-325-3000
Highway 65; East on 153rd Avenue NE; Left on Urbank Street NE; Left on 154th Avenue NE;
4
6,579 SQ FT
Parent Custom Homes is excited to show you our latest two-story home with an amazing kitchen with two islands, extraordinary cabinets, large, vaulted porch with indoor/outdoor replace. Unique design with o ce and playroom located between the main and second floors. UL with four bedrooms, Jack-and-Jill bath, laundry and guest suite. LL bar area with 14’ high ceilings. Sport court, sauna, exercise room, pool, outdoor KT, patios with porcelain pavers. Oversized fourcar garage with epoxy floor. Plus all of the amenities and attention to detail you have come to expect from Parent Custom Homes. Brent and Brook Parent look forward to seeing you at this amazing home.
HAM LAKE
4764 - 146TH AVENUE NE
Hidden Forest East 3rd Addition
parentcustomhomes.com

612-282-2384 | 612-282-2380
Lexington Avenue; East on 143rd Avenue NE to T; Left on Opal Street NE; Left on 146th Avenue NE to home on the left
2,483 SQ FT



The 55+ Heims Lake Villas North association-maintained community offers detached, luxury villas overlooking Heims Lake and built by Guidance Homes, Inc. Quick access to I-35 and just 1/2 mile from Fairview Hospital. This custom-built, two-story home features a great floor plan with an open design, private owner’s suite with walk-in closet, second bedroom, bright sunroom, and covered front porch. Upper level boasts a third bedroom, spacious family room, and storage area. Two-car insulated and sheetrocked garage! Other lot and home packages with or without basements from $450K.
160
WYOMING

25408 FARMSTEAD LANE
Heims Lake Villas North Homes from $450,000 GuidanceHomes.com






651-419-8400
The Lancaster is an open concept, one-level-living floor plan. This home has two BRs and two BA, with a three-car garage. You have a private patio off the back of the home to enjoy nature all around.








4 BED |
3 BATH
3,591 SQ FT
Located in Forest Hills Preserve, a premier 55+ association-maintained community, this rustic, elegant home has views of Forest Lake and a gourmet kitchen with quartz countertops, cooktop, and center island. Open floor plan has a gas FPL, built-in cabinets, and arched entrance to an 11’x19’ sunroom with 14’ cedar tongue-and-groove vaulted ceiling and walls of windows! Owner’s suite has a walk-in tiled shower, double sink vanity, and spacious walk-in closet. Another BR, laundry, and mudroom complete the main level. LL has two more BRs, and FR with wet bar, billiards area, and electric fireplace. Maintenance-free deck and a three-car, insulated, and sheet-rocked garage included!
9948 - 211TH COURT N.
Forest Hills Preserve Homes from $600,000
GuidanceHomes.com

651-419-8400
Take Forest Boulevard/Highway 61 to Scandia Trail North/97; Left onto North Shore Trail; Left to 211th Street; Continue onto 211th Court N.
PARADE HOME $459,900

3 BED |
2.5 BATH
1,729 SQ FT
Homes by Lang Builders have the quality workmanship that makes our name stand out. Welcome to our newest model in Headwaters Place. This HOA, open-concept, one-level plan features vaulted ceilings, an owner’s suite with private bathroom and walk-in closet, two additional bedrooms, one and a half bathrooms, an oversized two-car garage, and a four-season porch. Beautiful slab-on-grade units for one-level living.

FOREST
20048 FITZGERALD TRAIL N. Cardinal Court
langbuilders.com
763-780-9090
Centennial School District! Eternity Homes’ Cape Cod plan is a mustsee! See the quality, compare floor plans, walk lots and start building your dream home today! Or ask about our move in ready homes!

I-35E; West on Main Street; Right on 20th Avenue N.; Left on 73rd Street; Right on Old Mill Road; Right on Laramee Lane to home
651-460-3043
3
Introducing a family-friendly two-story townhome. End-unit design with a great room, dining room, and kitchen on the first floor. Plus, an added patio. Upstairs, find a versatile loft and 3 spacious BRs.
LINO LAKES
2105 ADA DRIVE
Watermark Homes from $349,690 Lennar.com


952-373-0485



PARADE
4 BED | 3 BATH
2,271 SQ FT
Family-friendly two-story home. First floor o ers a great room, kitchen with nook, flex room, and mudroom with walk-in closet. Upstairs owner’s suite with walk-in closets, laundry and 3 secondary bedrooms.
LINO LAKES
2111 BALSAM WAY
Watermark Homes from $349,690 lennar.com



952-373-0485
PARADE
3 BED |



3 BATH
1,719 SQ FT
Lennar’s Watermark Community in Lino Lakes o ers a new two-story home with a lower level that’s full of possibilities and a main level designed for contemporary living with a dining room and kitchen.




LINO LAKES
7296 CRANE DRIVE
Watermark Homes from $349,690 Lennar.com 952-373-0485




From the intersection of I-35E and County Road 14; Head west on County Road 14; Right (north) on 21st Avenue N.; Follow and take a right onto Crane Drive
PARADE HOME $585,990
Introducing a family-friendly haven on a single floor. Great room, dining room, and kitchen. Includes three bedrooms for restful nights. O ers a four-season porch and a versatile loft.
7368 EMILY CIRCLE NE

Watermark
Homes from $349,690 Lennar.com 952-373-0485



2,692 SQ FT
This new family-friendly two-story townhome o ers an un nished basement for added flexibility. The rst floor features an open-plan layout that seamlessly connects the great room and dinning room.
LINO LAKES
7256 WATERMARK WAY
Watermark
Homes from $349,690 Lennar.com
Go west on Highway 14; Go right (north) onto 21st Avenue; Follow 21st Avenue north; Right onto Watermark Way; Model home is on the right












PARADE HOME $465,330
2 BED |
2 BATH
1,633 SQ FT
The Linai is a detached floor plan with two bedrooms and two bathrooms all on one with zero-clearance entry. No stairs inside or outside! Includes an oversized garage (24’ deep). A beautiful sunroom is located at the back of the house adding lots of light to the open-concept design. A spacious porch in front and a patio out back. Detached means privacy and association means freedom from lawn and snow care. Many selection choices! All this in a new neighborhood.
5 BED | 4.5 BATH
3,917 SQ FT
Nestled amongst wetlands and serene lakes, Nature’s Refuge provides an ideal retreat. The must-see Alexander o ers an open-concept layout, gourmet kitchen, beautiful views, and a fully nished lower level.
LINO LAKES
6771 IVYWOOD AVENUE
Eastside Villas
Homes from $454,900 ivyridgehomebuilders.com
763-286-7995
LINO LAKES
8013 GLENWOOD DRIVE
Nature’s Refuge Homes from $503,990 mihomes.com/paradeTC
612-425-3688
I-35W; North on County Highway 23/Lake Drive; Left on Main Street; Right on Glenwood Drive to model; In Google Maps enter “M/I Homes Nature’s Refuge”
STARTING AT $587,900 PARADE HOME $589,900



5 BED |
4 BATH
2,749 SQ FT
Creative Homes is showcasing the brand-new Alder! This home sits on a serene homesite in the nal phase of our Oakwood Ponds community. These single-family homesites in the nal phase are some of the best available in Blaine! The Alder features an open concept with tons of glass windows, a stunning kitchen, and a stone replace. Notable in the kitchen is the beautiful island, Samsung appliances, and large pantry. Also, on the main level is an in-law suite! Make your way upstairs to the incredible owner’s suite, two more bedrooms, and the laundry room. The walkout basement includes a spacious family room, game room, and fth bedroom.
BLAINE
12785 STUTZ COURT
Oakwood Ponds
Homes from $525,900 creativehomes.com
612-502-5106
North on I-35W; Exit on Lexington Avenue NE and go north; East on 125th Avenue NE; North on Lever Street; Right on 127th Lane NE; Model straight ahead
PARADE HOME $535,990
4 BED | 2.5 BATH
2,148 SQ FT
This new two-story, four-bedroom home is a part of the Lexington Cove community in Blaine, MN! The home features an open design throughout the rst floor with the great room, dining room, and kitchen.



BLAINE 4205 - 128TH LANE NE
Lexington Cove Homes from $425,990 lennar.com 952-373-0485

BY APPOINTMENT ONLY
Scan to Schedule Your Tour Time





PARADE HOME $618,000
5 BED | 3 BATH
3,002 SQ FT
Located in the heart of Blaine, the Tradition Series of two-story homes are now available! New homes feature upgraded options, signature kitchens, study/loft spaces, and walk-in closets.

BLAINE
13087 GHIA STREET NE
Lexington Waters Homes from $560,000 drhorton.com
612-482-4447
Go north on I-35W; Take Exit 33 for County Highway 17/Lexington Avenue; Left o the ramp; Go north for 2.5 miles. Model is o Lexington Ave. and 131st
PARADE HOME $481,990

4 BED | 2.5 BATH
2,495 SQ FT
Lexington Waters in Blaine features our new floor plan, The Hudson! This model home features four spacious BRs, UL loft and laundry, electric replace, and more! Come see our beautiful floor plan today!



BLAINE
13093 GHIA STREET NE
Lexington Waters Homes from $410,000 drhorton.com

612-482-4447
STARTING AT $551,900
PARADE HOME $649,900
3 BED |




3 BATH
3,290 SQ FT
Come home to our brand-new community, Lexington Waters! O ering association-maintained homes nestled in a perfect location, surrounded by mature trees and ponds. This main-level living home has an innovative layout with a gorgeous, contemporary feel. The kitchen, dining room and great room come together with a floor-to-ceiling shiplap replace, a breathtaking kitchen island and modern cabinetry. O the great room is the luxurious primary suite featuring a freestanding tub, dual sinks, and a spacious closet with convenient access to the laundry room. Also, notable in this home is the three-season porch, rosemary-painted den, and spacious walkout basement.
BLAINE
13105 GHIA COURT NE
Lexington Waters Homes from $525,900 creativehomes.com
612-502-5106
I-694; North on I-35W; Exit on Lexington Avenue NE; Turn left on Lexington; Right on 131st Avenue NE; Left into Ghia Court NE; Model on left
STARTING AT $699,900
PARADE HOME $724,900
5 BED | 4 BATH
3,970 SQ FT
Love sports? Eternity Homes’ Georgia Sport Court plan is a must-see! See the quality, compare floor plans, walk the lots, and start building your dream home today! Or ask about our move-in ready homes!

BLAINE
13004 MARMON STREET NE
Mill Pond Homes from $524,900 eternityhomesllc.com



651-460-3043
From 125th Avenue NE; Go north on Lever Street NE; Take right on 130th Lane NE; Turn right on Marmon Court NE; Home on the right
MN Lic. #BC638704
5 BED |

5 BATH
4,334 SQ FT
Our Ellingwood features a beautiful angled kitchen, study, sunroom, and great room with a stone replace and built-in entertainment center. The functional living space upstairs features an owner’s suite complete with walk-in double-headed tile shower, freestanding soaker tub, separate toilet room and oversized dual walk-in closet. Large bedrooms with private baths and a pass-through laundry room complete the design. The indoor sports zone provides hours of fun, especially in long winter months.
BLAINE
4601 - 131ST AVENUE NE
Homes from $750,000
jonathanhomesmn.com





763-438-2561
New three-level townhomes with a spacious KT, large center island and quartz countertops, bedroom suite with private bath and walk-in closet, plus an o ce space in lower level. Tour the model today!
BLAINE 3045A - 125TH AVENUE NE
Harpers Landing
Homes from $340,000
612-482-4447
From I-35W; Travel north on Lexington Avenue NE; Turn left on 125th Avenue NE; Right on Harpers Street NE; Left on 125th Avenue NE to model home
PARADE HOME $485,990

4 BED | 2.5 BATH
2,103 SQ FT
Located in the heart of Blaine, Harpers Landing o ers Express Select single-family homes! Blaine, Minnesota, is a vibrant city known for its welcoming community’s family-friendly atmosphere.


BLAINE
12595 EDISON CIRCLE NE
Harpers Landing Homes from $440,000 drhorton.com




612-482-4447
From I-35W; North on Lexington Avenue NE; Left on 125th Avenue NE; Right on Harpers Street NE; Left on 126th Avenue NE to model home
PARADE HOME $411,990

3
This elegant new two-story townhome o ers a versatile un nished basement, an open design among a great room, and a patio for outdoor enjoyment.

BLAINE 3445 - 109TH LANE NE
North Meadows
Homes from $337,990 lennar.com
952-373-0485











PARADE HOME $531,990
182
3 BED | 2 BATH 1,920 SQ FT
Showcasing the Danbury one-level-living villa with three bedrooms on the main level, large rectangular island, and spacious walk-in closet in owners’ suite.
BLAINE 10930 OKINAWA STREET NE North Meadows Homes from $337,990 lennar.com
952-373-0485

From I-35W; North on Lexington Avenue NE to 109th Avenue NE; Left (west) to Austin Street; Right into community and follow to model location
PARADE HOME $366,990

3 BED | 2.5 BATH 1,791 SQ FT
This new two-story townhome is an end unit featuring a contemporary design. The rst floor o ers a stylish open-concept layout among the great room, dining room, and kitchen.



BLAINE 11012 ZEST STREET NE, UNIT D North Meadows Homes from $337,990 lennar.com 952-373-0485






183

BY APPOINTMENT ONLY
PARADE HOME $391,990
3 BED | 2 BATH 1,906 SQ FT
This Je erson two-story townhome is an end unit featuring a family-friendly design. The rst floor showcases a great room for gatherings, a dining room for hosting dinners, and a kitchen.
BLAINE 11017 ZEST STREET NE, STE A. North Meadows Homes from $337,990 lennar.com 952-373-0485



BY APPOINTMENT ONLY



3 BED |
1.75 BATH
1,420 SQ FT
Our newest split-level plan, The Savanah! This beautiful home is located in the high-demand area of Blaine, close to The Lakes of Blaine, TPC, National Sports Center, and many stores and restaurants. The Savanah features three bedrooms, two bathrooms, a large kitchen with a center island, and a private owner’s bath! Builder has many lots available in the Blaine area.
BLAINE
716 - 114TH LANE NW
Je erson Ridge
rhbuildersmn.com
612-991-0983
3 BED |
2.5 BATH
2,268 SQ FT
The Camden has a loft-like feel with an open layout, a sleek kitchen with a large quartz island, modern electric replace in the family room, a nished recreation room, and so much more to explore!
BLAINE
8612 KENYON COURT, #D







Groveland Village
Homes from $349,990 mihomes.com/paradeTC
612-425-3688
Highway 65/Central Avenue to 85th Avenue NE; Go east; Left on Groveland Court NE; Left on Kenyon Court to model; In Google Maps enter “M/I Homes Groveland Village”
PARADE
2 BED | 2 BATH
1,899 SQ FT
The one-story Cedarwood II features a bright kitchen with large island, family room with gas replace, light- lled morning room, den with double doors and a spacious owner’s suite with private bath.


BLAINE
11297 FILLMORE STREET
Alexander Woods
Homes from $390,990 mihomes.com/ParadeTC
612-425-3688
Highway 65; West on 109th Avenue NE; Right on Ulysses Street NE; Left on 113th Avenue NE; Left on Fillmore Street to model; In Google Maps enter “M/I Homes Alexander Woods”




































187 Ovation Homes, LLC





STARTING AT $950,000
BED |
4,636 SQ FT
Midland Legacy Homes has 15 homesites in a secluded neighborhood located adjacent to Midland Hills Country Club and just 10 minutes to downtown Minneapolis. Many remaining homesites o er full-walkout lots and up to 3/4-acre of land with mature trees. All homes are custom drawn to your style and lifestyle. Ovation Homes has a completed model at Villas on McCarrons Lake, a short 10-minute drive from the site. Visit our sales center for more information.
Ovation Homes, LLC
3 BED |
3 BATH
2,772 SQ FT
READY-TO-BUILD LOCATION: VISIT THE SALES CENTER: 233 McCarrons Place W. Roseville, MN 55113


ROSEVILLE
2172 EUSTIS STREET N.
Midland Legacy Homes

651-321-4232
189
Hanson Builders, Inc.
Highway 36; South on Dale Street N.; East onto Roselawn Avenue W.; Take S. McCarrons Boulevard to Galtier Street; South on Galtier to McCarrons Place W. to sales center
The Villas on McCarrons Lake - detached townhomes with 250 feet of shoreline and a private dock on McCarrons Lake. Customize your plan and nishes to t your style and needs. Visit our model today!

ROSEVILLE
233 MCCARRONS PLACE W. Villa on McCarrons Lake
villasonmccarronslake.com 651-321-4232
Highway 36; South on Dale Street N.; East onto Roselawn Avenue W.; Take S. McCarrons Boulevard to Galtier Street; South on Galtier to McCarrons Place W.
MN Lic. #BC778486
MN Lic. #BC778486
LITTLE CANADA
Gervais Woods
|
191
Hill Farm Condominiums, LLC
$495,000 PARADE HOME $590,665

|
4123 ISAAC COURT



Vincent Estates Homes from $495,000
I-35E to Highway 96; West to Centerville Road; South on Centerville Road to County Road F; West to Isaac Court
NORTH OAKS
HILL FARM ROAD Hill Farm Condominiums
HillFarmCondos.com



651-317-4946
Townho e ode See you on the tour! 249 Townhomes & single family homes available The der 248 Townho e ode See you on the tour! 249 Townhomes & single family homes available The der 248 BC605657 DR Horton_E_FS23_DR.indd 1 7/21/23 10:58 PM



PARADE
3
2,147 SQ FT
Welcome to the newest development in the sought-after community of North Oaks Spring Farm! Incredible opportunity to custom build a gorgeous patio home or walkout villa. This luxurious patio home features all living facilities on one level, with exceptional quality and detail. This gorgeous property o ers an open floor plan with a gourmet KT featuring quartz counters, custom cabinetry, SS appliances and walk-in designer pantry. GR has 10’ ceiling with 3-sided gas FPL which leads you to the 4-season porch, DR has patio doors to lovely 3-season porch. The home also features an owners’ suite, second BR, bath, and study. Come see us today and let Wooddale build your dream!
NORTH OAKS
XX SPRING FARM ROAD
Spring Farm
wooddalebuilders.com


651-329-3102 | 612-363-3598
Highway 96 E.; Go to Centerville Road N.; Go to Spring Farm Road; Turn left; Home is on right
2
#BC345856
1,968 SQ FT
Pratt Homes is pleased to present our Spring eld model at Spring Farm, North Oaks’ newest community. A serene sanctuary set in the heart of nature conservation lands with access to miles of private trails and exclusive amenities such as Pleasant Lake Beach, tennis courts and more. Our model o ers the ultimate in single-level living featuring a stunning vaulted great room with arch top window framed by handcrafted beams. Gorgeous chef’s kitchen and pantry. Luxurious owner’s suite with spa bath. Second bedroom with 3/4 bath. Private o ce, laundry room, mudroom, utility room and three-car garage. Plus enjoy fresh air space in the charming three-season EZ Screen porch!

NORTH OAKS
XX SPRING FARM ROAD
Spring Farm
pratthomes.com 612-865-7243 | 651-503-5835




3 BED |



2.5 BATH
3,278 SQ FT
Architecturally designed luxury twinhome with open-concept floor plan, gourmet kitchen, four-season sunroom, large great room with replace and spacious owner’s suite. New neighborhood in North Oaks with access to private trails.
NORTH OAKS
XX SPRING FARM ROAD
Homes from $850,000
charlescudd.com
651-428-5109 | 612-333-8020
PARADE HOME $1,665,420
3 BED | 3 BATH 3,562 SQ FT
One-story home located in the newest North Oaks neighborhood of Anderson Woods. 3 BR, 3 BA, 3-car n. GAR, & 3,562 n. sq. ft. Mainfloor owner’s suite has designer closet & private spa BA w/soaking tub & large ceramic tile shower w/heated flooring. The gourmet chef’s KT features custom cabinetry, tiled backsplash, walk-in pantry, & quartz countertops. GR has 12’ ceilings, built-ins, & stone FPL. Main-floor den w/bypass doors. Four-season porch features walls of windows & ceiling detail with a patio door leading to the maintenance-free deck. The LL features bar, game area, built-in media center, exercise room, 2 BRs, & 3/4 BA. Enjoy spectacular backyard views.

NORTH OAKS
XX PONDVIEW TRAIL
Anderson Woods
wooddalebuilders.com

651-329-3102 | 952-345-0543
Highway 96 E.; Go onto Centerville Road N. to Pondview Trail
3 BED | 2.5 BATH
3,188 SQ FT
Pratt Homes presents our Pinewood model at Anderson Woods in North Oaks featuring impressive architectural detail and craftsmanship set in a serene sanctuary in the heart of nature conservation lands.


NORTH OAKS
XX PONDVIEW TRAIL
Anderson Woods
pratthomes.com
651-503-5835 | 612-865-7243
STARTING AT $905,000 PARADE HOME $1,141,000


5 BED | 4.5 BATH 3,243 SQ FT

Pratt Homes presents our Northstar model. Located in the storybook setting of Fable Hill in Hugo. This neighborhood borders Clearwater Creek Preserve with over 100 acres city-owned preserve.


HUGO
4632 FABLE ROAD N. Fable Hill Homes from $715,000 pratthomes.com

763-350-3752 | 651-429-8032
From Highway 61 N.; Turn left on 130th N.; Right on Europa Trail N.; Continue on Fable Hill Parkway N.; Right on Fable Road N. to model



Located in the private North Oaks community. The luxury single family villa homes in Anderson Woods is directly adjacent to the primary Conservation Area, 620 acres of pristine woods and wetlands with trails connecting to a private network of 30 miles of trails groomed for summer and winter use. Spring Farms offers both architecturally designed single family villas homes as well as attached architecturally designed townhomes. Both communities are association maintained as well as having access to the 900-acre conservation area which includes private trail systems & recreation for the family.
VILLA HOME PACKAGES STARTING AT $1.25M & TWINHOME PACKAGES STARTING AT $850,000
198
199
STARTING AT $770,000 PARADE HOME $925,000
3 BED | 2.5 BATH
3,463 SQ FT
Pratt Homes presents our St. Olaf villa model in the Villas at Fable Hill. Situated along the border of Clearwater Creek Preserve o ering privacy, space, and carefree lifestyle that you deserve.
HUGO
4654 FABLE ROAD N. Villas of Fable Hill Homes from $625,000 pratthomes.com
763-350-3752 | 651-432-8032


From Highway 61 N.; Turn left on 130th N..; Right on Europa Trail N.; Continue to Fable Hill Parkway N.; Right on Fable Road N. to model


STARTING AT $689,900 PARADE HOME $699,900





5 BED | 4 BATH
3,970 SQ FT
Love Sports? Eternity Home’s Georgia Sport Court plan is a must-see! See the quality, compare floor plans, walk the lots and start building your dream home today! Or ask about our move-in ready homes!


HUGO
16105 EUROPA AVENUE N. Oneka Place Homes from $599,900 eternityhomesllc.com
651-460-3043
From I-35E; East on Main St.; Left on 24th Ave. N./Elmcrest Ave. N.; Right on 158th St. N.; Left on Europa Avenue; Right on Ethan Trail N.; Left on Europa Avenue
5
3,468 SQ FT
The Beckett’s open layout includes a large family room with a sleek replace, a dining room, tech nook with built-in desk, a flex room, and a morning room to enjoy the views. The gourmet kitchen showcases an 8’ island, pecan-stained cabinetry, quartz countertops, gas cooktop and a walk-in pantry. The upper level features a vaulted owner’s suite with a walk-in shower, three spacious bedrooms, a Jack-and-Jill bath, additional full bath, and a laundry room.
4 BED | 3.5 BATH
2,598 SQ FT
HUGO
READY-TO-BUILD LOCATION: VISIT THE SALES CENTER: 15509 Goodview Trail N. Hugo, MN 55038

6219 - 157TH STREET N.
Oneka Shores
Homes from $377,990
mihomes.com/ParadeTC

612-425-3688


Hwy. 61; East on 147th Street N./ Oneka Lake Blvd.; Left on Goodview Ave. N; Left on Goodview Trail N. to model; In Google maps enter “M/I Homes Oneka Shores”
Designed with an open floor plan to foster connection and togetherness, the Bailey o ers a seamless flow between the family room, dining room, and kitchen. The modern kitchen features white cabinetry, white quartz countertops, a tile backsplash, and a 7’ island for casual meals. A vaulted ceiling extends through the dining room and family room to complement the open, airy layout, while the family room’s electric replace creates a cozy and inviting space to unwind. A short flight of stairs brings you to the owner’s suite with private bath, two additional bedrooms, and a full bath. The lower level features a nished recreation room, a fourth bedroom, and a 3⁄4 bath.
HUGO
15509 GOODVIEW TRAIL
Oneka Shores
Homes from $377,990 mihomes.com/paradeTC 612-425-3688
Hwy. 61; East on 147th St. N./Oneka Lake Blvd.; Left on Goodview Ave. N.; Left on Goodview Trail N. to model; In Google maps, enter “M/I Homes Oneka Shores”
PARADE OF HOMES NEIGHBORHOOD $377,990 – $749,990





Introducing Oneka Shores, a hidden gem nestled amongst lush wetlands, ponds, and towering trees on the serene west side of Oneka Lake. Located just o Highway 61, this highly anticipated community o ers a peaceful retreat with meandering trails and a future boardwalk to enjoy the lake views. In addition to its natural splendor, the community is part of the acclaimed White Bear Lake School District ISD 624. Whether you are looking to downsize or need additional space for your growing family, M/I Homes has the home for you at Oneka Shores. Choose from a diverse collection of association-maintained villas, single family homes, and twin homes ranging from 2-5 bedrooms, 2-5 bathrooms, and 1,3003,400 square feet. Visit entry #201 to learn about the opportunities that await you at Oneka Shores.
HUGO
15509 GOODVIEW TRAIL


Oneka Shores
Homes from $377,990 mihomes.com/onekashores 612-425-3688
2
Hwy. 61;
Blvd.;
St. N./Oneka
Ave.

PARADE HOME $598,700
2 BED |




2 BATH
1,890 SQ FT
Coming soon! Introducing the Cedarwood at Oneka Shores, a one-story home from the Hans Hagen Villa Collection. This home features two bedrooms, two bathrooms, a charming den with a bay window, and a light- lled morning room that walks out to the patio. In the kitchen you’ll nd white cabinetry, quartz countertops, a large island with a farmhouse sink, a walk-in pantry, and more. At the center of the home is the family room with a full-height stone replace and large windows to enjoy the wetland views. The serene owner’s bedroom features an en-suite bathroom and a large walk-in closet. Visit the M/I Homes’ model at 15509 Goodview Trail, Hugo to learn more.
HUGO
15680 GOODVIEW AVENUE
Oneka Shores Homes from $377,990 mihomes.com/paradeTC
612-425-3688
PARADE HOME $879,935
5 BED | 4.5 BATH
3,748 SQ FT
Explore the Birchwood a model in the award-winning Adelaide Landing neighborhood. This home o ers custom built-ins, a gourmet KT, tranquil owner’s suite, and a nished LL. Mahtomedi Schools ISD 832.
HUGO
13081 GENEVA AVENUE N.
Adelaide Landing - Heritage Collection Homes from $689,900 robertthomashomes.com 952-522-2023


I-494 to I-35E North; Exit 117 to Highway 96 E.; North on US-61; Right on 130th Street N.; Left on Geneva Avenue N. to model
PARADE HOME $774,700
4 BED | 3 BATH
3,185 SQ FT
The Sycamore is a one-story home with three BR plus a den, three BA, an open KT with walk-in pantry, a spacious family room with gas FPL and shiplap accents, and a covered deck to enjoy the wetland views.
HUGO
13886 GENEVA AVENUE N. Rice Lake Reserve Homes from $430,990 mihomes.com/ParadeTC 612-425-3688
PARADE HOME $444,990



3 BED | 2.5 BATH
1,976 SQ FT
This two-story home features a casually elegant design. Containing three bedrooms and two and a half bathrooms, it is perfect for a family. Plus, an added loft that adds versatility to the home.
OAKDALE
7499 UPPER 38TH STREET N.
Willowbrooke Homes from $353,560 lennar.com





952-373-0485
Turn right onto County Road 14; Turn right onto Hadley Avenue N.; Turn right onto Upper 36th Street N.; Arrive
PARADE HOME $349,990
3 BED | 3 BATH
1,690 SQ FT
This stunning three-story townhome provides space and privacy. Featuring three spacious bedrooms, including an owner’s suite with a full BA and walk-in closet. Plus, an added storage area for extra space.
OAKDALE
7570 - 38TH STREET
Willowbrooke Homes from $353,560 lennar.com 952-373-0485
ONLY Scan






PARADE HOME $374,990
3 BED | 3 BATH
2,007 SQ FT
Introducing this three-story, three-bedroom, and three-bath home w/a smart layout. Features storage space, two-bay garage, open-concept living area, GR, DR, KT, flex space with deck, and much more.
OAKDALE 7572 - 38TH STREET
Willowbrooke Homes from $353,560 lennar.com 952-373-0485






PARADE HOME $474,990


3 BED | 2 BATH

1,734 SQ FT

Welcome to the Willowbrooke community located in Oakdale, MN! This family-friendly new single-story home features three spacious bedrooms and o ers an un nished basement for extra convenience.


OAKDALE
7652 - 38TH STREET NE
Willowbrooke

Homes from $353,560 lennar.com
952-373-0485

In this highly sought-after community, the Hillcrest Sport plan is a Hanson Builders’ favorite. This home includes black Pella berglass windows, custom cabinetry throughout, heated floors, an oversized three-car garage, and a nished lower level with sport center, family room with a replace and wet-bar. This home also features site- nished enamel woodwork throughout. The community features a clubhouse, playground, and private community pool.
Showcasing our newest villa floor plan, The Elliot! This association-maintained home features a stunning floor-to-ceiling replace, tons of glass windows, and a beautiful kitchen.
LAKE ELMO
10845 - 38TH TRAIL N.



Legacy at North Star Homes from $591,000 hansonbuilders.com


952-270-0479 | 612-312-6062


From I-694/36 interchange; Go east on I-694; Exit 52B onto MN-36E; Turn right onto Lake Elmo Avenue N.; Drive about 2 miles to community on the right
10991 - 38TH COURT N. Legacy at North Star Homes from $540,900



PARADE HOME $999,855
4 BED | 3 BATH
3,333 SQ FT
Robert Thomas Homes is proud to present the Primrose model in the award-winning Robert Engstrom Companies neighborhood, Wildflower at Lake Elmo. With design direction provided by David Charlez Designs, this alley-loaded Garden Villa is a single-level living masterpiece you won’t want to miss. Stunning details are featured throughout such as a vaulted ceiling and a double-sided replace in the gathering room, waterfall kitchen island, and floor-to-ceiling windows. Wildflower at Lake Elmo is located on a 60-acre nature preserve with miles of trails, wetlands, and rolling hills. Association-provided lawn care and snow removal included. HOA fees apply.
LAKE ELMO
11473 WILDFLOWER DRIVE N. Wildflower at Lake Elmo Homes from $719,900
robertthomashomes.com
952-522-2023
Take MN-36 E. to Lake Elmo Avenue N.; Go south on Lake Elmo to 39th Street N.; Go east on 39th to Wildflower Drive N.; then North on Wildflower Drive
PARADE HOME $1,478,990


5 BED | 5 BATH
5,604 SQ FT
This large, two-story home is packed with luxury details. The rst floor features a dining room and tray ceiling, a gourmet kitchen with a dinette, and a study. On the second floor there are four bedrooms.

LAKE ELMO
1401 PALMER DRIVE Royal Club Homes from $686,990 lennar.com
952-373-0485
Keep right on I-94 E.; At Exit 253 head toward County Road 15; Turn left onto MN-95; Turn left onto 10th Street N.; Turn right on Palmer Drive N.
Financing options provided by


4 BED | 3.5 BATH
3,848 SQ FT

This beautiful two-story home is a part of the Royal Club community in Lake Elmo, MN. The layout is ideal for entertaining guests and casual moments with family. Four spacious bedrooms and a loft.




LAKE ELMO
1476 PALMER DRIVE N. Royal Club Homes from $789,990 lennar.com


952-373-0485



BY APPOINTMENT ONLY
Your Tour Time
214
Lennar


2 BED | 3 BATH
2,008 SQ FT
Welcome to the Royal Club Enclave Villas! This new single-story home showcases a modern design with a versatile lower level. A key feature is the open-concept floor plan throughout the main level.
LAKE ELMO
1491 PALMER DRIVE Royal Club Homes from $789,990 lennar.com
PARADE HOME $849,739

3 BED |
2 BATH
1,871 SQ FT
Welcome home to TJB Homes exciting new one-level-living popular


Jenna plan in the no-snow, no-mow Royal Golf community. Warm and welcoming main-level living with stunning family room with beamed ceiling details. All open to custom-designed kitchen and informal dining. Owner’s en-suite and additional two bedrooms are all on one level! Spacious laundry and mudroom with walk-in closet. 0.33 of an acre all maintained by association. Complete with spacious three-car garage. 11 lots. Golf community with other homesites and custom plans available to meet all your needs. TJB Homes will build on your lot in Minnesota or Western Wisconsin. Fully landscaped lot.
LAKE ELMO
11291 LATROBE LANE
Royal Golf Club Homes from $800,000 tjbhomes.com

612-987-8272 | 763-286-6868





PARADE
5 BED | 5 BATH
4,720 SQ FT
Located in The Hills of Spring Creek, this Derrick Custom Home two-story presents over 4,700 square feet of living space. Featuring Derrick handcrafted cabinetry, site- nished millwork, and Andersen Windows, this home has all the luxuries Derrick Custom Homes is known for. The open main level includes a formal dining room, elegant o ce, and a four-season porch that overlooks preserved open space. The upper level spotlights four bedrooms, three bathrooms, a laundry room and a loft area. The nished lower level rounds o this home with a fth bedroom and bath, wet bar, game area, and exercise room. Do not miss out on this one of a kind development!
STILLWATER
14329 - 47TH STREET COVE N.




Hills of Spring Creek
Homes from $800,000 derrickcustomhomes.com
612-834-3040 | 715-246-2320
Highway 36; South on N. Osgood Avenue; West on 47th Street N.; South on 47th Street Cove N.
PARADE HOME $729,900

4 BED |
3 BATH
2,529 SQ FT
Stunning one-level home in established Liberty on the Lake. Open plan with quartz kitchen and large island, vaulted ceilings, modern replace, built-ins, and main-floor laundry. Move-in ready!
STILLWATER
3823 TENDING GREEN
Liberty West
gagnecustomhomes.com
651-276-8555 | 651-319-6968
Highway 36 to Stillwater; Exit Manning Avenue N./County Road 15; North on Manning; Right on Liberty Avenue N.; Left on Homeward Way; Left on Heritage Avenue
4,182 SQ FT
The Rachel is Hanson Builders’ latest one-level home design that is going to WOW you! Immediately, you’ll notice the eye-catching front elevation with a four-car garage, black Pella windows, and a cozy front porch. Upon entering, you’ll notice the open and spacious feeling of the 10-foot kitchen ceilings on the main floor, oversized center island, and a large prep pantry that is tucked behind the main kitchen which features an additional sink and plenty of storage! This home also includes a nished lower level with a wet bar, three large bedrooms with walk-in closets, a large family room, and game area.
STILLWATER
4829 ORDELL TRAIL N.

Hills of Spring Creek Homes from $850,000 hansonbuilders.com

952-270-0479 | 763-286-2509
Highway 36; South on Osgood Avenue; West into the community













PARADE HOME $574,900
3 BED |











3 BATH
2,167 SQ FT
Villa features main-floor living with a two-story foyer including 9’ high-vaulted ceilings on the main floor. This is an association-maintained neighborhood which includes snow removal, lawn care and an irrigation system. This development features 24 villas that are all designed and nished uniquely di erent. This 3-BR, 3-BA custom home features high-end nishes including Bosch appliances, Andersen Windows, and Hardie Siding. Only four lots remain in this great location! Just minutes from downtown Stillwater, Oak Park Heights shopping and St. Croix Prep Academy. Miles of walking and bike paths to the large Barkers Alps park in Bayport and to the St. Croix River.
BAYPORT
632 INSPIRATION PLACE

Villas of Inspiration
landuccihomes.com




651-894-2582
Stagecoach to Inspiration Parkway
S.; Go east to Inspiration Place; Turn left at second intersection; Model house on left side

PARADE HOME $1,520,000
3 BED | 2.5 BATH
3,513 SQ FT
Wittstock Builders presents White Pine Ridge, an exclusive development featuring a sophisticated slab-on-grade rambler. This home spans a generous 3,513 sq. ft. within a serene natural environment. The remarkable exterior comprises a custom facade and detached garage. Inside, varied ceiling heights lend character to every room. The main level features an open-concept living area with a wood-burning replace and a gourmet kitchen with custom cabinets, perfect for versatile dining experiences. A sports court caters to families and sports enthusiasts while the three-season porch o ers a relaxing retreat. Discover luxury, convenience, and style all under one roof.
SOMERSET, WI
336 - 172ND AVENUE
White Pine Ridge
wittstockbuilders.com
715-760-0223
Take Highway 35/64 from MN to WI; Take Exit 6 for Somerset; Take a left onto 172nd Avenue; Continue into White Pine Ridge; Destination is on the right
STARTING AT $389,900
5 BED | 3 BATH 2,579 SQ FT
Capstone Homes is proud to present our newest communities in Wisconsin — Winesap. This beautiful neighborhood boasts a variety of family-favorite floor plans and the quality and value that you’ve grown to expect from this locally owned company. Call or visit us today.


STARTING AT $313,200 PARADE HOME $459,900



SOMERSET, WI
400 BRUCE LARSON WAY Winesap
Homes from $379,900 capstonehomes-mn.com

763-898-0239
Take Highway 35 to County 64; North to Sunrise Drive; South to Bruce Larson Way; West to home

5 BED | 3 BATH
2,230 SQ FT
Three bedrooms on main level includes spacious owner’s BR, walk-in closet, and private full bath. Vaulted ceilings in living room provide for an open layout. Two bedrooms and one bath in nished lower level.
SOMERSET, WI
318 ASPEN DRIVE River Hills



gateway-homes.com








715-247-1944 | 651-276-6734
Take the exit toward WI-35 N./ Somerset/Osceola; Turn right on County Road C; Then left on Aspen Drive to home

# DC-032200249

STARTING AT $329,900 PARADE HOME $354,900




3 BED | 2.5 BATH
1,535 SQ FT
Now selling beautiful single-family homes in Meadow Crossing! These brand-new single-family homes offer our Creative Homes’ quality at an affordable price point. Come see for yourself the gorgeous Arlow with three bedrooms, two-and-a-half bathrooms and an awesome open layout. As you make your way inside, you’ll be greeted by an open railing staircase heading upstairs to the three bedrooms. Through the foyer hallway, you’ll pass a powder bath before entering into the kitchen, dining, and great room space. Notable is the stunning kitchen island, cozy fireplace, and Samsung appliances.
NEW RICHMOND, WI
1305 VIOLET STREET
Meadow Crossing Homes from $306,900
creativehomes.com

612-502-5106
From
PARADE HOME
2 BED | 2.5 BATH
2,250 SQ FT
C&E Wurzer Builders welcomes you to true contemporary comfort in this architecturally inspired haven. A combination of neutral colors and inspiring texture culminates in a beautiful blend of industrial and natural elements. Created in the true essence of “form follows function,” this home features essentials plus custom design elements. Perfectly placed windows allow the beauty and energy of the riverside views and trees to flow effortlessly to the interior. Beautiful built-ins ensure continuity of a theme of pure appreciation for space. Practical elements include LP Smart Side, elevator from first to second floor, dry-stacked stone exterior accents, and metal railings.
HUDSON, WI
1007 FIRST STREET
651-342-3697 | 715-563-4880
PARADE HOME $700,000
5 BED | 2.75 BATH
3,210 SQ FT
A beautiful rambler with vaulted ceilings and large windows to look out at all the beautiful views on 3.05 acres just outside Hudson, WI. The convenience of city amenities but with the peace and space of country living. This rambler includes a gas fireplace and laundry on the main level. Enjoy the beautiful layout with a private owner’s suite on its own side of the home including a tiled shower and two walk-in closets. You’ll love all the additional space with the finished basement including a wet bar and bonus room.
HUDSON, WI
899 GAVIN PASS Hunter Hills
OeveringHomes.com




651-307-1831 | 715-243-0001
PARADE HOME
2 BED | 2 BATH
1,634 SQ FT
We welcome you to Park Place Village, a premier simply living community designed and constructed for successful individuals like yourself who value a simpler lifestyle. Experience a life of ease and comfort in stunning Hudson, Wisconsin with numerous homes yet to be built in this association-maintained community. Divine Custom Homes has crafted remarkable properties with energy efficiency, natural light, and private outdoor areas in mind. Our team of experts will help you select from a variety of exquisite finishes and options to bring your vision to life.
HUDSON, WI
2221 SHARON LANE
Park Place Village
divinecustomhome.com/parkplace-village 833-333-4873





FROM $300,000–$550,000
Enjoy Derrick Homes’ new luxury twinhome development. Thompson Heights features two plans, Sockeye and Coho, both with slab-ongrade and lower-level floor plan capabilities. This HOA-controlled development will take care of your lawncare and snow removal so you can enjoy more of life. Located near Kilkarney Golf Course, it is just minutes from the St. Croix River. Twinhome units starting in the $300Ks.

NEIGHBORHOOD LOCATION:
RIVER FALLS, WI
PAULSON ROAD AND RADIO DRIVE
Thompson Heights
derrickcustomhomes.com

715-760-1189 | 715-246-2320
VISIT THE SALES CENTER:
2951 Thompson Drive
River Falls, WI 54022

From I-94; South on I-35; Exit onto Radio Drive; Right onto Radio Drive; Left onto Paulson Road; Development is on the right
4 BED |
3 BATH
2,502 SQ FT
This spacious Monterey II two-story home on a walkout lot welcomes with a large foyer and o ce located o the entry for a convenient work-from-home experience. Great room with gas replace opens to dining room and kitchen with island and walk-in pantry giving a great multifunctional space. Large mudroom and 1/2 bath just steps away for ease of use. Upper level has a unique staircase to loft and bedrooms and elegant owner’s suite with 3/4 bath, large double-sink vanity and large walk-in closet. Second floor has additional three bedrooms, laundry room and full bath with large double-sink vanity for everyone’s convenience. Many upgrades throughout the home!
RIVER FALLS, WI
614 WESTWOOD DRIVE
Highview Meadows
612-249-7150 | 952-469-8800
From Highway 35; East on East Division Street; Right on Meadows Drive; Right on Williams Avenue; Right on Westwood Drive
3
STARTING AT $1,400,000
3
2,799 SQ FT
This St. Croix walkout plan has very spacious and sun- lled main and lower levels. Main level has an o ce, two bedrooms and laundry making this home fantastic for those wanting their living space on one level. Kitchen has large center island, large pantry with upgraded shelving, black stainless steel appliances. Owner’s bedroom has a private bath and walk-in-closet. Lower level has large family room with gas replace, additional bedroom, 3/4 bath and large un nished areas that could be used in so many ways other than storage. Many other upgrades throughout the home. Available lots give the ability to build and customize your home.
PRESCOTT, WI
473 MARK TWAIN BOULEVARD
Great Rivers Replat
651-249-7150 | 952-469-8800
Highway 35; East on Hollister Avenue; North on Sea Wing Boulevard; West on Delta Queen Avenue to Mark Twain Boulevard; Home on NW corner
PARADE HOME $2,499,000
4,997 SQ FT
Welcome home to TJB Homes custom designed walkout rambler with some of the best views in Afton Creek Preserve. Bright and airy open-concept plan featuring a great room with gas replace and beamed vault throughout. Gourmet kitchen has custom-designed cabinet features with large island, spacious perimeter countertops, large walk-in pantry. Not to be missed flex/o ce space! Open sun- lled spaces with walls of Andersen windows and access to a four-track porch with replace. In the lower level, two more bedrooms, a great family entertainment space, custom bar, and so many architectural details throughout! Golf Simulator room and secret room in lower level. We will build on your lot in MN or in WI.
AFTON
5671 OAKRIDGE TRAIL S.
Afton Creek Preserve Homes from $1,500,000
tjbhomes.com
763-780-2944 | 763-286-6868
I-94; Exit to Manning Avenue; South on Manning Avenue S.; East on 50th Street S.; South on Odell Avenue S. to Oakridge Trail S.
This new two-story home boasts an open design on the rst floor with a spacious great room, dining room and kitchen. Upstairs, you’ll nd three secondary bedrooms and a lavish owner’s suite.
WOODBURY
968 SPANCIL HILL DRIVE Spancil Hill Homes from $599,990 lennar.com
952-373-0485
I-94 to Woodbury Drive/County Road 19; Left on Eastview Rd.; Follow till you cross over Settler Ridge Parkway; Right on Spancil Hill Rd. (Behind Eagle Brook)
This new two-story home is a family-friendly haven. The rst floor features a formal dining room, casual breakfast nook, kitchen, inviting great room, and versatile study.
WOODBURY
10598 BLACKMOOR ROAD
East Pointe Homes from $366,990 lennar.com 952-373-0485









This new two-story townhome design combines comfort and convenience. The main level features a family room for shared moments, a dining room for memorable meals and a kitchen for adventurous cooks.






WOODBURY 5019 USEPPA TRAIL East Pointe Homes from $366,990 lennar.com
952-373-0485
PARADE HOME $484,990 4


This new two-story home showcases an appealing contemporary design. At the heart of the rst floor is the great room, which connects in an open-plan layout with the dining room and modern kitchen.

WOODBURY 5022 USEPPA TRAIL East Pointe Homes from $366,990 lennar.com
952-373-0485
From I-494; Slight right onto Maxwell Avenue; At the tra c circles stay straight on Bailey Road; Right on Highway 19; Take 3rd exit at the tra c circle
4 BED | 2.5 BATH
2,814 SQ FT
Visit the Huntington model in our newest community in Waypointe of Woodbury. This light- lled home is complete with gourmet KT and private o ce. Upper level o ers 4 BD, 2 BA, and bonus room. ISD 833

WOODBURY
5070 AIRLAKE DRAW Waypointe of Woodbury Homes from $579,900 robertthomashomes.com


952-522-2023
From I-494: Exit Lake Road; Go east to Highway 19/Woodbury Drive; Right (south) to Dale Road; Left (east) into Waypointe of Woodbury neighborhood
4 BED | 2.5 BATH
2,875 SQ FT
The Brook eld model is located in Waypointe of Woodbury. This floor plan o ers an open KT design, large gathering room w/gas FPL, floorto-ceiling windows, and bonus room. Woodbury ISD 833 Schools.
WOODBURY
5068 AIRLAKE DRAW Waypointe of Woodbury Homes from $579,900 robertthomashomes.com




952-522-2023
From I-494: Exit Lake Road; Go east to Highway 19/Woodbury Drive; Right (south) to Dale Road; Left (east) into Waypointe of Woodbury neighborhood
Financing options provided by

NMLS#286998


STARTING AT $779,000
PARADE HOME $779,000
4 BED | 3.5 BATH
2,860 SQ FT
Minnesota Modern in Hartung Farm a cul-de-sac neighborhood. Open floor plan, lots of Pella windows, 1/2 acre homesite, 4 BD, 4 BA, o ce, gourmet KT, quartz counters, maple cabinetry, LVP main level.



WOODBURY
5028 AIRLAKE DRAW
Hartung Farm
Homes from $700,000 michaelleeinc.com
651-271-9340 | 651-731-2345

STARTING AT $1,400,000
PARADE HOME $1,400,000
5 BED |
4.5 BATH
5,387 SQ FT
Aster Landing, with 25 custom homes, presents this 5,387-square-foot model with Andersen windows that focus on a wonderful backdrop. Boasting ve bedrooms, ve bathrooms, a gourmet kitchen, an o ce, and a 32’ wide four-season porch. The lower level has the fth bedroom, rec. room, wet bar, exercise, and an indoor sports gym. The upper level has four bedrooms and three bathrooms including a tremendous owner’s bedroom, bath, and closet. Take a peek at other custom homes designed and built by Kootenia. We also do o site builds and teardowns.
WOODBURY
9592 IRON HORSE ROAD
Aster Landing
Homes from $1,000,000 kooteniahomes.com




612-282-0920 | 651-731-2345
From Woodbury Drive; South to Dale Road; West to Iron Horse Road; North to model home

STARTING AT $674,900
PARADE HOME $899,900


5 BED | 4.5 BATH
3,821 SQ FT
Boasting 5 BR and 4.5 BA, this well-appointed home o ers an abundance of living opportunities across three floors. Briarcroft is located in the highly acclaimed South Washington School District.
WOODBURY
10261 ARROWWOOD PATH
Briarcroft
Homes from $589,900 creativehomes.com
612-502-5106
PARADE HOME $659,900
3 BED | 3 BATH
2,842 SQ FT
Distinctive Design Build proudly presents this villa home in Woodbury, with the quality craftsmanship, inspiring design, high-end amenities, and spaces for today’s families that you can always expect from a Distinctive home. This home features a main-floor owner’s suite, walk-in pantry, smart siding. Lawn care and snow removal are included. There are many lots and plans to choose from. Visit us on the tour, and discover the “Distinctive di erence.”
WOODBURY
5019 DALE RIDGE ROAD
Summerhill of Woodbury
distinctivedesignbuildllc.com
651-344-7151



PARADE
5 BED | 3 BATH
3,003 SQ FT
Copper Hills community in Woodbury is near walking paths, city parks, and wetlands! Floor plans include two-story 4- to 5-BR homes with o ce spaces, lofts, upper laundry, and more. See you on the tour!

WOODBURY
8224 SADDLE TRAIL


Copper Hills
Homes from $590,000 drhorton.com
612-482-4447
PARADE HOME $404,990
3
New Copper Hills townhomes in Woodbury o er 3-4 bedrooms, optional replaces, upper-level o ces, and laundry! Copper Hills is close to several walking trails and parks. Start your new home search!

WOODBURY 5026 STABLE VIEW DRIVE
Copper Hills Homes from $390,000 drhorton.com

612-482-4447
From I-494W, take Bailey Road Exit; Continue to Radio Drive; Right turn on Dale Road; Right turn onto Stable View Drive to models
PARADE HOME $549,990
4 BED | 3.5 BATH
2,402 SQ FT
Express Premier raised-ranch homes are now available in Woodbury! New four or ve bedroom homes feature main-level vaulted ceiling, study, luxury bedroom suite, three-car garage, and nished LL.

WOODBURY
8236 SADDLE TRAIL
Copper Hills
Homes from $460,000 drhorton.com
612-482-4447
From I-494, take Bailey Road east to Radio Drive; Travel south to Dale Road; Travel east to Stable View Drive and
PARADE HOME $649,990


4 BED | 2.5 BATH
2,692 SQ FT
This spacious two-story home features an open-concept layout with the kitchen overlooking the dining room and great room. The rstfloor flex room o ers endless possibilities.
WOODBURY 4763 MARTINGALE DRIVE
Bridlewood Farms Homes from $496,990 lennar.com





952-373-0485
US-61; Take Exit 130 B to Bailey Road; At 2nd tra c circle, take 1st exit to Radio Drive; Turn left on Baily Lake Road; Then left on Martingale Drive













Want to be the first to live in a brand-new neighborhood? Check out the Coming Soon entries. These entries are new neighborhoods without any homes built yet. Visit the on- or off-site sales center to learn more about the area and the amenities and get started reserving your
PARADE HOME $879,900


3 BED |
3 BATH
3,175 SQ FT
Looking for main-level living? Pop into the Palmer. The award-winning plan perfectly encompasses timeless design with arches throughout while o ering the functionality of a stunning one-story home. The main-level owner’s suite is a 24/7 staycation with a tile shower, boxvault ceiling and large walk-in closet. A spacious flex room, mudroom, and laundry are also on the main level. The sunroom leads to the grill deck. The great room includes a floor-to-ceiling stone replace with built-ins and a mantle. Two bedrooms, a full bath, and a rec. room with a floor-to-ceiling replace wrapped in shiplap and a stone surround give the lower level a cozy feel.
WOODBURY
4225 GABLE LANE
Arbor Ridge
Homes from $614,032 stonegatebuilders.com
651-413-9096
STARTING AT $790,000
PARADE HOME $981,000
4 BED |


5 BATH
4,580 SQ FT
In this highly sought-after community, the Hillcrest Sport plan is a Hanson Builders’ favorite. This home includes black Pella berglass windows, custom cabinetry throughout, heated floors, an oversized three-car garage, and a nished lower level with sport center, family room with a replace, and wet-bar. This home also features site- nished enamel woodwork throughout. The community features a clubhouse, playground, and private community pool.
WOODBURY
4226 GABLE LANE
Arbor Ridge
Homes from $652,000 hansonbuilders.com
612-702-9003 | 763-286-2509
From Bailey Road; Go south on Radio Drive; Go west on Hargis Parkway; Model is on the corner of Hargis Parkway and Gable Lane
















PARADE HOME $478,990

4 BED | 2.5 BATH
2,179 SQ FT
Hinton Woods o ers two-story homes located in the heart of Cottage Grove with pond views! This community has beautiful homesites and o ers new floor plans available as part of our Express series!
COTTAGE GROVE
6706 PINE ARBOR LANE
Hinton Woods Homes from $440,000 drhorton.com

612-482-4447



Highway
Street
PARADE HOME $649,900
3 BED | 3 BATH
2,661 SQ FT
Explore our fresh, new East collection, priced to meet your needs without sacri cing style or space. With pops of warm, eclectic nishes and brushed gold accents scattered throughout the home, the attractive Eleanor floor plan features nishes from our designer-curated Uptown Luxe package which enhances the ambiance of your home’s most lived-in spaces. The main level marble replace surround is a focal point and the perfect area for hosting family and friends. The kitchen features quartz countertops, a walk-in pantry and large windows. An owner’s suite with a tile shower and two closets is located on the upper level along with two other bedrooms and a full bath.
COTTAGE GROVE
6151 HARKNESS LANE S.
The Edge at Eastbrooke Homes from $520,390 stonegatebuilders.com

651-273-1120
on
PARADE HOME $379,990
3 BED | 2.5 BATH
1,687 SQ FT
Hinton Woods in Cottage Grove o ers new 3-bedroom townhomes featuring well-appointed kitchens, optional replaces, luxury bedroom suites with private baths, upper-level laundry, and so much more!




COTTAGE GROVE
6665 HINTERLAND TRAIL
Hinton Woods Homes from $350,000 drhorton.com
612-482-4447
PARADE HOME $784,990



4 BED |





3 BATH
2,692 SQ FT
Welcome to Lennar at Calarosa Discovery located in Cottage Grove, MN! This spacious two-story home features an open-concept layout with the kitchen overlooking the dining room and great room.



COTTAGE GROVE
6087 INSPIRE AVENUE S.
Calarosa Discovery
Homes from $432,990
lennar.com
952-373-0485
PARADE HOME $675,000
3 BED | 2.5 BATH
2,604 SQ FT

Villa-style homes designed for main-floor living. Home has a Corian Quartz KT, screen porch, Andersen Windows, and solid-core interior doors. Choose your lot and customize your plan for your needs.

COTTAGE GROVE
6233 JANERO AVENUE S.
Cardinal Reserve
Homes from $599,000
651-739-8033
Take Radio Drive; East on Military Road; Left on Janero Avenue S.
PARADE HOME $569,990
3 BED | 2 BATH
1,862 SQ FT
This new single-story home showcases a contemporary design. It features an open-plan layout among the great room, dining room, and kitchen in addition to a mudroom with a walk-in closet.



COTTAGE GROVE
6296 INSPIRE AVENUE
Calarosa Villas
Homes from $432,990
lennar.com
952-373-0485
US-10; Take Exit 130B towards Bailey Avenue; Right on Military Road; Keep right towards Radio Drive; Left on 65th St. S.; Left on Inspire Ct.; Left on 63rd
PARADE HOME $589,700
4 BED | 3.5 BATH
3,030 SQ FT
The end-unit Nokomis is nothing short of amazing! This exquisite townhome features a main-level owner’s suite, a two-story family room, a flex room, the UL has 2 BR and a loft, and a nished LL.

COTTAGE GROVE
9750 - 65TH STREET S. Woodward Ponds Homes from $346,990 mihomes.com/paradeTC
612-425-3688
South on Military Road; Right on Jamaica Avenue S.; Left on Ravine Pkwy.; Right on Joliet Avenue S. to model; In Google Maps enter “M/I Homes Woodward Ponds”



New 3-BR, 3-BA, end-unit townhome built by Minnesota’s oldest family-owned builder: Donnay Homes. High-quality craftsmanship that you deserve and expect. All bedrooms are in the same level with a second-floor laundry. Owners’ suite includes a large walk-in closet and a private full attached bath with a separate tub and shower! Main level features an amazing FR with a vaulted ceiling and a beautiful replace to warm up during the MN winters. Kitchen is large and open. A walkin pantry o ers plenty of space. End units include an 8’x7’ patio o the dining area which will be great for outdoor entertaining. Make the home of your dreams. Don’t miss this opportunity!
COTTAGE GROVE
6812 JODY AVENUE S.
Glacial Valley Estates Homes from $349,900 donnayhomes.com
612-817-3449 | 612-919-4085
From I-494; South on Highway 61; East on 70th Street S.; North on Keats Avenue N.(Washington County Highway 19 or Woodbury Drive); West on Jody Avenue S.
PARADE HOME $449,990
4 BED | 2 BATH

1,821 SQ FT
This new two-story home o ers a nished lower-level bonus room and bedroom. Enjoy the great room and dining room, a high-end kitchen, and front porch. Upstairs is where the spacious bedrooms sit.

COTTAGE GROVE
6714 - 91ST STREET S.
Summers Landing West Homes from $495,410 lennar.com 952-373-0485
PARADE HOME $639,990






4 BED | 4 BATH
2,786 SQ FT
This two-story, single-family home features an open-concept floor plan with a great room, large kitchen, dining room, mudroom, and o ce space on the rst floor. The second floor includes three BRs.
COTTAGE GROVE
6726 - 93RD STREET S. Summers Landing West Homes from $495,410 lennar.com 952-373-0485






Each Saturday during the tour, join us at a different development across the metro for pop-up celebrations. Wake up with coffee carts, community yoga, family activities, and puppy parties! Find all the event details at ParadeofHomes.org
















PARADE HOME $2,600,000
4 BED |



4.5 BATH
5,515 SQ FT
Come see this stunning rambler-style custom-built home with a spacious bonus room set back in a private, wooded lot. View its desirable main-floor primary suite, white oak hardwood floors, tile bathrooms, top-of-the-line appliances and custom cabinetry. Beautiful wallpaper accents, a shiplap white oak wall and vaulted GR with an oak ridge beam add to this home’s rich character. The LL includes an exercise room and entertainment area featuring a custom enameled walk-up bar complete with a Zellige tile backdrop and illuminated floating shelves. Enjoy peaceful views from the EZ screen porch w/FPL o the dining room. An elegant, craftsman-style home worth touring!
MENDOTA HEIGHTS
694 WENTWORTH AVENUE
mandmquality.com
952-797-3720
260
STARTING AT $1,600,000
PARADE HOME $1,649,000
5 BED | 5 BATH
4,123 SQ FT
This two-story family home features an open main level, upper level ve bedrooms with a loft area, and a hosting-ready lower level! Andersen Windows, James Hardie exterior, LL bar, and so much more!
EAGAN
4010 HAVEN WOODS COURT
Haven Woods
customonehomesmn.com


651-459-1972 | 651-274-1403
PARADE HOME $1,850,000
4 BED | 3 BATH
3,730 SQ FT
This four-bedroom, three-bath home is nestled on a large lot and features charming, life-friendly details around every corner. The main level is stunning with large kitchen island, walk-in pantry, owner’s suite, o ce and charming screened porch. Lower level is great for entertaining. Large oversized three-car garage. Lot is private with long driveway and mature trees. A wonderful place to call home!
MENDOTA HEIGHTS
1770 DODD ROAD
sd-customhomes.com



651-248-8494
PARADE HOME $2,980,000

5 BED | 6+ BATH
5,159 SQ FT
Set privately on a 3.25-acre wooded property, this contemporary design combines beauty and functionality with a striking minimalist approach. The interior blends crisp whites and clean lines with warm textural elements for an appealing color palette. The thoughtfully designed floor plan showcases a 19-ft. vaulted GR with open glass catwalk, gourmet KT with custom rift-cut white oak cabinetry, and specialty crafted spaces throughout. Indoor-outdoor entertaining was emphasized in the design, seamlessly integrating the outdoor living spaces, pool and patios. From the private owner’s wing on the main level to the elevated nishes, this home is a true showcase.
EAGAN 704 NAUVOO LANE
homesbytradition.com
612-363-6034 | 612-703-5130















STARTING AT $1,300,000 PARADE HOME $1,319,000
5 BED | 5 BATH
3,756 SQ FT
This two-story home is sure to impress! 5 BR, 5 BA, 3-car GAR, located in the sought-after Amberwood Community in Inver Grove Heights in ISD196. Andersen Windows, gorgeous Calcutta counters, and more!
INVER GROVE HEIGHTS
11729 AZURE CIRCLE




Amberwood
customonehomesmn.com
651-459-1972 | 651-894-2466
PARADE HOME $729,800


4 BED |
3 BATH
2,463 SQ FT
Peltier Reserve o ers many lot sizes among rolling hills and beautiful topography in desirable Eagan 196 School District. This home o ers 4 BR, 3 BA, FPL, beautiful KT, loft and luxury owners’ suite.
INVER GROVE HEIGHTS
7483 AGATE TRAIL Peltier Reserve



612-282-7855 | 952-469-8800
PARADE HOME $719,900
3 BED | 2.5 BATH
3,148 SQ FT
Distinctive Design Build is proud to present our new model in Peltier Reserve. Quality craftsmanship, inspiring design with high-end amenities throughout, and spaces for today’s families that you can always expect from a Distinctive home. Primary bedroom and laundry on the main level. Open concept with great room and gourmet kitchen are great for entertaining. Large windows for plenty of natural light. Lot overlooks nature area with serene view of mature trees. Lower level features additional two bedrooms, full bath, recreation room, and game room along with ample storage. Visit us on the tour and discover the “Distinctive di erence.”
INVER GROVE HEIGHTS
7442 AGATE TRAIL
Peltier Reserve
distinctivedesignbuildllc.com
651-344-7151
Trail;
Trail;
5 BED |
4,826 SQ FT
Highlands at Settler’s Ridge in Inver Grove Heights features our Snelling plan with an open-concept main level, gourmet kitchen, and formal dining room.


INVER GROVE HEIGHTS
7214 AUBURN LANE
Highlands at Settler’s Ridge Homes from $621,990 lennar.com 952-373-0485


I-494,

1,593 SQ FT
Stunning private lot backed up to nature and wetlands, walkout lower level. 3 BR, 2 BA, open floor plan. Large center island ideal for entertaining. Custom style cabinets and millwork throughout.
INVER GROVE HEIGHTS
7842 ADLER TRAIL
Scenic Hills Homes from $459,900 eternityhomesllc.com

651-460-3043
Take Highway 55 to County Road 3; Go to 80th Street; East to Austin Way; North on Austin; At the T, go right to 7842 Adler Trail
267 Fieldstone Family Homes, Inc.






PARADE HOME $394,700




3 BED |
2.5 BATH
1,942 SQ FT
Welcome to the Afton model at South Grove! This spacious and lightlled home features 3 levels of stunning spaces. Whether you enter through the front or garage door, a set of carpeted steps leads you to the main level. The light- lled main level has an open-concept kitchen, dining area, and living room. You will nd granite countertops in the kitchen with rollout cabinets, bronze hardware, and a double-bowl undermount sink. Upstairs you will nd more than enough space for everyone with three BR, two BA, and a laundry room. The owner’s suite features a walk-in closet and an en-suite bathroom. Use the lower level as a rec. room or additional storage space.
INVER GROVE HEIGHTS
3613 - 76TH LANE E.
South Grove Homes from $359,990 mihomes.com/paradeTC
612-425-3688


I-494 to Highway 52; South on Highway 52; Exit on 70th Street E.; Go east to Clayton Avenue E.; Then go south; In Google maps enter “M/I Homes South Grove”
PARADE HOME $749,970

3 BED | 3 BATH
2,430 SQ FT
This home is located in the exclusive Eagle’s Landing Development! Oversized windows and ceilings, gourmet kitchen, walk-in pantry, multiple replaces. Limited lots remain in this neighborhood!
INVER GROVE HEIGHTS
6958 BOVEY TRAIL
Eagles Landing
612-282-7855 | 952-469-8800
Take Highway 52 to 70th Street; East on 70th Street to Bovey Trail; North on Bovey Trail; Home is on the right on Bovey
Your Dream Home admission supports building futures through housing for Minnesotans in need. The all-access pass allows you to tour all 5 Dream Homes and the Remodeled Dream Home for $25, or purchase a single-home ticket for $5.
See pages 58-60 for home details.
Where

269
612-502-5106 Hastings


STARTING AT $543,742
PARADE HOME $559,900
5 BED | 3 BATH
2,735 SQ FT
You’ll love the spacious, open feeling the Jasmine model o ers with its floor-to-ceiling windows and vaults. Enjoy a cozy loft area leading into the private owner’s retreat plus a nished basement!
ROSEMOUNT
14373 ACER AVENUE
Emerald Isle Homes from $543,742 onetentenhomes.com
612-669-6230 | 651-503-6348
County Road 42 to Akron Avenue; North to Connemara Trail; East (left) to Acer Avenue; North
STARTING
1811 FALLBROOKE DRIVE
creativehomes.com


STARTING AT $518,900 PARADE HOME $619,900





4 BED | 3.25 BATH
2,883 SQ FT



Refreshing design solutions abound in this fully nished, two-story home with four bedrooms, four bathrooms, and 2,883 nished square feet. The open-living floor plan creates the perfect family home with functional living spaces and unmatched value. Enjoy a main-floor o ce o the front foyer, an upper-level laundry room, and a spacious recreational room in the basement! Come see for yourself, and Dream it, Design it, Live it with Key Land Homes!
ROSEMOUNT
14310 ASPEN AVENUE
Emerald Isle Homes from $474,300 keylandhomes.com




952-300-1980 | 952-240-3910
County Road 42 to Akron Avenue; North to Connemara Trail; East to Aspen Avenue








STARTING AT $646,840
PARADE HOME $699,900
5 BED | 5 BATH
3,779 SQ FT
The Madison XL Model has ve bedrooms, three bathrooms including a junior suite and an upper-level loft! Enjoy a very large great room, main-floor o ce, and nished basement!
ROSEMOUNT
14351 ASPEN AVENUE
Emerald Isle Homes from $543,742 onetentenhomes.com
612-432-6752 | 651-503-6348
Avenue;
PARADE HOME $635,990


5 BED | 4 BATH
3,477 SQ FT
Gather friends and family for lively meals in this expansive kitchen and dinette that features stainless steel appliances, quartz countertops, abundant cabinetry, and an oversized center island. The main level is completed with a spacious great room with a gas replace, study, morning room, and mudroom. Upstairs you will nd a spacious owner’s suite featuring a tile shower and double vanity, convenient laundry room, and three additional bedrooms. The nished lower level o ers a family room, fth bedroom, and private bath.
ROSEMOUNT
14370 ASPEN AVENUE
Emerald Isle Homes from $444,990 brandlanderson.com

763-515-7224 | 952-898-0230
East to Aspen Avenue; North to model home
PARADE HOME $617,990


Featuring our popular Sinclair floor plan from our Landmark Collection. Homes include home automation with a Ring Video Doorbell Pro, smart deadbolt lock, access points to broadcast Wi-Fi, and more.


ROSEMOUNT
12691 ABBEYSIDE COURT
Meadow Ridge Homes from $511,990 lennar.com

952-373-0485
4 BED |
2,776 SQ FT
Caramore Crossing o ers two-story, single-family homes featuring spacious KTs with stainless appliances, quartz countertops, main-level o ces or formal dining rooms, and more! See you on the tour!

ROSEMOUNT
13391 ARDROE AVENUE
Caramore Crossing Homes from $560,000 drhorton.com
612-482-4447
From County Road 42 in Rosemount; North on Akron Avenue; Left onto 132nd Street W./Bonaire Path; Right on Ardroe Avenue to model home





PARADE HOME $509,990


4 BED | 3.5 BATH
2,242 SQ FT

Now selling Express Premier homes with four or ve bedrooms. All homes have nished lower levels, upgraded options, vaulted main levels, and three-car garages. Tour the Bryant II plan today!





ROSEMOUNT
13520 CARRAKAY WAY
Ardan Place
Homes from $470,000 drhorton.com
612-271-7503
From Country Road 42 in Rosemount; North on Akron Avenue; Left onto 132nd Street W./Bonaire Path; Left on Ardroe Avenue to model
PARADE HOME $409,940

3 BED | 2.5 BATH
1,894 SQ FT
New construction two-story townhomes with 3 or 4 bedrooms featuring spacious KT with quartz countertops, optional replace, main-level patio, and bedroom suites with private BA. Tour the model today!



ROSEMOUNT
13872 KAYLEMORE TRAIL
Ardan Place
Homes from $380,000 drhorton.com
612-482-4447
STARTING AT $471,990
PARADE HOME $650,000
5 BED | 3.5 BATH
3,352 SQ FT
Main-floor study, gas-burning replace with dramatic tile surround, four bedrooms and loft in upper level, spa-like owner’s bath with soaking tub and separate shower, nished basement with wet bar.
ROSEMOUNT
15164 ARDGILLAN ROAD
Amber Fields
Homes from $456,990
DavidWeekleyHomes.com
763-251-0339 | 952-322-0391
I-35 South to County Road 42 E.; Take County Road 42 East to Akron Road and go right; Take Right on 148th Street W.; Take Left on Ardgillan Road
STARTING AT $449,990
PARADE HOME $525,000
3 BED | 2.5 BATH
2,088 SQ FT
Open-concept main floor, built-in desk o kitchen, electric replace, 180 square feet of windows on the rear of home, private owner’s retreat, upper level loft and laundry.
ROSEMOUNT
15172 ARDGILLAN ROAD
Amber Fields Homes from $439,990
DavidWeekleyHomes.com
763-251-0339 | 763-251-0337
I-494; East to State Highway 77/Cedar Avenue S.; East on County Road 42; Take Right on Akron Avenue; Right on 148th Street W.; Left onto Ardgillan Road








PARADE HOME $362,990


3 BED | 2.5 BATH
1,791 SQ FT
This new two-story townhome is an end unit featuring a contemporary design. The rst floor o ers a stylish open-concept layout among the great room, dining room, and kitchen.



ROSEMOUNT
14851 ARDEE PLACE
Amber Fields Homes from $339,005 lennar.com
952-373-0485
From I-494 take exit 2C to follow MN-77; Keep right on MN-77/ Cedar Avenue; Continue on Cedar Avenue; Left on 150th Street W.; Turn right onto Ardee Place
PARADE HOME $337,990
3 BED | 2.5 BATH
1,769 SQ FT
This new two-story townhome is an interior unit that features a modern design with a large front porch for indoor-outdoor living. The rst floor o ers an open-plan layout among the GR, DR, and KT.

ROSEMOUNT
14855 ARDEE PLACE
Amber Fields Homes from $390,005 lennar.com
952-373-0485
PARADE HOME $619,700
2 BED | 2 BATH
1,892 SQ FT
The one-story Willow o ers 2 BR, 2 BA, a light- lled open layout, and quality nishes throughout. The HOA handles the yard work, so you can relax and enjoy the parks and trails within Amber Fields!

ROSEMOUNT
1374 - 149TH STREET W.
Amber Fields Homes from $425,990 mihomes.com/paradeTC
612-425-3688

County Road 42 to Akron Avenue; South on Akron Avenue; Right on 148th St. W.; Left on Artaine Trail to model; In Google Maps enter “M/I Homes Amber Fields”
STARTING AT $542,990
PARADE HOME $704,990
3 BED | 2.5 BATH
2,819 SQ FT
New floor plan! Amber Fields is a place where your home is more than a home. The Ivy has a tucked-away owner’s suite upstairs, expansive and elegant main-floor spaces and plenty of storage throughout.
ROSEMOUNT
1546 - 149TH STREET
Amber Fields Homes from $512,990 pulte.com

651-478-2910
145th Street;
145th
Avenue;















7 interactive parks


Miles of new trails
100+ acres of nature & recreational areas

















Excellent Rosemount schools











PARADE HOME $644,990
4 BED | 2.5 BATH
2,692 SQ FT
This spacious two-story gem o ers an open-concept layout connecting the kitchen, dining room and great room. The second floor boasts an owner’s suite, 3 BRs with walk-in closets, and a versatile loft.
ROSEMOUNT
14302 ANSTON AVENUE
Talamore Homes from $479,990
lennar.com
952-373-0485
Keep left on MN-77 S.; Continue to 140th St. W.; Turn left on 140th St. W.; Continue on Connemara Trail; Right on Shannon Parkway; Left on Cobbler Avenue
PARADE HOME $539,990
4 BED | 2.5 BATH
1,830 SQ FT
Experience the perfect blend of comfort and style in this new two-story home. Open-plan layout on the rst floor and on the second floor, three serene secondary BRs and a luxurious owner’s suite.
ROSEMOUNT
14303 ANSTON AVENUE
Talamore Homes from $479,990
lennar.com
952-373-0485
Scan






STARTING AT $411,990
PARADE HOME $450,000
This two-story townhome is peak comfort and convenience. The main level boasts a family room, dining room, and kitchen. Upstairs, nd three peaceful BRs, including a generously sized owner’s suite.
ROSEMOUNT
1602 - 144TH STREET E.
Talamore Homes from $479,990












lennar.com
952-373-0485
3 BED | 2.5 BATH
1,943 SQ FT
Welcoming to the Royalton. An impressive view extends through the FR, DR, and KT to create an ideal setting for gatherings. Find easy rest in the luxurious owner’s suite with contemporary ensuite BA.
BURNSVILLE
14604 TWIN LAKES CIRCLE
The Reserve at Twin Lakes Homes from $390,000 DavidWeekleyHomes.com
952-444-0239 | 952-232-6201
I-35W; South to Buck Hill Road in Burnsville; Follow Buck Hill Road to South Cross Drive W.; Take left; Reserve at Twin Lakes is on left














PARADE HOME $416,990

3 BED | 2.5 BATH
1,894 SQ FT
Two-story townhomes in Lakeville with 3 or 4 bedrooms featuring spacious kitchens with quartz countertops, optional replace, main-level patio, bedroom suites with private baths, and private decks!


LAKEVILLE
16463 JAFFNA PLACE
Crystal Park Homes from $390,000 drhorton.com

612-482-4447
From I-35 travel east on County Road 46/162nd Street W.; Turn right on Ipava Avenue; Turn right on 165th Street W.; Right on Ja na Place to model
PARADE HOME $729,580
3 BED | 3 BATH
2,742 SQ FT
Welcome to the St. Croix Rambler! Open floor plan with oversized windows and 9’ ceilings to maximize natural light. The main level o ers a big, beautiful kitchen with working pantry. Great room features stonefaced replace and built-in cabinets, two bedrooms, two bathrooms, main-floor laundry plus den. The lower level is nished boasting a family room with a wet bar, one additional bedroom, and plenty of storage space. Homes are available for quick move-in in this neighborhood.
LAKEVILLE 18290 JUREL WAY
Kenwood Hills
612-703-4528 | 952-469-8800
From North: I-35 to County Road 50 (Kenwood Tail); South to Jurel Way OR
From South: I-35 to 185th Street (east) to County Road 50 (Kenwood Trail) to Jurel Way
STARTING AT $794,900 PARADE HOME $999,770



5
|
Make your dream home a reality in Country Joe Homes’ exclusive neighborhood — The Preserve of Lakeville! Beautiful wooded lots with a picturesque setting. The Forest Hill model o ers a covered screen porch and custom lower level bar, both allowing for endless entertaining opportunities. The second floor includes a primary bedroom with ensuite bath and three extra bedrooms including a junior suite with an additional gathering area.
LAKEVILLE 18884 JAVELIN PATH
Preserve of Lakeville Homes from $712,900 countryjoehomes.com 952-454-7470

185th Street (County Road 60); South on Kenwood Trail; East on 190th Street W.; North on Javelin Way; Model is on the northeast corner of Javelin Path
PARADE HOME $649,990
5 BED | 4 BATH
2,786 SQ FT
Optimized for gracious living, this new two-story home features a rst-floor great room for shared moments, a study for solitary work, a dinette for quick bites, and a kitchen!
LAKEVILLE 18179 HIDEAWAY TRAIL Caslano Homes from $543,990 Lennar.com 952-373-0485
Take Cedar Avenue S.; West/right on 185th Street; South/left on Hamburg Avenue; Right/west on 187th Street; Model on the left
PARADE HOME $710,000
4 BED |

3 BATH
2,832 SQ FT
Pietsch Builders, an award-winning builder with over 40 years of custom homebuilding experience, proudly presents our newest four-bedroom, three-bathroom executive rambler. Features include a gourmet-style kitchen with custom cabinets and upgraded appliance package, large dining area, lavish owner’s suite with custom walk-in shower, main-level laundry, great room with gas-burning replace and ceiling beams, oversized lower-level family room, two additional bedrooms, zoned HVAC, and tons of storage. Unbeatable in pricing, design, and quality! 30+ lots in the South Metro.
LAKEVILLE
8278 - 186TH STREET W. Redstone
pietschbuilders.com





612-396-0692
Highview Avenue; East on 185th Street W.; South on Hamel Drive; West on 186th Street W. to home

STARTING AT $624,900
PARADE HOME $649,900
5 BED |

4 BATH
3,601 SQ FT
The San Fran Loft home features a stunning open and spacious KT with huge center island, walk-through pantry, mudroom with built-in lockers and walk-in closet, ve BRs, four BAs, and nished LL.

LAKEVILLE
18547 HAVEN COURT
Redstone Homes from $499,900


eternityhomesllc.com 651-460-3043




Located between Highview and Cedar on 185th Street; Take Hamel south to 186th Street; Right on Haven Court into cul-de-sac; Home is on the left
PARADE HOME $569,990




3 BED | 3 BATH
1,719 SQ FT
Discover contemporary living in this two-story home. Seamless dining room and kitchen connection. Upstairs, lofted great room, 2 BRs, and owner’s suite. Plus, an un nished basement for customization.
LAKEVILLE
18732 HANCOCK AVENUE
The Grove at Avonlea
Homes from $529,990 Lennar.com
952-373-0485

STARTING AT $675,900
4
Welcome home to the Riverside Model! A large GR and gourmet KT for hours of entertaining. Second floor owner’s suite w/private ensuite BA, and three extra BR with two BA. LL is ready for your nishes!
LAKEVILLE
17909 HIDDEN CREEK TRAIL
Highview Ridge Homes from $598,900 countryjoehomes.com


612-910-2256
Cedar Avenue; West on 185th Street W.; North on Hamburg Avenue; West on 182nd Street W.; North on Headwaters Drive; North on Hidden Creek Trail
STARTING AT $676,700
PARADE HOME $722,900
4 BED | 3.25 BATH
2,680 SQ FT
Combine comfort and style in this two-story home with four bedrooms, four bathrooms, and 2,680 nished square feet. Enjoy a main-level flex room, family room with replace, and spacious kitchen!
LAKEVILLE 17901 HIDDEN CREEK TRAIL
Highview Ridge Homes from $539,900 keylandhomes.com 952-300-1980 | 952-240-3910
I-35 to 185th Street W.; East on 185th Street W.; North on Dodd Boulevard; South on Hayes Avenue (Turns into Headwaters Dr.); West on Hidden Creek Trail
STARTING AT $531,900 PARADE HOME $584,582






3 BED | 2.5 BATH
2,695 SQ FT
This villa o ers main-level living with lawn care and snow removal provided by the HOA. Features include a spacious primary BR w/ensuite BA, GR, fully nished LL w/two BRs on a walkout basement lot.
LAKEVILLE
17854 HAMBURG AVENUE
Summers Creek Homes from $475,900 countryjoehomes.com





612-290-4333 | 612-965-6291
Cedar Avenue; West on 185th Street W.; North on Hamburg Avenue; Follow Hamburg Avenue N. across Dodd Boulevard; Model on right side of Hamburg Avenue
PARADE HOME $659,900
3 BED |
2 BATH
2,006 SQ FT
Perfect family home with three bedrooms and two bathrooms on one floor. Open concept with gourmet kitchen featuring custom-level cabinets, upgraded, stainless steel appliances and quartz countertops. Living room has a wall of windows overlooking the backyard and a replace with built-in bookcases. The owner’s suite features a tray ceiling and a walk-in ceramic shower. Laundry room is on the rst floor. Garage is insulated and sheet-rocked. Professionally landscaped.




$692,000
PARADE HOME $769,900

LAKEVILLE
17932 GREENWICH WAY
Summers Creek Homes from $529,900

summer-gate.com
952-898-3461
From intersection at Dodd and Cedar: West on Dodd for 1⁄2 mile to Hamburg Ave.; Left on Hamburg for 2 blocks to Greenwich Way; Left on Greenwich Way to model
3 BED |
3.5 BATH
2,069 SQ FT
Live your best life in our Glacier Creek luxury townhomes. The main level has 13-foot ceilings and o ers an open-concept kitchen, dinette, great room, and private deck. The kitchen features stainless steel appliances, oversized center island, quartz countertops, and a large walkin pantry. The upper level features two bedrooms, two bathrooms, loft, and a laundry room. The lower level is a great place to relax or host guests with an oversized family room, bedroom, and bathroom. Get all of these features and the convenience of an association to take care of the yard work and snow removal.
LAKEVILLE
18178 GARLAND PATH
Glacier Creek Homes from $420,990 brandlanderson.com


612-326-3965 | 952-898-0230
County Road 42 to Cedar Avenue; Go south to 181st Street W.; Go east to Glacier Way; Go south to Gavel Lane; Go east to Garland Path; North to model home
5 BED |
5 BATH
3,921 SQ FT
The Maverick model is a simply stunning home! Featuring stained shiplap ceilings, stone replace wall, oversized windows, gourmet kitchen, stylish wet bar, and a luxurious primary ensuite.

LAKEVILLE
18237 GLACIER WAY
Glacier Creek Homes from $534,742
onetentenhomes.com
612-756-6243 | 952-215-7519
From Cedar Avenue; East on 181st Street W.; Right (south) to home
4 BED | 3 BATH 2,049 SQ FT
This is a family-friendly haven with seamless flow on the rst floor. Loft adds shared living space upstairs. Four bedrooms, including a luxe owner’s suite with spa-like bathroom and walk-in closet.

LAKEVILLE 7376 - 183RD STREET W. Voyageur Farms Homes from $449,990 lennar.com 952-373-0485








STARTING AT $595,744 PARADE HOME $619,900






5 BED | 4 BATH 3,051 SQ FT
The Payton XL is a popular design with an all-new updated kitchen! The main level has an o ce, walk-in pantry, and sun- lled great room. UL has large vaulted primary suite plus four more bedrooms.
LAKEVILLE
17849 EVERSHED WAY
Knob Hill
Homes from $529,742 onetentenhomes.com
612-401-2323 | 651-503-6348
5
Eternity Homes San Fran Loft features ve BRs, four BAs, a loft and a three-car garage! Includes amazing features like granite, stainless appliances, tiled floors, solid doors, tiled showers, and more!


LAKEVILLE
17944 EXETER CIRCLE
Knob Hill
Homes from $575,000 eternityhomesllc.com


651-460-3043
2,936 SQ FT
The Marquee brings refreshing design solutions in this fully nished, two-story home with ve bedrooms, four bathrooms, and 2,936 square feet. Enjoy the open-concept layout with a spacious kitchen, dining room, living room, mudroom, and flex room on the main floor! The open-living floor plan creates the perfect family home with functional living spaces and unmatched value. Come see for yourself, and Dream it, Design it, Live it with Key Land Homes!
LAKEVILLE 17923 EVERSHED WAY
Knob Hill
Homes from $458,400 keylandhomes.com 952-300-1980 | 952-240-3910
Pilot Knob to 179th St.; South on Eventide Way; West on Upper 179th St.; North on Evershed Way or Flagsta Ave.; East on 179th St.; South on Evershed Way
5
| 3 BATH 2,707 SQ FT


This is a gem, the non-traditional, split-style home o ering 5 bedrooms and 3 bathrooms. Vaulted ceiling, open and spacious floor plan, perfect for entertaining. Three-car garage and deck included.
LAKEVILLE 5322 - 178TH STREET W.
Pheasant Run Homes from $449,900 eternityhomesllc.com







651-460-3043

Four bedrooms, three bathrooms, great room, kitchen, dining room, replace, three-car garage, and central



3
LAKEVILLE
5336 - 177TH STREET W. Pheasant Run
Homes from $574,900 shimotapm.com
952-758-6699 | 651-387-3297
Follow


1,894 SQ FT
Brookshire in Lakeville is a new executive community that will o er 700+ lots! Two-level townhomes with 3-4 bedrooms include main-level patios, designer-inspired interior packages, and luxury bedrooms!


LAKEVILLE
17119 DYSART PLACE
Brookshire
Homes from $390,000 drhorton.com
612-482-4447
From County Road 46, turn right onto Pilot Knob Road; Continue to 170th St. West and turn
jameshardie.com


countryjoehomes.com


Homes from $550,000 drhorton.com













612-482-4447


1,895 SQ FT


RT Urban homes features The Modern Rowhouse. The Revelation | E1 is an attached townhome with tuck-under garage with thoroughly modern sensibilities. This end unit o ers a central dining room with expansive side-facing windows and a kitchen that opens to a private glass-railed deck. The two-bedroom plan features an upper-level loft and light- lled owner’s suite. Homeowner’s Association provides lawn care and snow removal. Association clubhouse and pools. HOA fees apply.
LAKEVILLE
16064 EAGLEVIEW DRIVE



Spirit of Brandtjen Farm - Revelation Collection
Homes from $429,900 rturbanhomes.com

952-522-6022
Take I-35 to County Road 46/160th Street; Go east to Eagleview Drive; South on Eagleview Drive, Left at the roundabout to 162nd Street W. and models
PARADE HOME $529,950

2,025 SQ FT
Featuring the Revelation B1 townhome. This unit o ers a large waterfall KT island, open-concept DR/FR w/light lled spaces, 3 BR, and built-ins throughout. Enjoy the private rooftop deck w/wet bar.



LAKEVILLE 5001 - 162ND STREET W. Spirit of Brandtjen Farm - Revelation Collection




Homes from $429,900 rturbanhomes.com 952-522-6022
Take I-35 south to County Road 46/160th Street W.; Go east to Eagleview Drive; South on Eagleview Drive through roundabout; East on 162nd Street to models
312
5 BED | 4 BATH
3,750 SQ FT
The Savanna model has a private main-level o ce with views to the backyard. You will love the spacious great room and gourmet kitchen with wrap-around cabinets.
LAKEVILLE
19614 HARBOR DRIVE
Berres Ridge Homes from $643,742 onetentenhomes.com
952-484-4130 | 651-503-6348
314
Eternity Homes, LLC



5 BED | 5 BATH
4,801 SQ FT
This home o ers custom flare and design. Gourmet kitchen with large center island and spacious dining area. Featuring one-of-a-kind walkthrough pantry, 5 bedrooms, 5 bathrooms, plus an indoor sport court!

LAKEVILLE
19774 HENNING AVENUE
Berres Ridge Homes from $599,900
eternityhomesllc.com


4 BED | 2.5 BATH
2,463 SQ FT
Stone Cottage’s favorite plan with a new layout! The Maplewood III features an open-concept main level between kitchen, dining, and great room. The custom front paneling design is carried within the home in the entryway and mudroom. Kitchen features enameled and stained white oak cabinetry. A custom replace wall designed with built-ins and shelving makes the perfect accent. Walk upstairs to the owner’s suite complete with large sleeping area, tiled walk-in shower, bath tub and walk-in closet. Access from the suite into the laundry room and the rest of the upstairs. At Stone Cottage Construction we build for your family’s needs!
19921 HARRISBURG WAY

Berres Ridge Homes from $549,900 stonecottage.com











952-388-1301
Avenue; South to 202nd Street W.; West to Hamburg Avenue; North to Harrisburg Way; Left to home on left
Take Cedar
MN Lic. #BC636874
4
2,533 SQ FT
Welcome home to The Nora. UL has custom tile walk-in shower and freestanding soaker in luxury owner’s suite with barn-beam vault, plus 3 additional bedrooms with “divided-bath” for additional privacy and comfort. UL laundry with sliding barn-door, sink and custom storage. Main level o ers open kitchen with custom-built onsite nished cabinets with soft-close throughout, large center island with snack-bar, SS appliances, quartz tops, and corner window sink. Open main level with 9’ ceilings, large casement windows, gas burning FPL with custom built-ins, study, mudroom entry with bench and drop-zone storage. Onsite nished millwork/trim/solid core doors throughout.
Trail;
LAKEVILLE
19805 HENNING AVENUE
Berres Ridge
mcnearneyhomes.com
952-985-0965
LUXURY

Model is on left side
Cedar Hills in Lakeville featuring the Salerno villa floor plan. This












single-story home o ers space for the whole family to thrive. It o ers a great room with wide windows and connected kitchen.

4
Cedar
LAKEVILLE
20268 GENEVA TRAIL
Cedar Hills
Homes from $399,990 lennar.com



952-373-0485
Take




STARTING AT $499,900
PARADE HOME $580,800
2,439 SQ FT
5 BED | 3.5 BATH
3,018 SQ FT
Spacious two-story w/open KT, DR, & LR on ML; inviting entry; and mudroom o the 3-car garage. UL w/owner’s ensuite, 3 BRs, laundry, and BA. Finished LL w/separate entrance, BR, BA, laundry, KT, and LR.
FARMINGTON
19116 CLOVERLEAF WAY
Fair Hills at North Creek Homes from $422,000 flexandgrowhome.com


763-498-9669 | 763-479-4820
Cedar Ave. to 160th St. W.; East to Pilot Knob Road; South to 195th Street W.; East to Colonial Trail; Right into neighborhood; Left on Cloverleaf to model
4 BED | 2.5 BATH
2,103 SQ FT
Whispering Fields in Farmington o ers beautiful Express Select series of homes. These two-story homes feature upgraded options, loft spaces, bedroom suites w/walk-in closet, and beautiful homesites.



FARMINGTON
6531 - 209TH STREET W.
Whispering Fields
Homes from $440,000 drhorton.com
612-482-4447
From MN-77/Cedar Avenue; Go east on Dakota County Road 50 E./ Lakeville Boulevard; Left on Flagsta Avenue; Community is south of Farmington High School
STARTING AT $589,900 PARADE HOME $589,900




4 BED | 2.5 BATH
2,557 SQ FT
This home boasts an open KT and FR on main level with large entry and front o ce. The UL has owner’s suite, three BRs, laundry, BA, and loft. It also has a three-car GAR and un nished LL walkout!
FARMINGTON
19185 COLONIAL TRAIL
Fair Hills of North Creek Homes from $609,900
612-282-7653 | 763-479-4820
Cedar Avenue to 160th Street W.; East to Pilot Knob Road; South to 195th Street W.; East to Colonial Trail; Right on Colonial Trail to home
With four bedrooms plus a loft, the Dearborn is a must-see! This home’s open layout includes a sleek kitchen, large dining room, family room with replace, a flex room, plus a nished lower level.


FARMINGTON
19137 COLONIAL TRAIL
North Creek Homes from $364,990 mihomes.com/ParadeTC
612-425-3688



South on Pilot Knob Road; East on 195th Street W.; Right on Colonial Trail to model; In Google maps enter “M/I Homes North
This home features 5 BR plus loft, 4 BA, and 3-car garage. Open and spacious floor plan overlooking Sapphire Lake. Standard features include hardwood and tile floors, solid doors and custom cabinets.
FARMINGTON
1541 SPRUCE STREET
Sapphire Lake Homes from $499,900 eternityhomesllc.com








651-460-3043
Highway 3 to Spruce Street; East on Spruce Street to 1541 Spruce; House on left
3
The Van Gogh is a beautifully designed home with an open-floor concept featuring three bedrooms and two bathrooms on the main level and 1,753 nished square feet with room to grow!
FARMINGTON 2857 - 213TH STREET
Sapphire Lake 2nd Addition Homes from $446,900 keylandhomes.com
952-300-1980 | 952-240-3910
Take County Road 3 to 213th Street
W.; East one mile to Sapphire Lake Development; Continue left on 213th Street W.; Model home is on the left
3 BED | 2.5 BATH
1,820 SQ FT

Welcome to Vita Attiva at South Creek, a 55+ active-adult community. South Creek o ers an amenities-rich community with luxury resort-style living. Single-level villas and row homes w/outdoor living.

FARMINGTON
5243 - 217TH STREET W. Vita Attiva Homes from $375,000 myvitaattiva.com
612-852-6640
Highway 50 to Eaton Avenue; South to 217th Street W.; Right to home on the right side of the street
PARADE HOME $364,990


3 BED | 2.5 BATH
1,906 SQ FT
This spacious townhome features an upper-level loft with washer and dryer, water softener, and blinds. This home is perfect for rst time homebuyers, is HOA maintained, and has 3 luxurious bedrooms.
FARMINGTON
21820 WISTERIA WAY
Vermillion Commons Homes from $328,915 lennar.com
952-373-0485
Take County Road 50 in Farmington; Turn south onto Denmark Avenue; Continue for half mile. Turn right onto 218th Street
STARTING AT $425,000
PARADE HOME $465,000
3
SQ FT
Contemporary end-unit townhome. Stylish open-concept layout on rst floor with great room, dining room, and kitchen. Upstairs are two secondary bedrooms, loft, and luxurious owner’s suite with retreat.

FARMINGTON
21829 WISTERIA WAY
Vermillion Commons Homes from $328,915 lennar.com

952-373-0485
2 BED |




2 BATH
1,483 SQ FT
This home is located on a quiet street in the thriving community of North eld, one of the top places in the nation to retire. The development o ers a wonderful walking and biking environment with easy access to nearby schools, retirement center, regional parks, and trails. Although this is not an age-restricted neighborhood, thoughtful care was taken to design every aspect of these homes for our residents to age in place. Features include level driveways, sidewalks, front porches, back patios, one-floor living, roll-in showers, no steps, and no-barrier floor plans. Other homes with three bedrooms available at 1,887 square feet.
NORTHFIELD 435 FORD STREET E. Blu View Homes from $375,000




jrbr.builders 507-366-1288 | 612-481-0891
I-35S; Exit 69; Left on Highway 19; 7 miles to 5th St.; Right on Division St.; Third roundabout exit onto Je erson Pkwy.; Right on Maple St.; Right on Ford Street











PARADE
3 BED | 3 BATH
2,659 SQ FT
Rambler-style home with wonderful sun- lled open floor plan. Finished lower level has family room, bedroom, and 3⁄4 bathroom with plenty of storage space to boot.
DUNDAS
367 CROSS CIRCLE
Tower Heights
612-685-2950 | 952-469-8800
1,596 SQ FT
Luxury Downsizing! This is one-level living at its nest! Custom designed and built by award-winning builder. This 3-BR, 2-BA home has Andersen Windows, in-floor heat, 11’ walls and vaulted ceilings to create an open GR with a large island, Cambria countertops and a walk-through hidden pantry! The owner’s BR has access to the rear covered patio and has a barrier-free shower. A third BR is shown as a flex room with vaulted ceilings and barn doors. The oversized two-car garage nished with in-floor heat can be used as a party room. Come see the di erent home styles. Large single-family homes to association-maintained twinhomes and many one-level living options.
FARIBAULT
2700 HANSON AVENUE
Parkland Village LLC
FitzkeCustomHomes.com



612-483-0475 | 612-424-2569
I-35; Exit on MN-21; Go northwest; Left on Airport Road; Right on Fredericksen Drive; Left on Hanson Avenue



4 BED | 3 BATH
2,597 SQ FT
All the convenience of main-level living with the bene t of additional space in the lower level when you need it. The open-concept kitchen, dining room, and great room is the perfect spot for entertainment. Enjoy the ambiance of the replace with stone surround. Large windows in the great room, primary bedroom and lower level family room allow for plenty of natural sunlight. The main-level laundry with sink is located near the mudroom entrance and across from the primary bedroom. The primary bath has dual vanities, abundant counter space and a ceramic shower. The lower level boasts a family room, two more bedrooms, 3⁄4 bath and a large un nished space.
FARIBAULT 1205 IVY WAY

The Meadows
612-965-6653 | 952-469-8800
From Highway 3; East on E. Division Street; Right on Meadows Drive; Right on Williams Avenue to Westwood Drive; Turn right on Westwood to home on left
5
|
2,707 SQ FT
Welcome to Eternity Homes’ gorgeous Augusta floor plan! Built the way you want to live! Includes amazing features like granite, stainless, tiled floors, solid doors, wood floors and more!

ELKO NEW MARKET
9535 ANDREW AVENUE
Boulder Heights Homes from $459,900 eternityhomesllc.com
651-460-3043
275th Street E.; Right on Oxford Lane; Left on Andrew Avenue to home





PARADE HOME $749,999

4 BED |
2.75 BATH
3,217 SQ FT
Pete’s Hill o ers the highest point in Scott county and a stunning forest with breathtaking views of the skyline. This is a two-time Reggie Award-winning design! The views are breathtaking. We are nearing completion, but there are some wonderful sites still available so there are many opportunities left. Handcrafted quality and innovative design with old-world craftsmanship that is hard to nd these days. Zero-barrier, age-in-place-friendly universally designed homes have 3’-wide doors, and barrier-free showers and entries and exits. Extra deep garages up to 30’ deep and specious yards. Adjacent to golf course and only a few minutes from I-35.
ELKO NEW MARKET
27050 PETE’S HILL TRAIL
Pete’s Hill Homes from $595,000 jrbr.builders




507-366-1288 | 612-481-0891
PARADE HOME $1,950,000
5 BED | 4.5 BATH 5,223 SQ FT
Welcome to The Ranch of Credit River! This refreshing Prairie-style, two-story design has unique gathering areas and high-end amenities. Don’t miss the LL entertainment area with custom golf simulator!


CREDIT RIVER
7918 - 207TH STREET E.
The Ranch of Credit River
cuddigancustombuilders.com
952-261-9732 | 952-469-1611
I-35W; West on 185th Street/County Road 21; South on Natchez; Straight through roundabout to Vernon Avenue; West on 207th Street; East to home
PARADE HOME $499,900
4 BED | 3 BATH
2,631 SQ FT
Established neighborhood, maintenance-free living in detached one-level villa with n. LL, 4 BR, open floor plan, KT pantry, hard-surface counters, laminate floors, main-level laundry on wooded lot.
ELKO NEW MARKET
1125 SEURER STREET
The Farm
612-201-8257 | 952-469-8800
South on I-35W; West on County Road 2; Take exit for Elko New Market; South on Webster Street; East on Seurer Street to home
PARADE HOME $1,740,000

5 BED | 4.5 BATH
4,233 SQ FT
Gorgeous 2.5-acre modern ranch home by Highmark Builders features a main living area w/home o ce, laundry and owner’s suite in its own private wing — complete with a dual-vanity bath and soaking tub.

CREDIT RIVER
7926 - 207TH STREET E.
The Ranch of Credit River
952-736-8163
I-35W; West on County Road 60; South on Natchez; South on Vernon Avenue; West on 207th Street to home

PARADE HOME $2,042,992


4 BED |
4.25 BATH
5,020 SQ FT
Absolutely beautiful two-story nestled on a wooded 2.5-acre lot in high-demand Credit River. The Ranch development has gorgeous rolling hills, pockets of woods, ponds and rivers. Modern farmhouse transitional design, 5,000 nished sq. ft. White enameled cabinetry plus a nice mix of rustic white oak. Ultra luxury owner’s suite and bath. Upper-level loft. Kids’ bedrooms have private and Jack-and-Jill bathrooms. Signature Wooddale 3-season porch with floor-to-ceiling replace, retractable windows, rustic barnwood ceiling and beams. Finished walkout lower level with full bar and home gym. Come checkout Wooddale Builders’ incredible quality and attention to detail.
CREDIT RIVER
7964 - 207TH STREET E. Ranch
wooddalebuilders.com
612-518-6221 | 952-345-0543
I-35W; South to 185th Street W.; Turn left on Natchez Avenue; Through roundabout onto County Road 91 S.; Go to 207th Street E.; West to home
PARADE HOME $2,569,900
5 BED | 5 BATH
6,194 SQ FT
Stunning home on a 2.6-acre lot. Spacious floor plan features 5 BR, 5 BA, 10’ main-level ceilings, a kids’ lounge, athletic court, exercise room, and lower-level bar/wine area that is excellent for entertaining.
CREDIT RIVER
7972 - 207TH STREET E.
The Ranch
customonehomesmn.com

651-274-1403 | 651-459-1972
Take I-35 south to County Road 70; West to Vernon Avenue; North to 207th Street; East to property
PARADE HOME $1,500,000
5 BED |
5 BATH
4,350 SQ FT
Pietsch Builders, an award-winning builder with over 40 years of custom building experience, proudly presents their newest custom rambler. Features include over 4,300 nished square feet, a screenedin porch, a gourmet kitchen with custom cabinets, vaulted ceilings with custom beams, a walk-through pantry with cabinets galore, a custom walk-in shower, a freestanding tub, and unbelievable nishes. The lower level boasts three bedrooms, an exercise room, three baths (including a Jack-and-Jill), full bar/kitchenette, and plenty of room to entertain.

CREDIT RIVER
7656 LONGVIEW LANE
Tara Farms
pietschbuilders.com 612-396-0692




I-35; West on County Road 70/ County Road 8; North on County Road 27/Texas Avenue; East on 210th Street E.; North on Nevada; Left on Longview Lane to home
PARADE HOME $652,710

4 BED | 2.5 BATH
2,943 SQ FT
Distinctive Design Build is proud to present this beautiful rambler home in Prior Lake. Quality craftsmanship and inspiring design with high-end amenities and spaces for today’s families that you can always expect from a Distinctive home. With 2,900 nished square feet, this home features an owners’ suite with walk-in shower, quartz countertops, and custom cabinets. Many plans and lots to choose from. Visit us on the tour and discover the “Distinctive di erence.”
PRIOR LAKE
17898 PRAIRIE WAY
Revere Place
distinctivedesignbuildllc.com 651-344-7151
Follow County Road 21; South on County Road 87; Right on 180th Street E.; Right on Mission Trail SE; Left on Prairie Way SE; Home is on the left
STARTING AT $765,555 PARADE HOME $889,900





5 BED | 5 BATH
4,341 SQ FT
The Brooke Model has great spaces for family and entertaining! A gourmet kitchen with 9’ island and full peninsula open to a morning room. Don’t miss the rec. room, wet bar, and beautiful primary suite!


PRIOR LAKE
17628 JETT CIRCLE SE




Parkwood Estates
Homes from $660,179 onetentenhomes.com
612-919-4532 | 651-503-6348
Eagle Creek Avenue SE; Go to Fish Point Road; Go south to Jett Circle; Go right (west) to home on the left
Nestled on a prime lakeshore lot, this home is a perfect mix of timeless and modern design with all the luxuries you expect with lakeside living. This plan is ideal for family leisure or entertaining.
PRIOR LAKE
5038 CONDONS STREET
Condon’s Woodale
pinnaclefamilyhomes.com
952-210-5037 | 651-470-6392
Highway 13 to 160th Street SE; Right on Ridgemont Avenue SE;
6
|
4.5 BATH
3,908 SQ FT
Introducing our newest home design — The Heritage. This multi-generational home features a main-level bedroom suite, home o ce, open kitchen, great room, and dinette that are perfect for entertaining or family time. The kitchen features an oversized center island with quartz countertop, Frigidaire stainless steel appliances, painted birch cabinetry, and LVP flooring. The upper level o ers an owner’s suite with a walk-in shower, three additional bedrooms, laundry, and an o ce area. The lower level is welcoming to overnight guests who will appreciate the privacy of the sixth bedroom and 3⁄4 bath. The family room is ideal for watching the big game.
PRIOR LAKE
17660 JETT CIRCLE SE
Parkwood Estates
Homes from $539,990
brandlanderson.com
612-326-6067 | 952-898-0230
Take Highway 13 to Mushtown Road; South to model home
3 BED | 2.5 BATH
3,352 SQ FT
Pike Lake Landing is a detached villa community in Prior Lake. Carefree lifestyle with main-level living, including lower-level walkout for entertaining. Spacious private open views from every home.

PRIOR LAKE
13727 PARK HAVEN TRAIL NE


Pike Lake Landing Homes from $930,000 RonClark.com
612-860-3065 | 952-947-3000
US-169 to County Road 21 S.; Go to Marsh Drive E.; On to Park Haven Trail NE; Model is on the right
As you enter the Broadmoor Sport you will be drawn in by the oversized windows, gourmet KT, and cozy FPL. Enjoy the nished LL with indoor sport court and wet bar. Located in Prior Lake. ISD 719.



PRIOR

4120 MARSH DRIVE NE Pike Lake Landing Homes from $749,900 robertthomashomes.com
I-494 to US-169 S.; Exit 115 to County Road 21/Herrgott Memorial Drive S.; Left at Marsh Drive NE to model
Welcome to your dream retreat with lavish amenities and stunning views! Brand-new Prior Lake home o ers modern and natural beauty with open living space. Enjoy luxurious lake life living. PRIOR

Highway 13; West on Spring Lake Road SW; North on Northwood Road NW; East on




Beautiful and large lake-view homesites and homes in Prior Lake! These two-story homes o er nished LL family rooms, quartz counters, and main-level bedrooms. Tour the decorated Whitney model today!






PRIOR LAKE
3105 SUNFLOWER WAY Springview Meadows Homes from $600,000 drhorton.com 612-271-7503


PARADE HOME $2,450,000
3 BED | 3.5 BATH
3,678 SQ FT
Welcome to our newest dream home o ering single-level living incorporating modern farmhouse aesthetics. The exterior combines classic architectural elements with contemporary nishes. Once you step inside, you’ll nd yourself immersed in a transitional-style interior where dark, moody color tones create a captivating ambiance. The vaulted ceilings in the great room create an airy and open atmosphere, while exquisite beam details and a stone replace add a touch of rustic charm. Come experience the comfort and elegance of this property rsthand.
JORDAN
19355 XEON AVENUE
highmarkbuilders.com


952-736-8163
Take MN-282; South on Baseline Avenue in Sand Creek Township; Take Baseline Avenue to your destination in Spring Lake Township
PARADE HOME $499,990
4 BED | 2.5 BATH
1,989 SQ FT
Bridle Creek o ers the Express Select series on beautiful homesites! New homes feature well-appointed kitchens, upper-level loft and laundry, spacious bedroom suites, and more! Tour the model today!

JORDAN
1024 SHOREVIEW DRIVE
Bridle Creek Homes from $400,000 drhorton.com

612-482-4447
PARADE HOME $479,700
3 BED | 2.5 BATH
2,175 SQ FT
The Dearborn o ers the perfect mix of farmhouse styling with modern nishes. You’ll love the open-concept layout, white kitchen with black accents, spacious loft, and vaulted owner’s suite.




JORDAN
1221 KASOTA COURT
Beaumont Blu s
Homes from $369,990 mihomes.com/paradeTC
612-425-3688
21
PARADE HOME $719,700


3 BED |

3 BATH
2,929 SQ FT
Enjoy main-level living in the charming town of Jordan! Easily access Highway 169 to all conveniences in surrounding cities. The Grayson model is a must-see with its warm tones and open-concept feel.

JORDAN
1225 KASOTA COURT
Beaumont Blu s
Homes from $369,990 mihomes.com/paradeTC
763-425-3688
PARADE HOME $497,990


4 BED | 2.5 BATH
2,179 SQ FT
Available now, Amberglen in Shakopee o ers Express Select two-story, single-family homes featuring 3-5 bedroom plans, open-concept main levels, well-appointed kitchens, loft spaces, and more!


SHAKOPEE
1905 ARCADIA STREET
Amberglen Homes from $480,000 drhorton.com
612-482-4447
Take
PARADE HOME $526,990


4 BED | 3.5 BATH
2,402 SQ FT
Available now, Amberglen in Shakopee o ers raised-ranch homes featuring 4-5 bedrooms, vaulted main levels, well-appointed kitchens, optional FPL, nished lower levels, and luxury bedroom suites.

SHAKOPEE
1917 ARCADIA STREET
Amberglen Homes from $480,000 drhorton.com


612-482-4447
PARADE HOME $599,990
4 BED | 2.5 BATH
2,271 SQ FT
This new two-story home has a contemporary design. The rst floor showcases a great room flowing seamlessly into a nook and a kitchen with a corner pantry, while flex space o ers versatility.

SHAKOPEE
2795 DOWNING AVENUE
Summerland Place
Homes from $369,990
lennar.com
952-373-0485
PARADE HOME $569,900
3 BED | 2.5 BATH
2,668 SQ FT
Distinctive Design Build is proud to present this beautiful rambler home in Summerland Place. Quality craftsmanship and inspiring design with high-end amenities and spaces for today’s families that you can always expect from a Distinctive home. This modern rambler floor plan with 2,668 square feet is dressed with quartz countertops and custom cabinets. Custom home packages start in the high $400Ks. Many lots and home packages to choose from. We will design a custom plan just for you!
SHAKOPEE 1578 PHILIPP WAY
Summerland Place
distinctivedesignbuildllc.com 651-344-7151




PARADE HOME $384,790



3 BED | 2.5 BATH
1,777 SQ FT
This elegant two-story townhome o ers a versatile lower level. The rst floor features an open design among a family room for get-togethers, a dining room, and upgraded kitchen.

SHAKOPEE
1713 TYRONE DRIVE
Summerland Place
Homes from $376,990
Lennar.com



952-373-0485


PARADE HOME $829,700
4 BED | 3 BATH
3,388 SQ FT
The Amelia is a light- lled home with an open layout, warm wood tones, and stunning nishes throughout. The main level has 3 BR and 2 BA, with an additional BR, BA, and rec. room in the lower level.



SHAKOPEE 3824 THRUSH STREET Valley Crest Homes from $399,990 mihomes.com/paradeTC 612-425-3688
US-169 to Canterbury Road; Go south to Mystic Lake Drive; Right on Thrush Street to model on left; In Google Maps enter “M/I Homes Valley Crest”
PARADE HOME $849,700





4 BED | 3.5 BATH
3,579 SQ FT
The Victoria features a gourmet kitchen, morning room with stunning views, a flex room, light- lled loft, owner’s suite with walk-in shower, bedroom-level laundry, and a fully nished lower level.
SHAKOPEE
3850 THRUSH STREET
Valley Crest Homes from $399,990
mihomes.com/paradeTC



612-425-3688
US-169 to Canterbury Road; Go south to Mystic Lake Drive; Right on Thrush Street to model on left; In Google Maps enter “M/I Homes Valley Crest”


STARTING AT $642,977
PARADE HOME $699,900
5 BED | 4 BATH
3,746 SQ FT

The Madison model has an upper loft together with four bedrooms! The great room shines with floor-to-ceiling windows, stone replace and built-in cabinets. Don’t miss the nished lower level!

SHAKOPEE
2039 BROOKVIEW STREET
Whispering Waters
Homes from $635,565
onetentenhomes.com






952-292-6924 | 651-503-6348
County Road 18 to Eagle Creek Boulevard; West to Foothill Trail; Left (north) to Brookview Street; Right to home on the left



STARTING


















$741,400 PARADE HOME $851,400
6 BED | 4.75 BATH
4,631 SQ FT
Our popular Bradford floor plan combines comfort and sophistication in this two-story home with six bedrooms, ve bathrooms, and 4,631 nished square feet. Included are a main-level flex room, family room with replace, mudroom with built-in bench, and a spacious kitchen! Enjoy the upper-level o ce and laundry room, connected directly to the impressive owner’s suite! Take advantage of the Jack-andJill bathroom and ensuite bath in two of the kid’s bedrooms and an additional bathroom for a princess suite! A nished lower level o ers plenty of storage space, a game room, a recreational room, and a sixth bedroom!
SHAKOPEE

7667 WAVERLY AVENUE
Whispering Waters Homes from $539,900 keylandhomes.com


952-300-1980 | 952-240-3910
Eagle Creek Boulevard (County Road 16) to foothill trail; South to 20th Avenue; West to Brookview Street; West on Waverly Avenue
STARTING AT $749,900 PARADE HOME $819,900



5 BED | 5 BATH 4,026 SQ FT
This plan is thoughtfully designed with impressive spaces! From the moment you walk in you will be delighted with the quality of nishes and unique touches. Featuring ve BRs, ve BAs, and a loft!
SAVAGE
6525 - 157TH STREET
Hampshire Preserve Homes from $650,000
eternityhomesllc.com


651-460-3043
From County Road 27; East on 154th Street; South on Hampshire Avenue S.; East on 157th Street; Immediate right onto Edgewood Court



STARTING
$689,600 PARADE HOME $749,900
5 BED |

2.75 BATH
2,774 SQ FT

Built with quality craftsmanship and inspiring design, this signature-series home has 2,774 nished square feet, four bedrooms, three bathrooms, and room to grow! Enjoy the open-concept layout with a spacious kitchen, dining room, and living room along with a mudroom and flex room on the main floor! Appreciate the unmatched upper-level laundry room and amazing owner’s suite. Come see for yourself, and Dream it, Design it, Live it with Key Land Homes!
SAVAGE
8383 - 157TH STREET
Big Sky Estates
Homes from $516,100 keylandhomes.com

952-300-1980 | 952-240-3910
363
West to model home
PARADE HOME $1,045,000


4 BED | 3 BATH
2,472 SQ FT
Enjoy this modern luxury villa community of Eagleview brought to you by Custom One Homes! This community o ers distinctively designed one- and two-story slab-on-grade detached villas.

SAVAGE
7841 - 146TH TERRACE
Eagleview
customonehomesmn.com



651-274-1403 | 651-459-1972
I-35E to Highway 42; West to Highway 13; South to South Park Drive; East Hwy. 13 Frontage Rd.; South to Sumter Ave.; West to 145th St.; Follow into the community
PARADE HOME $457,990

3 BED | 2.5 BATH
2,102 SQ FT
Live your best life in our luxury townhomes with main-level living at its nest, featuring an open-concept kitchen, dinette and great room. Owner’s suite has a luxurious bathroom and oversized closet. The upper level is ideal for today’s modern living with spacious second bedroom, full bath, home o ce space and flex room which can make an ideal home gym or third bedroom. The large loft area lends itself perfectly to your dreams of game room, home theater, teen space and more. These homes include the luxury nishes you have been looking for - quartz kitchen and bathroom countertops, stainless steel appliances, LVP flooring, and designer-selected interior nishes.
SAVAGE 6585 - 141ST TERRACE
Homes from $419,990
brandlanderson.com
612-326-3507 | 952-898-0230
Take County Road 42/Egan Drive to Loftus Lane; Go north to 141st Street W.; West to model home

STARTING AT $1,395,000 PARADE HOME $1,295,000




4-BR, 4-BA Pamela Park exclusive! Reserve your chance to gain entry to this highly sought-after community. Phase 2 of this project builds on the rst along with other recent neighborhood development activity. Enjoy the close proximity to the best restaurants, retail, and lifestyle amenities as well as convenient commutes to all the Edina area has to o er including the MSP International Airport, the Galleria, 50th & France, Centennial Lakes, and Southdale Mall.

READY-TO-BUILD LOCATION:
EDINA
4222 VALLEY VIEW ROAD
Homes from $1,495,000
4230homes.com
952-314-9434 | 952-236-1802
VISIT


PARADE HOME $2,250,000
5 BED | 4.25 BATH
4,900 SQ FT
This exceptionally crafted home is designed with a focus on function and flow. It makes a statement as soon as you open the doors with its modern style and classic, comfortable twist. The two-story home features a luxury primary suite with a closet connecting to the laundry. You can also nd a relaxing loft area, en suite, and a Jack-and-Jill with private vanities upstairs. On the main level, enjoy an open-concept gourmet kitchen, family and dining room with a walk-in pantry, and grill patio. The nished lower level is perfect for entertaining with a wet bar and game area. All Bellin Construction homes focus on superior craftsmanship and upgraded materials.
EDINA
5600 OAKLAWN AVENUE
bellinconstruction.com 763-221-5698

MN-100 to Vernon Ave. S.; East on W. 50th Street to Wooddale Avenue; Right/south to W. 56th Street; Left/east to Oaklawn Avenue; Right to home on the right

 Featured Tile: Lalique, Hampton Carrara Cardine, and Calacata Evora tileshop.com
Featured Tile: Lalique, Hampton Carrara Cardine, and Calacata Evora tileshop.com























